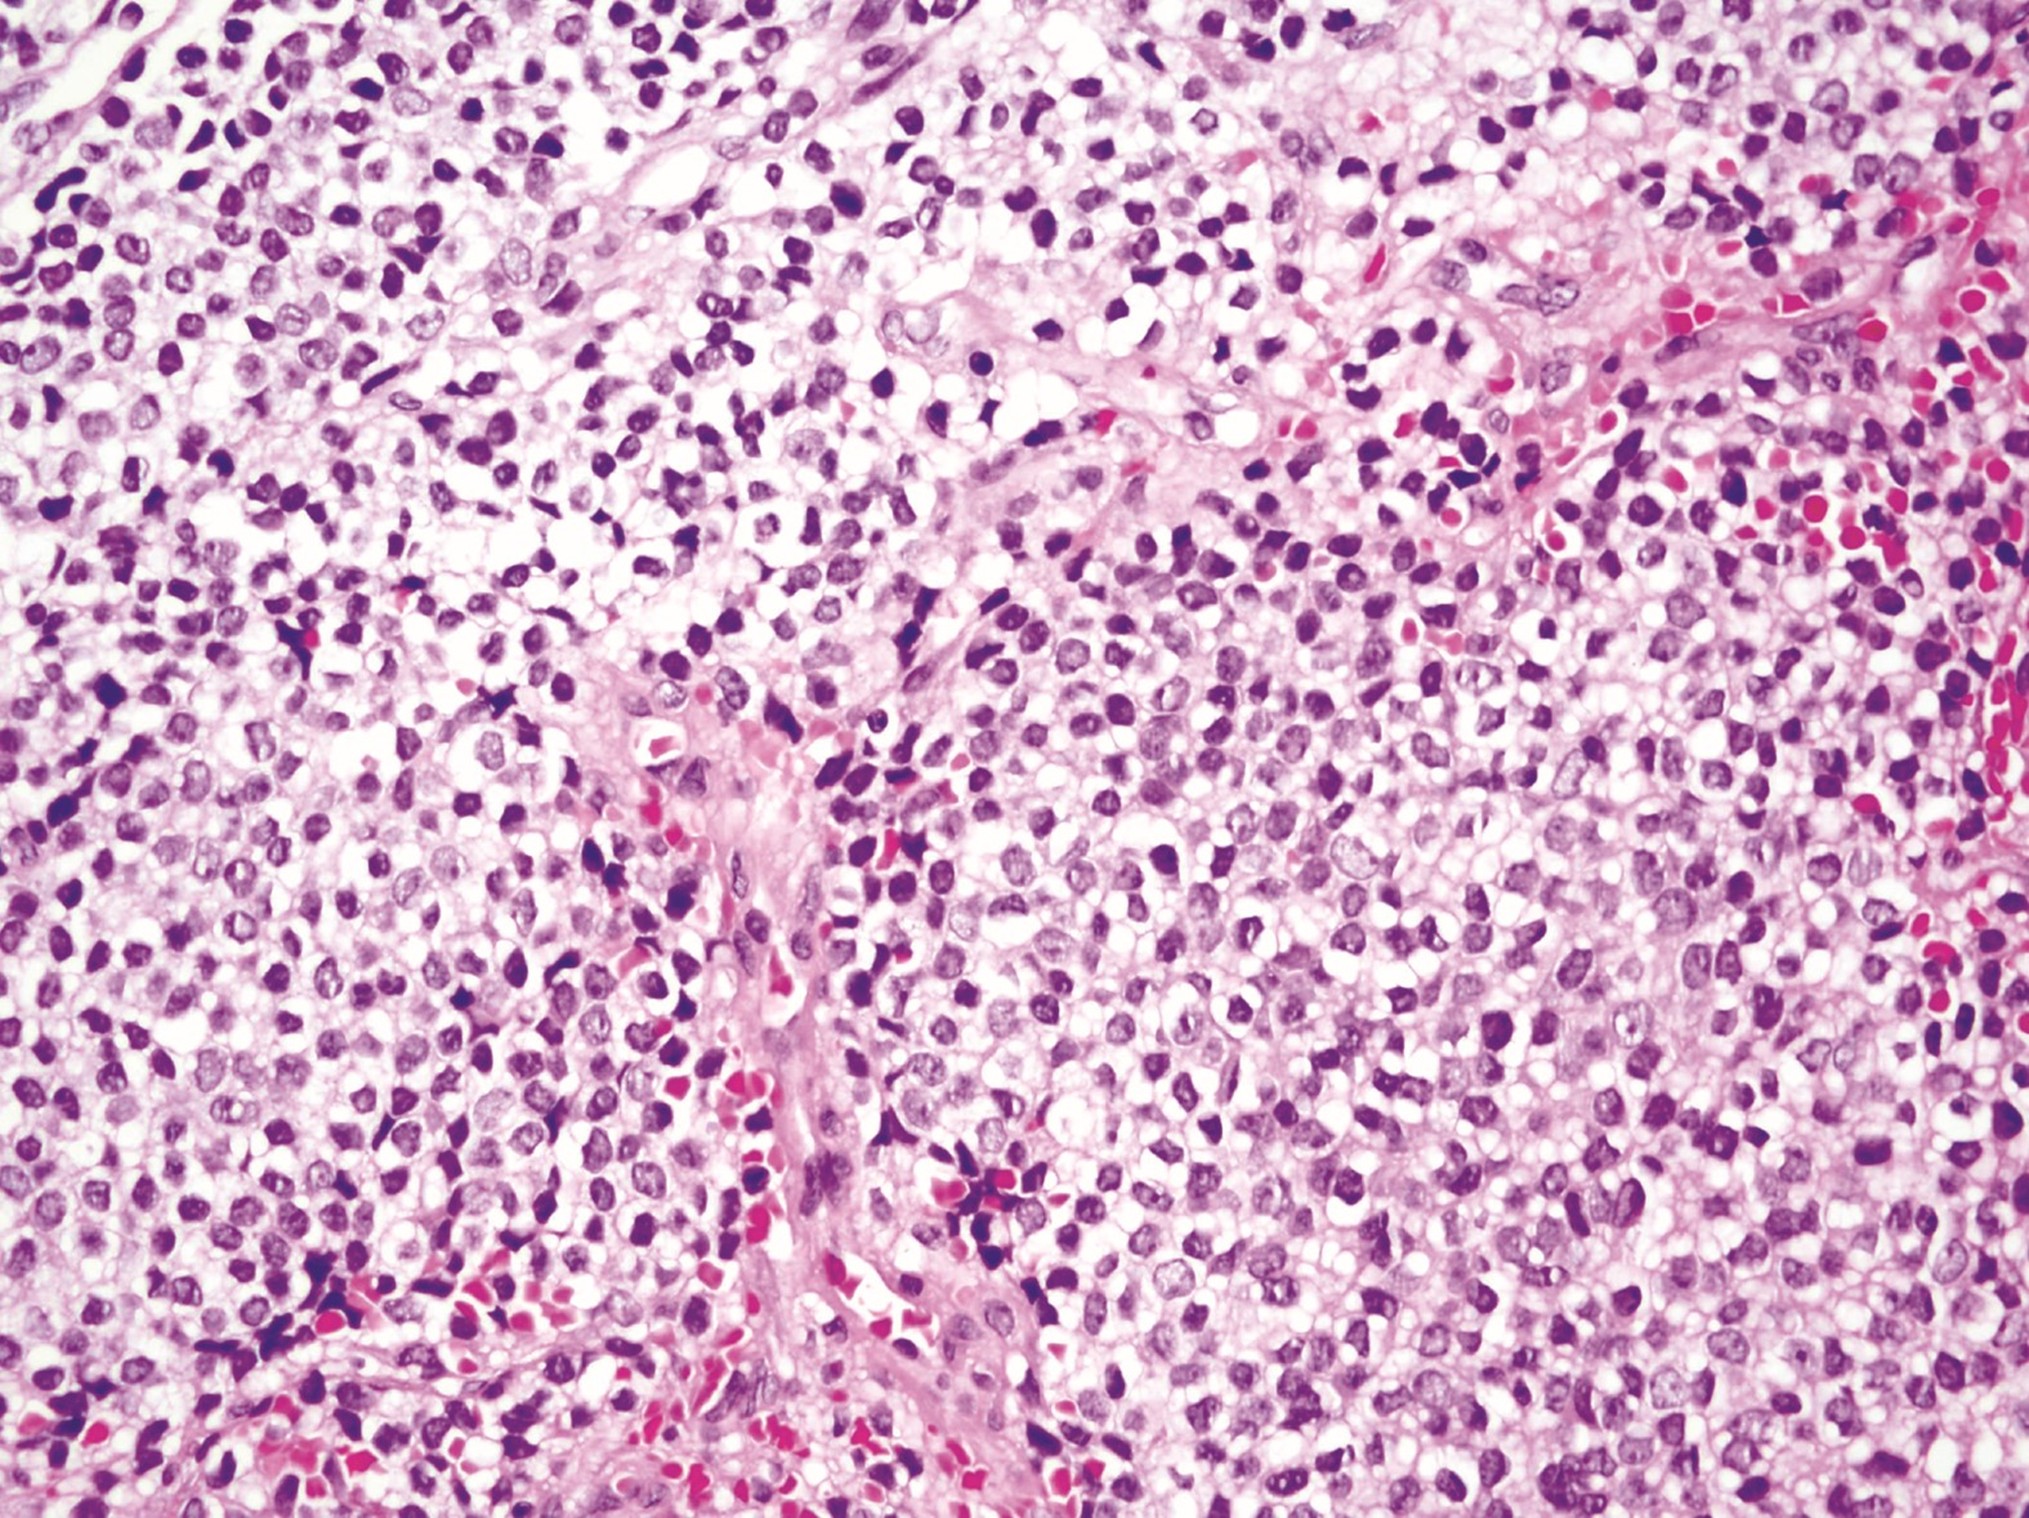

Vie, 17/10/2025 - 11:34 | dircom6
La US participa en un proyecto europeo sobre la evolución de la democracia en el trabajo en Europa
El estudio analiza medio siglo de transformaciones laborales en Alemania, España, Italia y Portugal en los sectores ferroviario y energético

Jue, 16/10/2025 - 11:30 | dircom7
164 investigadores de la US se sitúan entre los más influyentes del mundo
Son los resultados del ranking que cada año elabora la Universidad de Stanford (EEUU) y que en esta edición incluye casi un 15% más de representantes de la US

Mié, 15/10/2025 - 12:18 | dircom9
Investigadores de la US participan en el Congreso Nacional de Pediatría para abordar los retos de la salud infantil
Del 16 al 18 de octubre, docentes e investigadores de la Universidad de Sevilla tratarán cuestiones como los riesgos del uso temprano de las redes sociales, la pediatría en contextos de vulnerabilidad y el uso de complementos dietéticos en adolescentes

Mar, 14/10/2025 - 10:34 | dircom7
El Tokamak SMART de la US consigue el premio #EuropaSeSiente del Ministerio de Hacienda
Los ganadores se han elegido por voto popular a través de la web del concurso, que reconoce a proyectos financiados con fondos europeos

Jue, 09/10/2025 - 09:17 | dircom7
Localizan las zonas cerebrales más afectadas en la fase inicial de pacientes con trastornos del espectro de la esquizofrenia
Estos avances podrían contribuir a localizar biomarcadores y desarrollar estrategias terapéuticas personalizadas para combatir esta patología

Mié, 08/10/2025 - 12:49 | dircom9
Analizan la crisis de la vivienda en el sur de España con el proyecto Viviendigna
Los resultados del estudio se mostrarán en un visor cartográfico online, un atlas de vulnerabilidad, actividades de transferencia, divulgación y un cortometraje documental

Mié, 08/10/2025 - 11:34 | dircom7
El Tokamak SMART de la US aspira al premio #EuropaSeSiente del Ministerio de Hacienda
Los ganadores se elegirán por voto popular a través de la web del concurso, que reconoce a proyectos financiados con fondos europeos
Jue, 02/10/2025 - 11:44 | dircom2
Un estudio internacional confirma la eficacia de la terapia cognitivo-conductual en diversos trastornos mentales
La investigadora de la US, Emma Motrico, ha participado en el estudio que observa efectos terapéuticos potentes en trastornos como la depresión, la ansiedad, la bulimia, el estrés postraumático o las fobias

Mié, 01/10/2025 - 14:01 | dircom9
El proyecto REXASI-PRO culmina en Roma con avances en IA para sillas de ruedas autónomas
Con una financiación de 3,55 millones de euros, REXASI-PRO tiene como objetivo el desarrollo de sillas de rueda autónomas y fiables, destinadas a mejorar la calidad de vida de personas con movilidad reducida
Mié, 01/10/2025 - 13:07 | adminUS
Investigadores de la US participan en las 89 grandes preguntas abiertas de la Paleontología
Expertos internacionales buscan establecer una hoja de ruta clara para el futuro y el desarrollo de este campo científico y de conocimiento, marcando prioridades para la investigación, financiación y cooperación

Mar, 30/09/2025 - 13:23 | dircom7
Una nueva técnica agilizará el diseño de fármacos dirigidos a proteínas implicadas en multitud de enfermedades
Desarrollada con la participación del IIQ-CSIC-US, la técnica permite analizar la interacción entre fármaco y proteína sobre células vivas, en condiciones similares a las del interior del organismo

Lun, 29/09/2025 - 13:35 | dircom2
Un estudio en el Guadalquivir revela concentraciones más altas de metales pesados en el área de vertido de la mina Cobre Las Cruces
La investigación, realizada por la Universidad de Sevilla, mide los niveles actuales de metales en el sedimento antes de la puesta en marcha de los nuevos proyectos mineros, lo que permitirá evaluar futuros impactos

Lun, 29/09/2025 - 07:53 | dircom7
El Premio Nacional de Investigación 2025 reconoce a dos investigadores de la US
Andrés Aguilera, investigador en Cabimer y el Departamento de Genética de la US, y Jesús Campos Manzano, del Instituto de Investigaciones Químicas, han sido reconocidos con estos galardones

Jue, 25/09/2025 - 12:11 | dircom2
Investigadores de la US descubren un mecanismo clave para proteger el material genético en la reproducción
El estudio destaca la importancia de los sistemas de reparación del ADN en la fertilidad y el desarrollo saludable, y podría abrir el camino a nuevas investigaciones sobre trastornos reproductivos en humanos
Mié, 24/09/2025 - 12:20 | dircom9
La Noche Europea de l@s Investigador@s ofrece cien actividades gratuitas para todos los públicos
La US propone treinta actividades de divulgación científica, que se celebran en diversos emplazamientos, entre los que se incluyen los jardines del Rectorado, el Pabellón de Uruguay, la Fundación Madariaga y la Casa de la Ciencia

Mié, 17/09/2025 - 13:46 | dircom2
Un estudio de la US revela que los prejuicios sociales obstaculizan el emprendimiento femenino
La investigación determina que los hombres tienen una mayor probabilidad de materializar sus proyectos de negocio que las mujeres
Mar, 16/09/2025 - 11:20 | dircom7
La sequía modifica la competencia entre claveles silvestres
Un trabajo liderado por científicos de la Universidad de Sevilla revela cómo la disponibilidad de agua y ciertos rasgos de las hojas determinan el éxito competitivo entre plantas con diferente número de cromosomas

Mar, 16/09/2025 - 10:53 | dircom9
El turismo creativo en la frontera hispano-portuguesa impulsa la fidelización de visitantes
Un estudio de la Universidad de Sevilla y la Universidad de Córdoba revela cómo las experiencias turísticas creativas, basadas en el patrimonio cultural compartido, fortalecen la intención de los visitantes de volver a destinos periféricos transfronterizos

Lun, 15/09/2025 - 11:47 | dircom6
La información provista por el CNA, clave en el proceso de restauración de la Macarena
El centro ha realizado estudios de imagen y aportado información fundamental, reafirmando su compromiso con la sociedad y el patrimonio histórico.

Lun, 15/09/2025 - 11:07 | dircom7
Logran digitalizar en 3D la morfología y el arte rupestre de la Cueva de La Pileta
Investigadores de la Universidad de Sevilla han conseguido recrear este referente del arte rupestre gracias a la tecnología LiDAR de un smartphone y a un escáner láser

Vie, 12/09/2025 - 11:07 | dircom9
Desarrollan nuevos compuestos naturales con alto potencial fotoprotector frente a la radiación solar
Investigadores de la Universidad de Sevilla han descubierto las propiedades fotoprotectoras de dos nuevos compuestos, con potencial aplicación en cremas solares cuyo uso sería seguro para el medio ambiente

Vie, 12/09/2025 - 10:15 | dircom7
Un manual ofrece técnicas de Primeros Auxilios Psicológicos
Investigadores de la Universidad de Sevilla participan en un proyecto europeo cuyo objetivo es transformar el apoyo a la salud mental juvenil a través de la innovación y la colaboración

Jue, 11/09/2025 - 11:03 | dircom9
Investigadores de la US reciben el premio al mejor artículo en la conferencia internacional sobre pensamiento computacional y variabilidad
Investigadores de la US reciben el premio al mejor artículo en la 29th ACM International Systems and Software Product Line Conference (SPLC 2025)

Jue, 11/09/2025 - 10:44 | dircom7
La US reconoce a cinco de sus investigadores con los Premios Fama 2024-25
Estos galardones premian cada año la trayectoria investigadora y de transferencia de conocimiento de excelencia del PDI de la Universidad de Sevilla

Jue, 11/09/2025 - 09:32 | dircom9
Revelan factores potencialmente clave en la resistencia al daño de las células cancerosas
Un equipo de la Universidad de Sevilla, con participación del CBM (CSIC-UAM), ha identificado factores que amenazan la supervivencia celular cuando fallan los mecanismos de vigilancia, como ocurre en los tumores

Mar, 09/09/2025 - 10:48 | dircom9
Una investigación de la US sobre el uranio, portada en la revista de la Sociedad Americana de Química
Un estudio teórico sobre el comportamiento del uranio en disolución, publicado por el grupo de investigación Fisioquimica de Medios Condensados, ha sido publicado en la revista Inorganic Chemistry y considerado como uno de los artículos del año de la especialidad

Jue, 04/09/2025 - 13:03 | dircom6
La Universidad de Sevilla te ayuda a dejar de fumar con un programa gratuito de apoyo psicológico
El tratamiento tiene lugar en la Facultad de Psicología de la US

Jue, 04/09/2025 - 09:46 | dircom9
Exploran las características de las bacterias multirresistentes en las aguas residuales y su correlación con la prescripción antibiótica
Un estudio en el que colabora el departamento de Microbiología de la Facultad de Medicina de la US analiza y cuantifica las bacterias resistentes a los antibióticos en las aguas residuales de depuradoras de la ciudad de Sevilla
Mié, 27/08/2025 - 10:01 | dircom9
Un estudio del IBiS desvela un nuevo mecanismo de sensibilidad del sarcoma de Ewing a la quimioterapia
La investigación, publicada en la revista Oncogene, muestra cómo una interacción molecular específica determina la eficacia del irinotecán en este tipo de tumor pediátrico

Lun, 25/08/2025 - 10:11 | dircom9
La US acoge el mayor encuentro nacional e iberoamericano sobre comportamiento animal
Del 2 al 5 de septiembre, la Facultad de Biología será sede del XIX Congreso Nacional y XV Iberoamericano de Etología y Ecología Evolutiva en el que participarán destacados expertos internacionales, como Tim Clutton-Brock (Cambridge) y David W. Macdonald (Oxford)

Mié, 20/08/2025 - 09:37 | dircom9
¿Por qué los neandertales iban a la playa?
Un estudio en el que participa la Universidad de Sevilla revela las primeras huellas de neandertales de adultos, niños y aves en el sur de Portugal, un descubrimiento que sugiere planificación de rutas, posible comportamiento de caza y coexistencia con otras especies

Jue, 14/08/2025 - 11:05 | dircom2
Un experto de la US atribuye la causa de los incendios intensos y de múltiples focos al cambio climático
Emerge un nuevo tipo de incendios de sexta generación que no se pueden apagar y el único camino para acabar con ellos es la prevención

Jue, 07/08/2025 - 09:48 | dircom7
La actividad física protege regiones cerebrales vulnerables y ayuda a frenar el deterioro cognitivo en la enfermedad de Parkinson
Esta investigación del IBiS podría impulsar la incorporación sistemática de programas de ejercicio físico en el tratamiento integral de la enfermedad de Parkinson y favorecer el desarrollo de estrategias más eficaces haciendo uso de la neuroimagen como herramienta clave para monitorizar los efectos del ejercicio sobre el cerebro

Mié, 06/08/2025 - 10:51 | dircom7
El proyecto U5-Space avanza hacia la consecución de aeronaves propulsadas por hidrógeno verde
Investigadores de la US alcanzan un hito en la movilidad aérea urbana con la integración de una pila de combustible de hidrógeno en una aeronave no tripulada

Vie, 01/08/2025 - 10:44 | dircom7
Demuestran que el modelo EFQM permite anticipar resultados y mejorar la gestión del conocimiento en las organizaciones
Según esta investigación, gracias a esta herramienta los directivos pueden tomar decisiones estratégicas con menor incertidumbre, al conocer con antelación el impacto que tendrán sobre sus principales grupos de interés

Jue, 31/07/2025 - 12:43 | dircom7
Sevilla celebra la Noche Europea de l@s Investigador@s con más de 120 actividades
La divulgación científica será la protagonista en Sevilla el próximo 26 de septiembre, con diez entidades participantes y varios centros neurálgicos de actividades: la Casa de la Ciencia de Sevilla, Caixaforum Sevilla, el Pabellón de Uruguay y la Fundación Valentín de Madariaga, entre otros

Jue, 31/07/2025 - 09:34 | dircom7
US, UPO y Virgen del Rocío se alían en un proyecto de inteligencia artificial y computación frente al cáncer
El objetivo es identificar biomarcadores prometedores en cánceres complejos como los sarcomas que permitan aplicar tratamientos más eficaces y personalizados

Mar, 29/07/2025 - 11:13 | dircom7
Detectan microplásticos en la coquina de fango en los estuarios del Guadiana y el Guadalquivir
La investigación también destaca que hay más cantidad de microplásticos en los ejemplares más pequeños
Lun, 28/07/2025 - 11:01 | dircom7
El profesor Antonio Ventosa Inaugura el Congreso FEMS 2025
La cita, que en esta última edición ha reunido en Milán a más de 2000 participantes, se encuentra entre las más relevantes a nivel internacional

Jue, 24/07/2025 - 12:41 | adminUS
La investigadora Isabel Herrera expone 'Pensive Trails' en Reino Unido
Doctoranda en Arte y Patrimonio de la Universidad de Sevilla, comparte proyecto artístico con la china Fen Ye, del Instituto de Bellas Artes de Hubei

Vie, 18/07/2025 - 09:49 | dircom7
Las flores verdes necesitan el amarillo para destacar en su entorno y sobrevivir
Un estudio de la US y la UPO señala cómo estas flores se adaptan y consiguen atraer a insectos polinizadores

Mié, 16/07/2025 - 09:33 | dircom6
Una nueva plataforma acerca los cálculos de Física Nuclear a usuarios no expertos
La herramienta Theo4Exp, desarrollada dentro del proyecto europeo EUROLABS, permite realizar cálculos avanzados de física nuclear sin necesidad de conocimientos de programación

Mar, 15/07/2025 - 11:16 | dircom2
Investigadores de la US proponen crear un microsantuario internacional para proteger al delfín común en peligro de extinción
Evitar aproximaciones intencionadas al avistar delfines, establecer buenas prácticas y zonas de navegación regulada, así como señalizar las áreas más sensibles son algunas de las medidas efectivas de conservación de esta especie

Lun, 14/07/2025 - 11:39 | dircom7
Un profesor de la US consigue una ERC Proof of Concept Grant
Su proyecto aspira a optimizar la producción de plantas solares comerciales mediante algoritmos de Control Predictivo por Modelos Cooperativos con Múltiples Escenarios
Mié, 02/07/2025 - 18:01 | dircom6
HASER, primera revista de Filosofía en España y la primera del mundo en 'Filosofía para Niños' y 'Filosofía Aplicada'
La revista, de periodicidad anual, reúne a investigadores de primer nivel nacionales e internacionales

Vie, 27/06/2025 - 13:42 | dircom7
La US licita más de tres millones de euros en equipos especializados para consolidar su liderazgo en movilidad aérea no tripulada
El proceso se enmarca en la consolidación del Centro de Innovación en Vehículos Aéreos No Tripulados y Movilidad Aérea Urbana (CUAM)

Vie, 27/06/2025 - 11:44 | dircom7
Dos nominadas de la US en los premios Archiletras
Blanca Garrido y Ana María Romera compiten en las categorías de Investigación y Libro del año, respectivamente

Jue, 26/06/2025 - 13:10 | dircom2
Éxito de audiencia para la Física de la Universidad de Sevilla
Más de un millón de espectadores vieron la intervención del profesor José María Martín Olalla en el programa 'La Revuelta', con David Broncano

Jue, 26/06/2025 - 11:50 | dircom7
¿Puede sustituir la IA a la Guardia Civil de Tráfico?
Investigadores de la Universidad de Sevilla analizan cuáles son las estrategias óptimas para reducir la siniestralidad en las carreteras y controlar el cumplimiento de la normativa de tráfico desarrolladas por la Agrupación de Tráfico de la Guardia Civil

Mié, 25/06/2025 - 14:05 | dircom2
Un nuevo estudio alerta de una grave contaminación desde la Mina de Aznalcóllar al río Guadiamar y a Doñana
Advierte del peligro de bañarse en el río Agrio, que ha sufrido una alta mortandad de peces y ha visto cómo sus aguas se han teñido de turquesa por la elevada concentración de metales tóxicos

Mié, 25/06/2025 - 12:38 | dircom6
Un estudio europeo para adaptar prácticas agrícolas sostenibles que refuercen la seguridad alimentaria en África
El proyecto europeo NEEMA, liderado por la Universidad de Sevilla, acaba de ver reforzada su iniciativa con la publicación de un artículo en Springer Nature
Mié, 25/06/2025 - 12:27 | dircom2
Un estudio de la Universidad de Sevilla revela que subir el precio del agua no ayuda a ahorrar
Un modelo predictivo ayuda a las ciudades a fomentar el ahorro de agua con tecnología y hábitos sostenibles

Lun, 23/06/2025 - 13:37 | dircom7
Cuatro investigadores andaluces recogen los XIII Premios Manuel Losada Villasante
Jesús Campos Manzano (Investigación Científica), María del Rocío López Igual (Investigación en Innovación), Rocío Ríos Reina (Investigación Agroalimentaria) y José Raúl Aguilera Velázquez (Investigación en Economía Circular) han recibido sus galardones en un acto celebrado en la Fundación Cajasol
Lun, 23/06/2025 - 12:43 | dircom6
El orujo del tomate fermentado optimiza la salud de los corderos
El Grupo Operativo TOMATHO, con participación de la US, presenta una alternativa económica y sostenible para la alimentación del ganado

Vie, 20/06/2025 - 10:54 | adminUS
Investigadores de Huelva y Sevilla impulsan un proyecto pionero de regeneración urbana para afrontar terremotos y tsunamis
La iniciativa se plantea como un proyecto piloto enfocado en la mejora del Plan de Acción para el parque de vivienda social de Isla Cristina

Mié, 18/06/2025 - 13:35 | adminUS
Puesta en marcha de la Red de Excelencia P+GARANT[IA]
La Universidad de Sevilla lidera una nueva Red de Excelencia para mejorar la atención a la infancia, adolescencia y familia

Mié, 18/06/2025 - 11:20 | adminUS
La US recibe a los mejores expertos mundiales en la evaluación de la calidad de la Educación Infantil
Investigadores de 14 países se reúnen en Sevilla para debatir sobre la calidad de la educación infantil y su impacto en el desarrollo infantil

Mar, 17/06/2025 - 11:57 | dircom7
Un estudio de la Universidad de Sevilla resuelve un problema de 120 años y corrige una idea de Einstein
El trabajo defiende que el tercer principio de la termodinámica sería una consecuencia del segundo principio y no una idea independiente
Lun, 16/06/2025 - 12:00 | dircom2
La US y el SAS crean una app para promover la salud mental en el embarazo y posparto
La aplicación, basada en la evidencia científica, forma parte de un proyecto de investigación y pretende integrar la innovación digital en los servicios públicos de salud

Vie, 13/06/2025 - 11:40 | dircom7
La US se integra en la primera red española para impulsar la investigación en criobiología
SecrioNet nace con el objetivo de potenciar la cooperación entre en materia de criopreservación entre representantes de distintas instituciones de investigación

Mié, 11/06/2025 - 14:29 | dircom7
Los XIII Premios Manuel Losada Villasante reconocen la labor de cuatro investigadores andaluces
Los jurados se han reunido este miércoles 11 de junio en el Rectorado de la Universidad de Sevilla

Mié, 11/06/2025 - 10:18 | dircom9
“El mejor fotoprotector es no exponerse al sol”
El proyecto FarmaSoludable de la Universidad de Sevilla propone un cambio de hábitos en la protección solar y subraya el papel estratégico de las farmacias comunitarias
Mié, 04/06/2025 - 14:02 | dircom2
La US elabora una guía de la FAO para acabar con la brecha de género en la lucha contra el hambre
Dos profesores, Adriana Fillol y Miguel Ángel Martín, han confeccionado para la Organización de las Naciones Unidas para la Alimentación y la Agricultura, herramientas legislativas dirigidas a los parlamentarios de América Latina, el Caribe y la Península Ibérica, para impulsar sistemas agroalimentarios más inclusivos, equitativos y sostenibles
Mié, 04/06/2025 - 12:20 | adminUS
Oxford acoge la presentación del monográfico The History of the Physiologus in Early Medieval England
En el acto participó la profesora Mercedes Salvador Bello, autora del monográfico, adscrita al Departamento de Literatura Inglesa y Norteamericana de la Universidad de Sevilla

Mié, 04/06/2025 - 10:51 | dircom7
El cambio climático y las interacciones entre especies modifican la distribución del oso pardo en Europa
Las relaciones tróficas son clave para entender los cambios en la distribución de ciertas especies, según un estudio liderado por la US en el que participan expertos de 26 países

Vie, 30/05/2025 - 11:35 | dircom9
Descubren cómo la actividad neandertal favoreció la formación de un raro mineral en la Cueva del Ángel (Lucena, Córdoba)
La investigación también ha permitido conocer que los neandertales eran unos hábiles cazadores de grandes animales y diestros fabricantes de útiles líticos

Jue, 29/05/2025 - 11:28 | dircom7
Una investigación del IBiS identifica una nueva diana para el tratamiento del Alzheimer
La identificación de una nueva diana terapéutica puede llevar a la utilización de fármacos ya aprobados para otras patologías en ensayos en animales y, si efectivos, a los pacientes

Mié, 28/05/2025 - 09:32 | dircom7
Un sistema pionero que revoluciona el diagnóstico de enfermedades raras
Este hito abre la puerta a una nueva era en el diagnóstico de enfermedades raras y la personalización de tratamientos

Mar, 27/05/2025 - 11:27 | dircom9
Las zonas más calurosas de Sevilla se concentran en barriadas vulnerables
Un estudio de la Universidad de Sevilla concluye que las áreas más cálidas dentro de la ciudad son periferias rodeadas de infraestructuras y polígonos residenciales del siglo XX, donde suele vivir población vulnerable en edificios envejecidos y con bajo rendimiento energético

Mar, 27/05/2025 - 08:28 | dircom7
La CRUE convoca la V edición del concurso #HiloTesis
Las personas participantes deberán haber superado satisfactoriamente al menos una evaluación del Documento de Actividades y Plan de Investigación (RAPI) o que hayan defendido su Tesis Doctoral en los 12 meses anteriores a la fecha de inicio del concurso
Lun, 26/05/2025 - 11:48 | dircom2
Un informe reclama frenar la segregación de la población migrante en Andalucía
El VI Informe del Observatorio de Desigualdad de Andalucía ha sido contado con la participación de la Universidad de Sevilla

Jue, 22/05/2025 - 11:48 | dircom7
Desarrollan en el IBiS el primer ratón modelo de una grave enfermedad neurodegenerativa un siglo después de su descubrimiento
El estudio revela mecanismos moleculares en la enfermedad rara denominada lipofuscinosis neuronal ceroidea del adulto y abre nuevas vías para el desarrollo de terapias.

Mié, 21/05/2025 - 12:43 | dircom7
La US, reconocida como ‘Innovador Clave’ en un proyecto europeo pionero de almacenamiento energético
La Comisión Europea reconoce la labor de la US por su aportación al proyecto PUSH-CCC
Jue, 15/05/2025 - 12:51 | dircom7
INDICATE recibe el Premio de Sostenibilidad en los X Premios de Construcción Sostenible de Castilla y León
El objetivo de INDICATE es establecer una línea base de referencia sobre las emisiones actuales de carbono de ciclo de vida de los edificios en España

Mié, 14/05/2025 - 10:43 | adminUS
El malestar emocional entre los jóvenes crece hasta el 38,5% entre 2018 y 2022
El estudio HBSC, dirigido por los investigadores Mª Carmen Moreno y Francisco J. Rivera, analiza la salud adolescente en áreas como bienestar, alimentación, ejercicio físico, consumo de drogas, sexualidad y entornos sociales

Mar, 13/05/2025 - 13:49 | dircom7
La Alhambra en la Bienal de Arquitectura de Venecia 2025
Un investigador de la Universidad de Sevilla es uno de los autores de esta propuesta sobre la concepción visual y espacial del monumento nazarí
Jue, 08/05/2025 - 11:23 | adminUS
La US se une al proyecto europeo READy para mejorar la enseñanza de la lectoescritura en primaria
El grupo de investigación LABDICOLE pasa a contribuir a la iniciativa financiada por Erasmus+

Lun, 05/05/2025 - 11:28 | dircom7
El Tokamak SMART de la US aspira a ser el proyecto más transformador para Andalucía en 2025
Este proyecto, cuyo objetivo es alcanzar la energía de fusión, es uno de los candidatos seleccionados por la Dirección General de Fondos Europeos de la Junta de Andalucía

Vie, 02/05/2025 - 12:15 | dircom7
El papel decisivo de las redes sociales en la percepción de las Marcas Premium de la distribución alimentaria
Deluxe (Lidl) lidera la percepción de calidad entre las marcas privadas premium, mientras Carrefour Selección y Delicious (DIA) enfrentan importantes desafíos de imagen
Lun, 28/04/2025 - 11:13 | dircom2
Identifican una molécula antiviral eficaz contra infecciones que carecen de tratamiento
Una investigación liderada por el Instituto de Biomedicina de Sevilla con la colaboración de la University of Texas Medical Branch (UTMB, Texas, USA), pone de manifiesto la eficacia y seguridad de una nueva molécula antiviral de amplio espectro, un hallazgo crucial en un contexto de falta de alternativas terapéuticas para la gran mayoría de infecciones causadas por virus

Jue, 24/04/2025 - 11:19 | dircom7
La escasa relación genética entre las distintas poblaciones de origen fenicio del Mediterráneo
El análisis de diversas muestras de ADN antiguo desafía las creencias arraigadas sobre esta civilización y descarta una migración masiva para justificar su expansión, apuntando hacia un proceso dinámico de asimilación cultural

Jue, 24/04/2025 - 08:38 | dircom7
Un gran cementerio ocupaba la Mezquita-Catedral de Córdoba en el siglo XVIII
Dos investigadores de la US y la UCO identifican más de mil sepulturas en un plano del monumento de 1741

Mié, 23/04/2025 - 12:14 | adminUS
El retablo de la Anunciación, protagonista de un estudio de innovación en la digitalización del patrimonio
La investigación introduce una nueva herramienta conceptual para optimizar la clasificación y el intercambio de datos dentro de modelos HBIM

Mar, 22/04/2025 - 10:16 | dircom9
La Universidad de Sevilla lleva el conocimiento de sus facultades a la Feria de la Ciencia
Varios centros muestran a los asistentes sus últimos avances científicos y los técnicos de Ulysseus y el Secretariado de Divulgación Científica y Cultural ofrecen información a los asistentes durante toda la Feria

Lun, 21/04/2025 - 15:31 | dircom7
Un estudio de la US revela nuevas pistas para frenar daños en el ADN
Investigadores de la US en CABIMER describen cómo Patulina y Xestoquinol inhibien el metabolismo del ADN y podrían abrir nuevas vías en el estudio y tratamiento del cáncer

Mié, 16/04/2025 - 11:22 | dircom9
Una cámara avanzada en Calar Alto para desvelar los secretos de las nubes de Venus
El nuevo instrumento, capaz de tomar hasta 600 imágenes por segundo, abre una ventana al infrarrojo cercano para el telescopio de 1,23 m y se podrá utilizar para estudiar otros planetas y satélites del Sistema Solar, así como exoplanetas y fuentes extragalácticas

Jue, 10/04/2025 - 09:59 | dircom7
Un estudio demanda una mayor coordinación entre el BCE y las políticas fiscales nacionales
El trabajo demuestra que la Eurozona sigue siendo una unión económica fragmentada y asegura que mientras que los países del centro prosperan con estabilidad monetaria, los países periféricos dependen de políticas fiscales más activas

Mié, 09/04/2025 - 11:10 | adminUS
El IMUS participa en la reunión anual de ERCOM celebrada en el Instituto Henri Poincaré de París
El instituto de investigación de la US ha contribuido al debate europeo sobre los retos y oportunidades actuales de la investigación matemática

Mar, 08/04/2025 - 15:05 | dircom6
Investigadores y representantes vecinales discuten sobre el sentido psicológico de comunidad en los barrios de Sevilla
El estudio parte de una amplia encuesta comunitaria en nueve barrios de Sevilla

Jue, 03/04/2025 - 12:02 | dircom7
La US recibe a medio centenar de nuevos investigadores gracias a programas de captación de talento
La Comisión Europea concede a la Universidad de Sevilla el sello de Excelencia en Recursos Humanos en Investigación (HRS4R), que pone en valor su compromiso con la captación y retención del talento

Vie, 28/03/2025 - 10:33 | dircom7
Un reloj inteligente para prevenir la osteoporosis a través del ejercicio físico
Investigadores de la US inician el proyecto WEAPOM en el que se usará un dispositivo weareable para medir la carga mecánica que recibe el esqueleto y su impacto en la salud ósea

Jue, 27/03/2025 - 11:21 | dircom7
El catedrático Carlos Bordons Alba nombrado Fellow del IEEE
Un total de 14 catedráticos de la Universidad de Sevilla han sido nombrados IEEE Fellow por sus contribuciones en áreas tecnológicas, lo que la sitúa como la universidad española con más miembros distinguidos por esta institución

Mar, 25/03/2025 - 13:07 | dircom7
Un estudio muestra la relación entre el inicio de la jornada laboral y las preferencias por el cambio de hora
Jorge Mira Pérez de la USC y José María Martín Olalla de la US han analizado las respuestas a la consulta pública organizada por la Comisión Europea en 2018 sobre el cambio de hora

Vie, 21/03/2025 - 11:32 | dircom7
Los XX Premios Tesis Doctoral del Centra reconocen una tesis leída en la US
La Universidad de Sevilla ha sido la institución que más candidaturas ha presentado a estos premios
Mié, 19/03/2025 - 14:46 | dircom2
Un estudio de la US analiza cómo hacer las ciudades más amigables con la bicicleta
Examina los factores que favorecen o dificultan el uso de la bicicleta en 60 ciudades de todo el mundo

Mié, 19/03/2025 - 10:50 | dircom7
Un estudio destaca la naturalidad del cambio estacional de hora y cuestiona los fundamentos de la crítica moderna a esta práctica
El estudio revisa el impacto del cambio estacional de hora en la salud humana considerando los efectos asociados con el cambio en sí y los relacionados con el periodo de vigencia de la hora de verano

Mar, 18/03/2025 - 08:08 | dircom9
Una investigación del Instituto de Biomedicina de Sevilla propone un tratamiento personalizado para el melanoma uveal
Este estudio del IBiS identifica los mecanismos genéticos que impulsan la progresión del melanoma uveal y propone un tratamiento basado en la inhibición de las proteínas HIF-2α y FAK

Vie, 14/03/2025 - 10:15 | dircom7
La US lidera un proyecto que ayudará a establecer la línea base de la huella de carbono de los edificios
El proyecto ofrece unos primeros resultados que pueden ser de ayuda para la futura implementación del indicador de potencial de calentamiento global en el nuevo Código Técnico de la Edificación
Jue, 13/03/2025 - 14:04 | dircom2
Un informe alerta que la apertura de nuevas minas comprometerá la disponibilidad de agua potable en Andalucía occidental
Para evitar el “colapso hídrico” propone declarar una moratoria hasta que se estudien en profundidad los efectos de la acumulación de contaminantes en las aguas, la agricultura, la pesca, el turismo, el medio ambiente y la salud humana

Mar, 11/03/2025 - 11:00 | dircom7
La US se suma a un proyecto de desarrollo de biocombustibles avanzados
Las universidades y empresas integrantes de BioCAs-CCU trabajan para obtener electro-Diesel o e-Diesel y combustibles sostenibles para aviación a partir de residuos e incorporando hidrógeno verde
Mar, 11/03/2025 - 09:34 | dircom2
La economía, el medioambiente y la guerra, las principales preocupaciones de los niños, niñas y adolescentes en España
La Universidad de Sevilla ha elaborado para UNICEF el cuarto Barómetro de Opinión de la Infancia y la Adolescencia en España, que se destaca que aumenta el bienestar emocional de los jóvenes y se mantiene la desafección política

Vie, 07/03/2025 - 08:56 | dircom2
La Universidad de Sevilla impulsa la igualdad de género en la prevención de riesgos laborales
El Laboratorio Observatorio de Salud Laboral desde la Perspectiva de Género en Andalucía ha publicado un libro, bajo la dirección de Lourdes Munduate, que aborda los retos de género en el ámbito laboral y presenta una herramienta para autoevaluar la integración de la perspectiva de género en la prevención de riesgos laborales

Jue, 06/03/2025 - 08:56 | dircom7
Puerta de la Carne: la reconstrucción de una joya arquitectónica
Tres investigadores de la Universidad de Sevilla presentan una recreación digital de esta obra singular y proponen su reconstrucción material
Mié, 05/03/2025 - 13:17 | adminUS
Publicado el 'Catálogo BIM-ZEN' para envolventes sostenibles en modelos BIM
Un grupo de investigación de la US publica los resultados de la investigación que se presenta como un recurso clave para la descarbonización del sector de la edificación

Lun, 03/03/2025 - 14:19 | dircom7
Cómo las plantas y animales construyen sus interacciones
En promedio, una planta individual recibe el 70% de la diversidad de animales que comen frutos en su comunidad y solo un porcentaje muy reducido de individuos desempeña un rol central en la red de interacciones

Jue, 27/02/2025 - 12:33 | dircom2
La US recibe financiación europea para cuatro proyectos de investigación de alto nivel
Hasta el momento se han captado más de 870.000 euros de la convocatoria Postdoctoral Fellowships 2024, perteneciente a las Acciones Marie Sklodowska-Curie

Mié, 26/02/2025 - 14:41 | dircom2
“El ordenador cuántico permitirá hacer trabajos inimaginables”
La Universidad de Sevilla congrega a expertos internacionales para conmemorar el centenario de la mecánica cuántica

Mié, 26/02/2025 - 11:58 | dircom9
Investigadores de la US lideran un nuevo lenguaje universal de variabilidad del software
El proyecto ha sido desarrollado durante más de 6 años en una colaboración con distintas universidades alemanas y austriacas

Mié, 26/02/2025 - 11:26 | dircom6
La US impulsa el debate sobre derechos fundamentales en procesos transfronterizos
El primer Transnational Awareness Raising Debate del proyecto EPHESUS reúne en Bucarest a expertos europeos para analizar alternativas a la Orden Europea de Detención y Entrega y su impacto en los derechos fundamentales

Mié, 26/02/2025 - 09:42 | dircom6
La US impulsa la cooperación judicial en Europa con el proyecto EUROProspects
Miembros del Departamento de Derecho Procesal y de Derecho Internacional Público participan en esta iniciativa, financiada por la Comisión Europea (Dirección General de Justicia y Consumidores), para mejorar la aplicación de la Decisión Marco 2008/947/JAI

Mar, 25/02/2025 - 10:13 | dircom7
La vacunación frente al SARS-CoV-2 disminuye el riesgo de mala evolución de la COVID-19 en receptores de trasplante de órgano sólido
Una investigación del Instituto de Biomedicina de Sevilla y el Hospital Universitario Virgen del Rocío comprueba que los pacientes trasplantados que habían sido previamente vacunados para la COVID-19 tenían un riego de fallecimiento significativamente inferior al de los pacientes trasplantados no vacunados

Lun, 24/02/2025 - 12:12 | dircom9
Una iniciativa pública de 3,9M€ reunirá a los mayores expertos de ELA para impulsar la investigación
El proyecto SEED-ALS incorpora 27 grupos de investigación de 13 comunidades autónomas, incluyendo todas las unidades de referencia nacionales y europeas en ELA

Mié, 19/02/2025 - 11:21 | dircom9
Cómo cerrar brechas de aprendizaje en estudiantes socioeconómicamente desfavorecidos
Una investigación de la Universidad de Sevilla muestra que los mensajes de texto a padres o madres para apoyar el aprendizaje de sus hijos parecen más eficaces que los meramente informativos
Mar, 18/02/2025 - 12:43 | dircom2
Abordan estrategias innovadoras para prevenir el estrés en la Semana Mundial del Cerebro
Está organizado por el Grupo de Investigación Neurociencia del Bienestar de la Universidad de Sevilla y tiene lugar en la Facultad de Psicología. Además, hay previstos actos en la Facultad de Medicina y en la de Biología

Vie, 14/02/2025 - 10:51 | dircom7
La US participa en un proyecto europeo para fortalecer la salud mental juvenil en Europa
El proyecto PACT, financiado por Erasmus+, empleará técnicas creativas y primeros auxilios psicológicos para apoyar a jóvenes en situación de vulnerabilidad
Mié, 12/02/2025 - 13:44 | adminUS
Realizado un estudio nacional sobre condición física y salud en la infancia
El trabajo de investigación ha estado liderado por equipos de la Universidad de Sevilla y la Universidad de Cádiz

Mié, 12/02/2025 - 12:40 | dircom9
La exposición 'La inmolación de las células' llega al emblemático espacio Los Claustros de Santo Domingo (Jerez)
La muestra es el resultado de la colaboración entre la Real Academia Sevillana de Ciencias (RASC) y la Facultad de Bellas Artes de la Universidad de Sevilla con el Museo Nacional de Ciencia y Tecnología

Mié, 12/02/2025 - 11:20 | dircom7
Nuevos factores implicados en el deterioro cognitivo y la demencia asociada al Parkinson
Los hallazgos de esta investigación del IBiS y del Hospital Universitario Virgen del Rocío podrían fomentar el uso de biomarcadores de neuroimagen para detectar precozmente a los pacientes con mayor riesgo de deterioro cognitivo y favorecer el desarrollo de tratamientos más eficaces desde las etapas iniciales de la enfermedad

Vie, 07/02/2025 - 09:44 | dircom7
Un nuevo fármaco a base de diterpenos logra la regeneración neuronal funcional tras una lesión cerebral
Este importante descubrimiento, publicado en la revista Stem Cell Research & Therapy, se centra en un tratamiento con diterpenos

Lun, 03/02/2025 - 13:10 | dircom6
La US y el Centro de Estudios Andaluces, aliados en el 27
La revista Andalucía en la Historia dedicará un dossier al centenario de la Generación del 27 junto con un especial por el IV Centenario de Góngora

Lun, 03/02/2025 - 12:57 | dircom7
Las indumentarias ceremoniales de la Edad del Cobre halladas en el Tholos de Montelirio
Un estudio liderado por la US describe diversos aspectos desconocidos hasta ahora de estas indumentarias y su importante significado

Vie, 31/01/2025 - 12:06 | dircom7
Una herramienta predictiva del rendimiento de los suelos para el cultivo del olivo
La empresa AGQ Labs desarrolla un proyecto de I+D+i, en colaboración con la Universidad de Sevilla y con financiación de CTA, para conseguir una nueva metodología que aplica Inteligencia Artificial para interpretar datos complejos procedentes de análisis metagenómicos, bioquímicos y fisicoquímicos del suelo del olivar

Vie, 31/01/2025 - 08:47 | dircom9
Desarrollan una metodología para la detección de zonas urbanas especialmente calientes en ciudades
El estudio, aplicado en Sevilla, determina que, dentro de la ciudad, las zonas más cálidas son las periferias rodeadas de infraestructuras y los polígonos residenciales del siglo XX, donde suele vivir población vulnerable en edificios obsoletos

Jue, 30/01/2025 - 09:22 | dircom7
cicCartuja y Ebro Foods reconocen a tres jóvenes investigadores en la 14ª edición de sus premios
El galardón, que reconoce los mejores trabajos publicados por jóvenes científicos y científicas del centro, ha recaído en Elena Cabello, del Instituto de Ciencia de los Materiales, y los dos accésits se han otorgado a Patricia Rodríguez y Gonzalo Pérez, ambos del Instituto de Investigaciones Químicas

Jue, 23/01/2025 - 10:16 | dircom9
Europa frente al reto de la ecoinnovación: avances y desigualdades en la sostenibilidad
Un estudio de la US revela cómo los países de la Unión Europea gestionan sus recursos para impulsar la innovación verde

Mié, 22/01/2025 - 14:36 | dircom9
150 expertos en Mineralogía y Arcilla se reúnen en la US
En el evento se han abordado los avances en Mineralogía, Arcillas, Petrología y Cristalografía, con un programa que ha inclido homenajes, talleres y visitas culturales

Mar, 21/01/2025 - 15:52 | dircom7
Una nueva técnica revela un mecanismo de tolerancia de las plantas a la alta salinidad
El desarrollo de una nueva técnica analítica para estudiar la nutrición vegetal aporta herramientas biotecnológicas para mejorar la tolerancia de las plantas a suelos salinos

Mar, 21/01/2025 - 15:39 | dircom7
Un catalizador radical de iridio permitirá aumentar la eficacia del uso de los metales preciosos en la industria química
La nueva estructura abre la puerta a un uso más eficiente y sostenible de los metales preciosos en la industria química

Mar, 21/01/2025 - 14:13 | dircom6
Sevilla y Río de Janeiro, unidas por la Historia de la Educación
El Museo Pedagógico de la Facultad de Ciencias de la Educación de la Universidad de Sevilla, en su empeño por internacionalizar el estudio y difusión del patrimonio histórico educativo desde una perspectiva de género, recibe a la profesora Cláudia Gonçalves de Lima

Lun, 20/01/2025 - 11:27 | dircom7
El tokamak SMART, un paso más cerca de la fusión nuclear con su primer plasma
Este avance supone un hito en el camino para lograr el dispositivo de fusión más compacto posible, uno de los principales objetivos de los investigadores del Laboratorio de Ciencia del Plasma y Tecnología de Fusión de la Universidad de Sevilla que desarrollan este proyecto

Vie, 17/01/2025 - 11:57 | dircom7
Bella Mora y Nicolás Capelo, premiados por el Ateneo por su estudio sobre neurodegeneración
Los investigadores de la Universidad de Sevilla han obtenido el primer premio en esta edición, dedicada a las enfermedades raras

Mié, 08/01/2025 - 11:08 | adminUS
Concluye el ciclo de seminarios de investigación en Gestión Estratégica y Negocios Internacionales
El ciclo de seminarios internacionales reunió a expertos de prestigio mundial de distintas universidades y estudiantes de 20 países

Mar, 07/01/2025 - 13:49 | adminUS
Las partículas energéticas podrían ayudar a controlar las llamaradas del plasma en el borde de los tokamaks
Los hallazgos logrados por un equipo internacional liderado por la Universidad de Sevilla han sido publicados en Nature Physics y podrían ser clave para el diseño de centrales de fusión nuclear más compactas y eficientes

Vie, 27/12/2024 - 11:59 | dircom9
Identifican trazas de mercurio en varios monolitos calcolíticos de la cueva artificial de La Molina (Sevilla)
La US participa en el proyecto MEMORIES, que aborda la relación entre las mujeres y el poder durante la Prehistoria Reciente de la península ibérica

Lun, 16/12/2024 - 12:10 | dircom2
Un proyecto de la US analiza eventuales vulneraciones de derechos humanos por el uso desmesurado de la Euroorden
La Facultad de Derecho ha acogido un encuentro entre jueces, fiscales, abogados y otros operadores jurídicos, en el marco del proyecto europeo EPHESUS en el que también participan Grecia, Portugal, Bulgaria y Rumanía

Vie, 13/12/2024 - 08:41 | dircom7
La US se consolida entre las primeras universidades de España por captación de talento investigador
Destaca el éxito en la convocatoria de ayudas Ramón y Cajal, donde la Universidad de Sevilla lidera la captación de talento entre todas las instituciones de investigación españolas
Jue, 12/12/2024 - 10:19 | dircom2
Una investigación de la US permite predecir recaídas en pacientes de cáncer infantil
Los hallazgos contribuirán al desarrollo de estrategias terapéuticas más eficaces y personalizadas y serán incorporados a la práctica clínica diaria a partir de enero

Mié, 11/12/2024 - 13:12 | dingaraco
Investigadores del Instituto de Biomedicina de Sevilla desarrollan una nueva terapia para combatir el mieloma múltiple
Este avance representa un paso importante hacia el desarrollo de terapias más efectivas y duraderas para pacientes con mieloma múltiple

Jue, 05/12/2024 - 08:26 | dircom7
Físicos españoles discrepan de la Sociedad Británica del Sueño y defienden el cambio de hora en Reino Unido
José María Martín Olalla de la US y Jorge Mira Pérez de la USC cuestionan el manifiesto difundido por la British Sleep Society en el que se defiende la adopción del horario de invierno de forma permanente

Mié, 04/12/2024 - 11:45 | adminUS
Educación Universitaria para la Salud y la Sostenibilidad: ¡Al Colegio! lleva los ODS a las aulas
El proyecto está liderado por profesoras investigadoras de la Universidad de Sevilla y la Universidad de Cádiz

Mar, 03/12/2024 - 09:29 | dircom7
El European Research Council reconoce al profesor Tomás Ramírez con una Consolidator Grant
El catedrático del departamento de Química Inorgánica de la Universidad de Sevilla recibe 2 millones de euros para continuar con su investigación sobre biocombustibles

Lun, 02/12/2024 - 12:31 | dircom2
La Feria Internacional del Libro de Guadalajara acoge la primera publicación de la Red Hispanoamericana de Investigadores Patrimonialistas
La obra colectiva se titula 'El Patrimonio Cultural. Un recurso fundamental en el crecimiento económico sostenible de las sociedades modernas'

Lun, 02/12/2024 - 12:26 | dircom9
Investigadores de la US desarrollan tecnologías para la utilización de hidrógeno en la siguiente generación de aeronaves
El equipo de la ETSI participa en un proyecto europeo desarrollando nuevos conceptos de sistemas de producción de potencia no propulsiva

Jue, 28/11/2024 - 09:57 | dircom7
Avanzan en la personalización y prestación de cuidados de personas con necesidades complejas
El grupo de investigación 'Cuidados Complejos, Cronicidad y Resultados en Salud' – SIRONA ha presentado sus resultados en el Instituto de Biomedicina de Sevilla (IBiS)
Mié, 27/11/2024 - 14:36 | dircom6
El grupo 'Cuidados Complejos, Cronicidad y Resultados en Salud' se presenta en el IBiS
El grupo, denominado SIRONA, incluye 21 investigadoras e investigadores de áreas como Enfermería, Medicina, Sociología, Podología, Antropología, Psicología, Estudios de género y Biología
Mié, 27/11/2024 - 13:00 | dircom2
Pescadores, agricultores y alcaldes piden un comité de expertos para analizar los impactos de los vertidos al Estuario del Guadalquivir
El Paraninfo de la Universidad de Sevilla ha acogido las Jornadas de Debate 'El Estuario del Guadalquivir: potencialidades económicas y pasivos ecológicos'
Mié, 27/11/2024 - 11:13 | adminUS
Investigadores internacionales desaconsejan la introducción del bisonte europeo en España
El estudio concluye que esta iniciativa carece de fundamento científico, plantea significativos riesgos ecológicos, legales y éticos

Vie, 22/11/2024 - 12:04 | dircom7
Un nuevo mecanismo genético clave para la producción de proteínas en la célula
Un estudio del IBiS ha identificado un nuevo mecanismo molecular que permite a las células maximizar la expresión de ciertos genes esenciales mediante un único factor regulador

Vie, 22/11/2024 - 09:42 | dircom9
Huellas fosilizadas revelan la presencia de flamencos en Doñana hace 150.000 años
Un equipo internacional de científicos, liderado por expertos de las universidades de Sevilla y Huelva, Naturtejo Geopark y el Espacio Natural Doñana, descubren las primeras huellas fosilizas de flamencos en Europa en la 'Superficie Pisoteada de Matalascañas'

Jue, 21/11/2024 - 09:15 | dircom2
Francisco Manuel Ocaña, miembro del Consejo Asesor de la Fundación de Neurociencias
Es profesor de la Facultad de Psicología de la US e investigador principal del grupo Neurociencia del Bienestar, con más de 20 años de experiencia en neurociencia y neurofisiología

Mié, 20/11/2024 - 12:31 | dircom6
El Comité de Ética de la Investigación de la US cumple tres años
El Comité se constituyó en noviembre de 2021, convirtiéndose en la primera entidad universitaria de este tipo y acreditada por la Secretaria General de Investigación y Calidad de la Junta de Andalucía.

Mié, 20/11/2024 - 10:42 | dircom7
Dos representantes de la US en la lista de los investigadores más citados del mundo
La última edición de la clasificación Highly Cited Researchers (autores altamente citados) selecciona al catedrático de la US Jesús Rodríguez Baño, que también desempeña su labor en el Hospital Universitario Virgen Macarena y el Instituto de Biomedicina de Sevilla, y a Cecilia Gotor Martínez, investigadora del Instituto de Bioquímica Vegetal y Fotosíntesis

Mar, 19/11/2024 - 08:54 | dircom9
Así cambia el cerebro de las víctimas de la violencia de género
Investigaciones recientes sugieren que, ante las agresiones físicas y psicológicas continuadas propias de la violencia de género, el cerebro experimenta daños neuronales detectables. En concreto, varios estudios con técnicas de neuroimagen han mostrado que el maltrato daña una de las estructuras más relevantes en la conectividad cerebral: la materia blanca.
Mié, 13/11/2024 - 13:55 | dircom9
Más de 300 expertos en Ingeniería Biomédica se dan cita en el CASEIB 2024
La Escuela Técnica Superior de Ingeniería de la Universidad de Sevilla acoge el XLII Congreso Anual de la Sociedad Española de Ingeniería Biomédica, CASEIB 2024, con más de 300 expertos en biomedecina y biotecnología.
Mié, 13/11/2024 - 11:58 | dircom9
Descubren en Gibraltar una estructura compleja creada por neandertales
Un equipo internacional de científicos, con la participación de la Universidad de Sevilla, ha descubierto en la Cueva de Vanguard una estructura creada por neandertales hace 60.000 años para producir brea de forma controlada

Mié, 13/11/2024 - 11:54 | dircom9
Un nuevo enfoque abre posibilidades en la lucha contra infecciones por bacterias resistentes a los fármacos
Una investigación del Instituto de Biomedicina de Sevilla desarrolla un enfoque innovador basado en la transferencia adoptiva de células de memoria para combatir infecciones por Acinetobacter baumannii multirresistente

Mié, 06/11/2024 - 13:28 | dircom7
El profesor José Antonio Odriozola nombrado Profesor Honorario de la Beijing Forestry University
Esta universidad china, con la que el profesor Odriozola mantiene relaciones desde hace años, es la mejor universidad del país en temas de ecología y ecosistemas

Mié, 06/11/2024 - 10:58 | dircom7
Reforzar la colaboración entre agentes políticos, investigadores y profesionales para mejorar la provisión de apoyo familiar
La red EurofamNet presenta en el Comité Europeo de las Regiones los resultados del proyecto QA[4]EuroFam sobre el desarrollo y la aplicación de un protocolo de garantía de calidad en los servicios de apoyo familiar en Europa
Mié, 06/11/2024 - 10:09 | adminUS
Descubren cómo una crisis de salinidad extinguió al 89% de las especies del Mediterráneo
Un nuevo estudio en el que participa la Universidad de Sevilla revela el impacto devastador de la Crisis de Salinidad del Messiniense en la biodiversidad marina hace 5,5 millones de años

Mar, 05/11/2024 - 13:43 | dircom7
Biomedal y la US desarrollan una prueba que facilitará el diagnóstico de patologías digestivas
El método, en desarrollo a través de un proyecto de I+D+i cofinanciado por CTA, facilitaría el diagnóstico y evolución de manera no invasiva de patologías relacionadas con el sistema digestivo, como la enfermedad celíaca o la inflamación intestinal

Lun, 04/11/2024 - 13:17 | dircom7
Cabimer y la Fundación Instituto Biomol reconocen el talento emergente en la II Edición de sus premios
El objetivo de estos premios es reconocer la excelencia en la investigación, destacando aquellos trabajos que han contribuido significativamente al avance del conocimiento en áreas clave de la biología molecular en biomedicina

Mié, 30/10/2024 - 14:07 | dircom7
Únete a la Base de Datos de Expertos de Ulysseus
Descubre oportunidades y conéctate por toda Europa. Expande tu red y accede a oportunidades exclusivas en las principales universidades de Europa

Mié, 30/10/2024 - 12:14 | dircom7
La US organiza una treintena de actividades para las Semanas de la Ciencia de Andalucía
Un centenar de investigadores de la US desarrollarán esta amplia programación tanto en varios centros de la US como en otros centros educativos y en espacios públicos

Mar, 29/10/2024 - 12:42 | dircom7
“Mi sensación es que las posibilidades en Harvard son infinitas”
José Antonio López Valverde acaba de llegar a Harvard con una beca del Real Colegio Complutense y en dos años volverá a la US para continuar su carrera investigadora. Este 7 de noviembre se celebra una sesión para conocer más sobre estas becas

Mar, 29/10/2024 - 12:08 | dircom7
La US mira al espacio de la mano de grandes expertos de todo el mundo
El evento CONEX24 llega a la US con expertos de la NASA, la ESA y varias universidades y centros de investigación españoles y europeos para hablar en tono divulgativo sobre la ciencia y el espacio

Lun, 28/10/2024 - 14:10 | adminUS
La profesora Corrales Gutiérrez, galardonada en los Premios Científicos San Lucas
La profesora e investigadora de la US ha logrado la distinción por su investigación sobre el consumo de alcohol en embarazadas
Lun, 28/10/2024 - 14:04 | dircom2
La US estudiará con IA las causas de la alta incidencia de cáncer de pulmón en Sevilla, Cádiz y Huelva
El objetivo final de las jornadas 'Miradas 2024' es crear una plataforma que permita a distintos hospitales compartir sus datos con los que dar soluciones a problemas oncológicos

Vie, 25/10/2024 - 13:32 | dircom7
Lola Pons y Elena Ceballos obtienen el Premio Universidad de Sevilla a la Divulgación Científica
El jurado ha reconocido tanto la trayectoria de ambas investigadoras como la proyección local, nacional e internacional de sus acciones divulgativas

Vie, 25/10/2024 - 11:26 | dircom7
Descubren patrones de maduración cerebral atípica en pacientes con psicosis
Investigadores de la US han participado en un estudio que revela cómo las alteraciones en el desarrollo del cerebro en psicosis podrían estar relacionadas con el metabolismo y neurotransmisores

Jue, 24/10/2024 - 12:08 | dircom7
“Harvard me ha brindado una forma diferente de concebir mi realidad académica”
Unai Iriarte retorna al departamento de Historia Antigua de la US después de dos años en Harvard gracias a una de las becas del Real Colegio Complutense para investigadores de la US

Jue, 24/10/2024 - 10:09 | dircom2
La US no detecta efectos ambientales significativos tras los dragados en el estuario del Guadalquivir
El monitoreo del Laboratorio de Biología Marina de la US arrojó que el impacto fue "pequeño y de corta duración"
Mié, 23/10/2024 - 13:00 | adminUS
Celebrado seminario internacional de investigación de la Red CARVEland
El evento celebrado en Macael, abordó la gestión y patrimonialización de los paisajes extractivos del mármol mediante investigación, creatividad y acción

Jue, 17/10/2024 - 09:07 | dircom7
La melatonina podría reducir la dosis de corticoides en el tratamiento de la esclerosis múltiple
Una investigación del Instituto de Biomedicina de Sevilla (IBiS) demuestra que la combinación de melatonina y metilprednisolona protege eficazmente contra la esclerosis múltiple en modelos animales, permitiendo reducir hasta cuatro veces la dosis de corticoides

Mié, 16/10/2024 - 14:00 | adminUS
Celebrado el XV Simposio Internacional sobre Electrocinética en la US
El evento contó con ponentes internacionales de renombre, donde también se celebró la segunda reunión de la Sociedad Internacional de Electrocinética

Mié, 16/10/2024 - 09:54 | dircom6
El turismo aporta 5.039 millones de euros de Valor Añadido Bruto a la ciudad de Sevilla y representa casi el 18% del empleo
Investigadores US han presentado estos resultados en el marco del proyecto IMPETUS

Mar, 15/10/2024 - 12:42 | dircom7
El 10º Meeting sobre Cosmología Fundamental se celebra en la US
El encuentro se enmarca dentro de las actividades organizadas con motivo de la Presidencia de Sevilla de la red de Ciudades Ariane en 2024

Mar, 15/10/2024 - 11:11 | dircom2
El poeta y repentista Alexis Díaz-Pimienta y la investigadora Cristina Moya cierran el I Festival Sabio
El evento, organizado por la Universidad de Sevilla y la Fundación Cajasol, concluye conversando sobre reinas de España el martes 15 de octubre a las 19.00 horas en la Sala Antonio Machado de la fundación
Vie, 11/10/2024 - 13:18 | adminUS
Activamente, el primer portal de divulgación científica sobre actividad física y deporte
Ofrece contenido riguroso y basado en evidencia científica, dirigido tanto al público general como a profesionales de la salud y el deporte
Vie, 11/10/2024 - 09:16 | dircom9
La Universidad de Sevilla comienza una nueva excavación en el fascinante templo egipcio de Tutmosis III
La arqueóloga y Egiptóloga de la US Myriam Seco lidera el equipo internacional que trabajará para revelar nuevos hallazgos en el templo dedicado al poderoso faraón

Jue, 10/10/2024 - 09:40 | dircom7
El Informe GEM Andalucía 2023-2024 muestra una evolución positiva del emprendimiento en la comunidad
El profesor Francisco Liñán se ha encargado de la dirección técnica de este estudio, en el que han participado otros ocho profesores de cuatro universidades andaluzas
Mar, 08/10/2024 - 14:43 | dircom6
La composición arquitectónica ante una sociedad en cambio
Esta nueva publicación recoge las reflexiones del IV Encuentro de Áreas de Composición Arquitectónicas celebrado en la ETS de Arquitectura en 2022

Mar, 08/10/2024 - 12:26 | dircom2
4 de cada 10 adolescentes manifiestan haber tenido o creen haber tenido un problema de salud mental
El estudio, elaborado por la Universidad de Sevilla y UNICEF, indica además que más de 1 de cada 3 no ha hablado con nadie sobre esos problemas y más de la mitad no ha pedido ayuda

Mar, 08/10/2024 - 10:56 | dircom7
Los XII Premios Manuel Losada Villasante reconocen a cuatro investigadores andaluces de excelencia
Patricia Altea (Cabimer), Gabriel Lozano Barbero (CSIC) y los profesores de la US Consolación Álvarez y Daniel Gutiérrez han sido los cuatro investigadores galardonados

Mar, 08/10/2024 - 09:42 | dircom2
Alfonso Sánchez, de Los Compadres, y la profesora de la US M. Ángeles Martín-Prats, en la segunda sesión del Festival Sabio
El primer festival de cultura científica de la ciudad continúa el 9 de octubre en el Teatro de la Fundación Cajasol a las 19.00 horas

Lun, 07/10/2024 - 09:55 | dircom7
Stanford reconoce a 143 investigadores de la US entre el 2% de los mejores científicos del mundo
La US mejora sus indicadores y cuenta con 143 de sus investigadores en la élite mundial, un 4 % más que en la edición anterior, ocupando más posiciones destacadas a nivel internacional en la lista anual y lista de carrera, según la prestigiosa Universidad de Stanford
Jue, 03/10/2024 - 09:59 | adminUS
El catedrático Cabeza Laínez completa una tetralogía sobre la transferencia radiante debida a formas geométricas
Los artículos han sido publicados en las revistas Mathematics, Applied Sciences y Buildings y pueden repercutir en el campo de la industria aeroespacial, la iluminación y la arquitectura

Mar, 01/10/2024 - 09:06 | dircom7
Diseñan una IA para predecir la migración celular en el cáncer de mama
En este estudio, publicado en la revista Computers in Biology and Medicine, los investigadores han desarrollado una Inteligencia Artificial (IA) que supone un avance importante en la combinación de técnicas de deep learning y biología computacional.
Lun, 30/09/2024 - 12:27 | dircom2
El IBiS organiza unas jornadas abiertas al público sobre las enfermedades neuromusculares
El evento 'IBiSiviliza la ciencia' está organizado junto con asociaciones de pacientes y fundaciones con el objetivo de dar a conocer las investigaciones realizadas en el IBiS, acercando así la ciencia a la sociedad

Jue, 26/09/2024 - 09:11 | dircom2
Una investigación predice con IA los efectos secundarios en tratamientos de cáncer de pulmón
El estudio ha recibido el Premio de la Cátedra Universitat de Barcelona-Atrys, por suponer un destacado avance en la personalización de los tratamientos oncológicos, que permitirá predecir complicaciones y minimizar los riesgos

Mié, 25/09/2024 - 07:44 | dircom7
La nueva Quimioteca del CSIC se coordina desde el cicCartuja
Se trata de un repositorio de moléculas orientado a identificar dianas terapéuticas y desarrollar nuevos fármacos que está disponible para cualquier grupo de investigación público o privado

Mar, 24/09/2024 - 11:08 | dircom7
Ulysseus reúne a ocho especialistas en cáncer en Hope Through Cancer Research
Esta serie de entrevistas forma parte de las actividades organizadas con motivo de la nueva edición de la Noche Europea de los Investigadores y permitirá conocer los últimos avances científicos en materia de cáncer

Lun, 23/09/2024 - 14:07 | dircom2
El humorista Manu Sánchez y el investigador de la US Luisma Escudero abren el Festival Sabio
Conversarán sobre el escutoide, la figura geométrica descrita por primera vez por investigadores de la US, que ha llegado a Marvel
Lun, 23/09/2024 - 12:09 | adminUS
La Politécnica presenta un proyecto de innovación docente para promocionar Objetivos de Desarrollo Sostenible
Participan 22 docentes de la US y una profesora del Instituto Politécnico Nacional de México

Vie, 20/09/2024 - 11:30 | dircom7
Un compuesto de la dieta que aumenta la longevidad y protege contra una patología del Alzheimer en modelos experimentales
Se trata del carotenoide fitoeno, que se encuentra en alimentos como tomates, zanahorias, albaricoques, pimientos rojos, naranjas, mandarinas o maracuyá, entre otros

Jue, 19/09/2024 - 12:15 | dircom7
Casi 3.000 científicos tomarán las calles andaluzas en La Noche Europea de los Investigadores
La decimotercera edición de La Noche, que se celebra este viernes 27 de septiembre, prevé la participación de más de 80.000 personas en las ocho provincias de Andalucía

Mié, 18/09/2024 - 11:28 | dircom7
Una investigación del IBiS revela el importante papel de una molécula en el control del VIH en tejido
En la investigación se está trabajando en distintas estrategias para lograr que personas con VIH puedan controlar el virus sin necesidad de tomar terapia antirretroviral de por vida

Mar, 17/09/2024 - 11:44 | dircom7
Prevención del suicidio y abordaje de la depresión en la población gitana
El proyecto Europeo 'Modular Mental Health Toolbox' (MentBox), que comenzó oficialmente el 1 de septiembre de 2024, se inaugura con el kick-off meeting que se celebra en el Instituto de Biomedicina de Sevilla los días 16 y 17 de septiembre

Lun, 16/09/2024 - 13:12 | dircom2
La US y la Fundación Cajasol crean el Festival Sabio, un encuentro entre investigadores y artistas de la palabra
Esta primera edición, dirigida por la catedrática Lola Pons y en colaboración con la Fundación José Manuel Lara y la Fundación Descubre, reunirá a prestigiosos investigadores en los ámbitos de la literatura medieval, la aeronáutica y la biomedicina en conversación con artistas como el repentista Alexis Díaz Pimienta, el humorista Manu Sánchez y el cineasta Alfonso Sánchez.
Lun, 16/09/2024 - 12:12 | dircom7
Más de 1000 investigadores de 36 universidades se reúnen en la Bienal de Investigación en Arquitectura de la US
El evento, que cuenta con una decena de sesiones temáticas y más de 150 ponencias, se celebra entre los días 17 y 20 de septiembre

Jue, 12/09/2024 - 09:37 | dircom9
El Cambio Climático podría hacer desaparecer las marismas de Doñana
Investigadores de la Universidad de Sevilla, en colaboración con la Universidad Tecnológica de Perú, han publicado un estudio que concluye que estos humedales podrían desaparecer en un tiempo que oscila entre los 42 y 189 años

Mié, 04/09/2024 - 13:15 | dircom7
Mejorando la calidad de vida de pacientes con Trastornos del Movimiento Funcional
Un ensayo clínico publicado desde el IBiS demuestra por primera vez que un abordaje multidisciplinar que integre fisioterapia específica y terapia cognitivo-conductual es eficaz para mejorar los síntomas y aspectos físicos de la calidad de vida de pacientes con Trastornos del Movimiento Funcional.

Mié, 04/09/2024 - 12:20 | dircom6
Una investigación sobre salud espiritual consigue una prestigiosa beca de movilidad Brasil-España
El programa de movilidad de la Fundación Carolina ha permitido a la investigadora de la US Rocío de Diego Cordero realizar una estancia en la Universidad Federal de Juiz de Fora (Brasil)

Jue, 29/08/2024 - 11:01 | dircom7
La acuaponía permite a comunidades vulnerables en Colombia alcanzar la soberanía alimentaria
Esta técnica que combina el cultivo de hortalizas con la cría de peces permite a las familias colombianas que participan en el proyecto obtener alimentos para su propio consumo y para hacer pequeñas ventas

Mar, 20/08/2024 - 10:43 | dircom7
La ciencia temprana y el genio creativo en la construcción del Dolmen de Menga
Esta construcción megalítica, situada en Antequera y erigida hace 6000 años, muestra signos de técnicas avanzadas que sugieren la gran precocidad de los desarrollos técnicos y científicos existentes en el Neolítico europeo, muy anteriores a los desplegados entre las primeras sociedades estatales del Próximo Oriente y Egipto

Lun, 12/08/2024 - 13:22 | dircom7
Un estanque experimental para la cría de especies y el disfrute de los vecinos de Torreblanca
Investigadores del grupo TAR de la Universidad de Sevilla y la empresa Anxanar han desarrollado un estanque para la formación de técnicos, la investigación y el disfrute de los vecinos
Vie, 09/08/2024 - 11:03 | dircom9
Los artesanos prehistóricos ibéricos “falsificaban el ámbar” que colocaban en las tumbas
Utilizaban una mezcla de cera de abeja, resina de pino y un tinte vegetal que se adhería a la pieza con un adhesivo realizado con hueso

Mié, 31/07/2024 - 13:23 | dircom2
La US promoverá el diseño de nuevos frenos, neumáticos y pavimentos para detener las muertes por microplásticos en el aire
Las partículas contaminantes que desprende el desgate de los vehículos superan a las procedentes de los tubos de escape

Mié, 24/07/2024 - 12:14 | adminUS
Modificaciones del ADN de los hongos y su papel en la regulación génica
Nature hace público el estudio de un equipo con participación internacional coordinado por personal de la Universidad de Sevilla

Mié, 24/07/2024 - 09:50 | dircom9
Nuevos mecanismos para el correcto desarrollo del cerebro
Una investigación del IBiS señala a la mitocondria como una nueva vía para modular la función de la microglía, cuya actividad está estrechamente ligada a la neurodegeneración.

Jue, 18/07/2024 - 12:54 | dircom7
La FISOCAT reconoce la trayectoria científica de excelencia del profesor José Antonio Odriozola
La Federación Iberoamericana de Sociedades de Catálisis (FISOCAT) ha anunciado la concesión del Premio a la Trayectoria Científica de Excelencia FISOCAT 2024 Senior, que se entregará en septiembre en Bilbao

Jue, 18/07/2024 - 09:49 | dircom7
Cultivar hortalizas y generar energía eléctrica de forma simultánea
El ahorro de agua o el uso más eficiente del territorio son algunos de los beneficios que espera aportar esta investigación

Mar, 16/07/2024 - 12:36 | dircom7
Inteligencia artificial y matemáticas, el binomio que está cambiando el mundo
Asistentes al 9º Congreso Europeo de Matemáticas en Sevilla ponen el foco en la IA
Jue, 11/07/2024 - 11:12 | dircom9
Descubren un mecanismo de adaptación de las bacterias a ciertos antibióticos
Investigadores del Instituto de Biomedicina de Sevilla- IBiS, la Universidad de Sevilla y el Hospital universitario Virgen Macarena publican un trabajo en el que exploran en profundidad mecanismos que bloqueen el desarrollo de la resistencia a las bacterias

Mié, 10/07/2024 - 13:10 | dircom7
Los artesanos prehistóricos creaban cuentas de ámbar falsas
Un equipo de investigación de la US desvela esta práctica, que pretendía satisfacer la demanda en lugares donde el ámbar era escaso

Lun, 08/07/2024 - 11:12 | dircom9
Una investigación pone en valor los lodos obtenidos en las depuradoras de aguas residuales
Investigadores de la Universidad de Sevilla lideran el proyecto que pretende aumentar la producción de biogás a partir de estos lodos

Jue, 04/07/2024 - 12:26 | adminUS
María del Mar García explora la transformación del arte por la IA en una conferencia en la Universität Tübingen
La investigadora de la US visita la universidad alemana para compartir y profundizar en su propia investigación sobre la intersección entre arte y tecnología

Mar, 02/07/2024 - 12:13 | dircom2
Los mejores matemáticos de Europa se dan cita en Sevilla
La Universidad de Sevilla es la encargada de organizar este evento, considerado el segundo más importante del mundo en esta disciplina
Lun, 01/07/2024 - 09:38 | dircom2
Un novedoso estudio con inteligencia artificial muestra la eficacia de tratamientos más cortos en cáncer de mama
La colaboración entre la Escuela Técnica Superior de Ingeniería Informática (ETSII) y el Hospital Virgen del Rocío evidencia un avance significativo en los tratamientos y logra atender a tres personas en lugar de a una y descongestionar las máquinas para otros tratamientos oncológicos

Mar, 25/06/2024 - 12:59 | dircom7
Algoritmos capaces de predecir catástrofes marítimas como tsunamis o inundaciones en tiempo real
El proyecto, financiado por la Agencia Estatal de Investigación, está coordinado por matemáticos de la Universidad de Sevilla y la de Málaga y cuenta con la colaboración de una amplia red de personal investigador y centros de alerta de Europa y Estados Unidos

Lun, 24/06/2024 - 15:20 | dircom7
Los premios Manuel Losada Villasante reconocen la labor de cuatro investigadores andaluces
Patricia Altea (Cabimer), Gabriel Lozano Barbero (CSIC) y los profesores de la US Consolación Álvarez y Daniel Gutiérrez han sido los cuatro investigadores reconocidos por el jurado de la XII edición de estos premios

Lun, 24/06/2024 - 13:00 | dircom2
La US organiza el 9º Congreso Europeo de Matemáticas que reúne en Sevilla a más de 1.300 expertos
El evento de la European Mathematical Society (EMS) se celebra cada cuatro años y está considerado el segundo más importante del mundo en matemáticas. Durante la inauguración se entregarán los Premios EMS

Lun, 24/06/2024 - 11:05 | dircom7
Inaugurada la Cátedra USE-CHIP para la formación de especialistas en microelectrónica y semiconductores
Esta nueva cátedra ha obtenido 4,2 millones de euros de financiación del Ministerio para la Transformación Digital y de la Función Pública, a través de la Secretaría de Estado de Telecomunicaciones e Infraestructuras Digitales

Vie, 21/06/2024 - 10:23 | dircom6
Emilia Guisado aborda con el Congreso de los Diputados la gestión sostenible de zonas costeras
La investigadora US ha participado en una jornada de la Oficina de Ciencia y Tecnología del Congreso de los Diputados
Vie, 21/06/2024 - 10:20 | dircom9
Las vacaciones en la naturaleza y sus beneficios para el cerebro
La investigadora de la US Susana Gaytán aprovecha el inicio del verano para describir en un artículo en la plataforma 'The Conversation' qué tipo de vacaciones ofrecen una buena oportunidad para estimular el cerebro y recargar energías

Mar, 18/06/2024 - 14:12 | dircom2
Una investigación de la US cifra en 3,3 millones las pérdidas anuales en Tarifa por el alga que invade las costas andaluzas
El estudio pone en evidencia la importancia de implementar mecanismos de prevención, detección temprana y acción precoz de nuevas especies

Mar, 18/06/2024 - 13:44 | dircom7
FACO[N]TACT: un proyecto para mejorar el bienestar de jóvenes tutelados con familias colaboradoras
En Andalucía hay alrededor de 2.400 niños, niñas y adolescentes que viven en centros de protección de menores. Por lo que, a través del proyecto FACO[N]TACT, se aunará el trabajo iniciado desde las diferentes entidades en materia de la protección a la infancia y adolescencia y bienestar infantil

Vie, 14/06/2024 - 12:56 | dircom7
El consumo de hortalizas de huertos urbanos no presenta riesgos para la salud
A pesar de que algunos de los suelos de estos huertos mostraron contaminación por elementos potencialmente contaminantes, los resultados muestran que el riesgo potencial para la salud humana es mínimo

Vie, 14/06/2024 - 11:04 | dircom7
Una innovadora arquitectura de propulsión de aeronaves mediante hidrógeno nacida en la ETSI
Esta tecnología desarrollada por investigadores de la US, además, abre la puerta a la incorporación de otras fuentes de energía, como la solar, y la posibilidad de recuperación de energía en alguna de las fases de vuelo

Mié, 12/06/2024 - 14:29 | dircom2
Las chicas de secundaria sufren más estrés escolar que los chicos
Un equipo científico de la Universidad de Sevilla ha recabado datos de cerca de 5.000 escolares en 54 centros educativos de Andalucía

Lun, 10/06/2024 - 13:14 | dircom7
Investigadores de CABIMER descubren una nueva vulnerabilidad del cáncer de mama
Su estudio abre la posibilidad a desarrollar nuevos medicamentos que inactivan ciertas proteínas cuya acción influye en algunos de estos tumores

Mié, 05/06/2024 - 12:37 | dircom7
El pueblo gitano en América
El profesor David Lagunas ha publicado monografías y artículos sobre esta materia dentro del proyecto 'Etnografía de los Gitanos en América'

Vie, 31/05/2024 - 09:34 | dircom7
La US entrega sus Premios a la Divulgación Científica y a Trabajos de Especial Relevancia
Un proyecto para fomentar las vocaciones científicas entre las niñas y una investigación sobre la Hepatitis C se encuentran entre los galardodos

Mié, 29/05/2024 - 13:43 | dircom7
Identificada una nueva microalga en el nacimiento del río Tinto
El elevado nivel de lipofagia presente en Chlamydomonas urium confiere a esta microalga propiedades metabólicas que le permiten vivir en entornos extremos como las aguas ácidas del río Tinto

Mié, 29/05/2024 - 12:05 | dircom7
Descubierto el papel en la replicación del ADN del principal gen causante del cáncer de mama y ovarios hereditario
El hallazgo ha sido posible utilizando una técnica desarrollada por el grupo de investigación del profesor Román González-Prieto

Mié, 29/05/2024 - 09:21 | javcolbla
Cuarta edición del concurso '#HiloTesis: Tu tesis doctoral en redes sociales'
En esta cuarta edición habrá seis premios dotados con 500 euros cada uno
Lun, 27/05/2024 - 13:08 | adminUS
La alga invasora rugulopteryx okamurae como fuente de antioxidantes, biofertilizante y electricidad
Una Tesis Doctoral defendida en la Facultad de Química de la US propone la obtención de compuestos antioxidantes, biogás y biofertilizantes a partir de esta alga

Mié, 22/05/2024 - 15:00 | dircom2
La US y la UPO acogen un congreso internacional sobre argumentos antiimperialistas en la configuración del Imperio Romano
Se trata del primer workshop que organiza en España la Red Internacional Impact of Empire, uno de los grupos de investigación más potentes del mundo en la investigación sobre el Imperio Romano

Mié, 22/05/2024 - 13:55 | dircom7
'Ciencia en el río' lleva a estudiantes preuniversitarios de Sevilla la actividad de investigadores de la US
La Universidad de Sevilla y el Ayuntamiento organizan esta actividad en la que cuatro investigadores comparten con alumnos de primaria, secundaria y bachillerato sus proyectos y su trayectoria profesional

Mié, 22/05/2024 - 13:08 | dircom7
Estudiantes de EEUU visitan el proyecto FLORECE en la US
El proyecto está financiado por el Departamento de Agricultura de Estados Unidos y en él colabora el profesor de la US Antonio Delgado

Mié, 22/05/2024 - 12:15 | dircom7
El IBiS realiza su tercer evento de IBiSiviliza para dar visibilidad a la ciencia
El evento está dedicado al corazón, es totalmente gratuito y abierto al público y está organizado junto con asociaciones de pacientes y fundaciones con el objetivo de dar a conocer las investigaciones realizadas en el IBiS, acercando así la ciencia a la sociedad

Mar, 21/05/2024 - 09:42 | adminUS
Envío de propuestas para el simposio sobre inteligencia artificial e innovación periodística
El 3 de junio termina el plazo para el envío de propuestas para el simposio que se celebra en el II Congreso Internacional Comunicación en la Sociedad Digital

Lun, 20/05/2024 - 09:12 | dircom6
El papel de las coaliciones comunitarias en el bienestar psicológico de los residentes en barrios urbanos
El profesor de la Vanderbilt University Brian Christens ha realizado una estancia en la US y ha aprovechado para visitar coaliciones comunitarias en barrios de Sevilla

Mar, 14/05/2024 - 10:50 | javcolbla
José Miguel Pérez Jiménez, XXXVI Premio de Investigación de Enfermería ‘Enfermera Nanda Casado Salinas’
El profesor doctor ha sido premiado por su estudio titulado ‘Efecto del contacto piel con piel en el control del dolor en cesáreas, ensayo clínico aleatorizado’.

Lun, 13/05/2024 - 13:54 | dircom9
Descubren una terapia contra el cáncer anaplásico de tiroides sin dañar células sanas
Román González Prieto, investigador del CABIMER-Universidad de Sevilla, ha contribuido al estudio del mecanismo por el que actúa la terapia en este cáncer tan agresivo

Lun, 13/05/2024 - 09:08 | dircom2
Sevilla convierte bares en laboratorios durante el Festival Pint of Science
Los días 13, 14 y 15 de mayo, investigadores compartirán los avances más recientes de la ciencia. El éxito del año anterior ha llevado a la organización a proponer temas más sociales

Mié, 08/05/2024 - 13:51 | dircom7
El proyecto de fusión nuclear de la US recibe el apoyo institucional de la Comisión Europea y la Junta de Andalucía
Responsables europeos comprueban los avances del proyecto Fusion2Grid, una investigación pionera para crear una fuente de energía limpia y barata para el futuro

Mar, 07/05/2024 - 13:40 | dircom7
Descubren un nuevo mecanismo celular para adaptarse a la compresión en los tejidos epiteliales
Este estudio indica que las células epiteliales pueden adoptar la forma de “escutoide” para adaptarse mejor a la compresión ocasionada por el aumento del número de células en un espacio restringido
Mar, 07/05/2024 - 11:10 | dircom9
La US participa en la Feria de la Ciencia con una maqueta del escutoide y experimentos para los más jóvenes
Contará con un espacio propio donde habrá retos científicos, una exposición y una maqueta del escutoide, la forma geométrica descubierta en la Universidad de Sevilla

Lun, 06/05/2024 - 12:19 | adminUS
La profesora Petit de Gabriel participa en la 166ª sesión de la Corte Interamericana de Derechos Humanos
Estuvo acompañada por Iraida Giménez, doctora por la Universidad de Sevilla y profesora del Centro de Estudios Internacionales de la Universidad de Barcelona

Lun, 06/05/2024 - 09:45 | dircom7
Una investigación del IBiS abre nuevas vías de tratamiento para la COVID-19
El estudio describe que uno de los modos de señalización de la proteína IL-6 sobre el endotelio vascular está implicado en la inflamación intensa y los procesos de coagulación y trombosis observados en los pulmones durante la infección por SARS-CoV-2. La inhibición selectiva de las propiedades perjudiciales de la proteína IL-6, preservando sus efectos protectores, reduce la severidad y la mortalidad en un modelo experimental de covid-19 y el daño en pulmón a largo plazo

Vie, 03/05/2024 - 09:02 | dircom7
El papel clave de Galectina-3 en el desarrollo de tumores cerebrales
Investigadores de la US describen como la inhibición de esta proteína reduce significativamente el tamaño del glioblastoma y las metástasis cerebrales
Jue, 02/05/2024 - 11:58 | dircom7
41 investigadores se incorporan a la US gracias a diversas convocatorias de captación de talento
Los campos de estudio del nuevo personal investigador abarcan diversas ramas dentro de las cinco grandes áreas de conocimiento

Mié, 24/04/2024 - 13:32 | dircom7
Un equipo científico mundial revela un enorme árbol de la vida del ADN de las plantas
Los autores del estudio, entre los que figuran varios investigadores de la Universidad de Sevilla, han utilizado 1.800 millones de letras de código genético para construir un innovador árbol de la vida

Mié, 24/04/2024 - 09:43 | dircom7
Un estudio aporta una caracterización genética exhaustiva de la bacteria E Coli
El estudio PROBAC-EC demuestra que la estructura poblacional de la bacteria Escherichia coli en pacientes con infección grave es altamente compleja y que las características de virulencia y resistencia a antimicrobianos de estos microorganismos no se distribuyen aleatoriamente entre los distintos clones.

Mar, 23/04/2024 - 11:56 | dircom7
Estudian los hilos metálicos a base animal en tejidos medievales de los siglos XI al XV
Investigadores de la US publican en la prestigiosa revista Scientific reports de la editorial Nature un estudio que analiza estos tejidos medievales

Lun, 22/04/2024 - 11:07 | azucarque
Una investigación de la US, tema principal en la Copa COVAP
La Copa COVAP y Psicólogos de España se basan en una investigación de la Facultad de Psicología de la US sobre el uso de la economía de fichas

Mar, 16/04/2024 - 11:47 | dircom7
Investigadores del IBiS descubren características del virus compatibles con la curación del VIH
El hallazgo ha sido posible gracias al estudio de un grupo excepcional de personas dentro de los denominados “controladores de élite del VIH”, que son capaces de controlar el virus sin necesidad de tomar tratamiento antirretroviral.

Vie, 12/04/2024 - 08:35 | dircom9
Bailando sevillanas en una playa de cinco millones de años
Esta afirmación tiene su base científica y encontramos una muestra en el Museo de Geología de la Universidad de Sevilla

Jue, 11/04/2024 - 09:45 | dircom7
El profesor Manuel García Muñoz consigue una ERC Advanced Grant dotada con más de 2.5 millones de euros
La financiación irá destinada al desarrollo de su proyecto SMARTWAVES, cuyas aplicaciones potenciales van desde el desarrollo de reactores de fusión ultra compactos a la construcción de estaciones meteorológicas espaciales

Mar, 09/04/2024 - 10:28 | dircom2
Investigadores de la US participan en una iniciativa para mejorar los tratamientos de fertilidad gracias a la inteligencia artificial
Coordinados por el clúster on Tech Innovation desarrollan junto a empresas punteras en innovación tecnológica y equipos médicos especializados una solución tecnológica avanzada para mejorar los tratamientos de medicina reproductiva

Vie, 05/04/2024 - 12:12 | dircom2
Livelink Motor se alía con la US para mejorar su algoritmo de detección de accidentes
Permite salvar la vida de motoristas al reducir el tiempo de atención sanitaria desde que se produce una caída. El acuerdo con la US permitirá aplicar Inteligencia Artificial para mejorar el algoritmo.

Mié, 03/04/2024 - 13:52 | dircom7
Nace la Cátedra USECHIP de microelectrónica
La nueva cátedra une a investigadores con empresas punteras en el sector para potenciar la formación, la investigación y la transferencia de conocimiento

Mié, 03/04/2024 - 12:24 | javcolbla
El veterinario Eduardo Morales Jerrett presenta su tesis doctoral sobre el sector caprino andaluz
Titulada 'Razas autóctonas caprinas andaluzas en el Siglo XXI: diversidad de sistemas productivos como estrategia de viabilidad'

Lun, 01/04/2024 - 12:52 | dircom7
Botánicos de la US analizan el papel de los polinizadores en la evolución de flores con varias formas sexuales
Los investigadores han demostrado que las teorías de Darwin sobre la polinización precisa en plantas heterostilas se cumplen a gran escala

Vie, 22/03/2024 - 11:16 | dircom7
Investigadores europeos desarrollan un protocolo para evaluar la calidad de los programas de apoyo a las familias
La red EurofamNet trabaja desde 2019 para garantizar los derechos y el bienestar de niños, niñas y adolescentes, así como de sus familias

Jue, 21/03/2024 - 11:26 | dircom7
La proteína Orai1 abre nuevas oportunidades en la lucha contra el infarto de miocardio
Un grupo de investigación del IBiS ha descrito un mecanismo que se activa tras un infarto de miocardio y que implica a las proteínas Orai1, AC8 y CREB. La inhibición de Orai1 podría ser una nueva estrategia terapéutica para prevenir la progresión de la enfermedad después de un infarto, ayudando a reducir el daño aún mayor.

Mar, 19/03/2024 - 11:58 | dircom7
Los premios Fama-Universidad de Sevilla reconocen la excelencia de diez investigadores de la US
La ceremonia de entrega de los galardones ha reunido a los premiados de las dos últimas ediciones

Vie, 15/03/2024 - 11:46 | dircom2
El profesor de la US José López Barneo recibe el Premio Nacional de Investigación 2023
Este galardón es el más importante de nuestro país en el ámbito de la investigación científica y cada modalidad está dotada con 30.000 euros

Mar, 12/03/2024 - 11:40 | dircom7
Un prototipo de vivienda inteligente para personas con deterioro cognitivo
Investigadores de la Universidad de Sevilla presentan esta vivienda en colaboración con el IMSERSO en el evento Tecnosocial 2024

Mar, 12/03/2024 - 08:46 | dircom7
Promoviendo los comportamientos de movimiento saludables en niños menores de 5 años en Europa
Expertos europeos hacen un llamamiento a los gobiernos para que potencien la actividad física entre los niños

Lun, 11/03/2024 - 09:47 | javcolbla
Programa para dejar de fumar para personas con Diabetes Mellitus Tipo 2
La finalidad principal del proyecto es evaluar la eficacia y eficiencia de varios programas gratuitos para dejar de fumar

Vie, 08/03/2024 - 11:41 | dircom2
La US explora las maravillas del cerebro con un amplio programa de actividades
La Semana Mundial del Cerebro aglutina en Sevilla actos de las facultades de Medicina, Biología y Psicología

Jue, 07/03/2024 - 10:54 | dircom7
La ETS de Ingeniería acoge un seminario sobre Electrónica para entornos hostiles centrado en el primer satélite 100% andaluz
Destacados expertos en este campo han compartido sus conocimientos y experiencias en estas sesiones

Mié, 06/03/2024 - 11:25 | adminUS
Ruth Pliego, reconocida con el "The Huntington Medal Award" en numismática
La investigadora de la US se convierte en la primera mujer española galardonada con el prestigioso premio otorgado por la American Numismatic Society

Mié, 06/03/2024 - 09:57 | dircom7
Avanzan en la implementación de un protocolo europeo que garantice la calidad de los servicios de apoyo familiar
El proyecto QA[4]EuroFam abarca 22 países europeos

Mar, 05/03/2024 - 12:34 | dircom2
Psicología organiza actividades para la mejora de la salud cerebral
El programa de actos se enmarca en el proyecto de divulgación denominado “The Brain Wellness Club”, financiado por el Vicerrectorado de Investigación

Lun, 04/03/2024 - 09:37 | dircom7
Vacunación concomitante, un nuevo horizonte en la prevención de la COVID-19 y la influenza
La investigación concluye que la combinación de vacunas no solo es segura, sino que podría mejorar la eficacia contra ciertos tipos de virus de la gripe

Jue, 29/02/2024 - 13:08 | dircom7
El Servicio de Radioisótopos del CITIUS participa en el descubrimiento de huellas de homínidos del Pleistoceno tardío en la costa de Marruecos
Las huellas halladas son las más antiguas atribuidas al Homo sapiens en el norte de África y el sur del Mediterráneo

Jue, 29/02/2024 - 09:41 | dircom7
La US colabora con el Ministerio de Vivienda en la descarbonización del sector de la construcción
Esta colaboración se desarrollará por parte de los investigadores integrantes del proyecto INDICATE

Mar, 27/02/2024 - 10:47 | dircom2
AXA Research Fund apoya con un millón de euros la investigación del Cabimer sobre el riesgo cardiovascular durante la menopausia
Los fondos financiarán durante cinco años la investigación de Inés Pineda Torra en el Centro Andaluz de Biología Molecular y Medicina Regenerativa

Lun, 26/02/2024 - 13:28 | dircom2
Éxito de participación en el foro internacional sobre tecnologías de la información orientadas a la salud de la ETSII
El evento ha tratado de identificar de manera cooperativa problemas, oportunidades y soluciones relacionadas con la salud en regiones transfronterizas dentro de Europa

Mar, 20/02/2024 - 11:23 | dircom7
El Colegio de Enfermería de Sevilla reconoce los mejores trabajos de investigación y artículos científicos enfermeros
Varias investigadoras de la Universidad de Sevilla han sido premiadas con estos galardones

Mar, 20/02/2024 - 11:12 | dircom6
Colaboración de la US en el nuevo número de los Cuadernos del Audiovisual
Investigadoras de la US aportan varios estudios sobre la 'indefensión de los menores ante la pornografía en Internet', tema central de este número de la revista, y la portada es una obra premiada en el Certamen Nacional de Artes Plásticas 'Universidad de Sevilla'

Jue, 15/02/2024 - 14:14 | dircom6
BOECIO inicia sus talleres con drogadictos y alcohólicos anónimos
Esta iniciativa aplica la Filosofía a personas en riesgo de exclusión social,

Jue, 15/02/2024 - 09:28 | dircom7
Los escutoides atraviesan el universo Marvel
En el cómic ‘Los 4 fantásticos’ número 8 publicado en octubre de 2023, Reed Richards explica con detalle lo que son los escutoides a la Antorcha Humana

Mié, 14/02/2024 - 11:51 | dircom6
Éxito en los Cursos para el Centro de Competencias Digitales del MAPA
Esta formación recibe una alta valoración por sus temáticas innovadoras y sus aplicaciones para el sector agroalimentario

Mar, 13/02/2024 - 11:15 | dircom7
El pico de floración en Doñana se adelanta 22 días por el cambio climático
Un equipo de la Universidad de Sevilla ha analizado la evolución en la fecha de floración de medio centenar de especies vegetales durante los últimos 35 años en el Parque Nacional de Doñana

Vie, 09/02/2024 - 08:44 | dircom7
La Universidad de Sevilla obtiene 5 millones de euros para su Cátedra USECHIP de microelectrónica
La convocatoria pública le ha concedido 4,2 millones de euros, el resto se complementa con aportaciones privadas y de la propia universidad. Esta financiación permitirá diseñar decenas de microcredenciales

Mar, 06/02/2024 - 11:35 | dircom7
Nueva aplicación de un fármaco para la regeneración de lesiones cerebrales
Investigadores de las Universidades de Sevilla y Cádiz desarrollan este proyecto que ha descrito un nuevo uso para un medicamento que sirve para tratar el cáncer de pulmón

Mar, 06/02/2024 - 10:00 | dircom7
Una plataforma virtual para realizar cálculos de Física Nuclear
La herramienta permite a los usuarios realizar diferentes tipos de cálculos de estructura nuclear y de reacciones nucleares

Vie, 02/02/2024 - 13:54 | dircom2
Un profesor de la US participa en una propuesta de reforma de la Constitución sobre los derechos sociales
La modificación del profesor permitiría garantizar el derecho a la protección de la salud, el acceso equitativo a los tratamientos y servicios médicos más innovadores, la calidad de vida de las personas con enfermedades crónicas y la capacidad de respuesta ante futuras crisis como la del COVID-19

Jue, 01/02/2024 - 14:01 | dircom7
Las investigadoras de la US toman la calle por el Día Internacional de la Mujer y la Niña en la Ciencia
Durante el mes de febrero se celebrarán más de una veintena de actividades de divulgación científica

Mié, 31/01/2024 - 14:46 | dircom6
Desarrollan una plataforma de agromonitorización de cultivos del arroz en Cádiz y Sevilla
La Universidad de Sevilla, Emergya Grupo, Federación de Arroceros y la Corporación Tecnológica de Andalucía han sido los socios del proyecto SAMA

Mié, 31/01/2024 - 13:02 | dircom7
Un informe analiza la salud mental en los Centros de Internamiento de Extranjeros
Se trata de la primera publicación de este tipo centrada en los CIE y es fruto de la colaboración del Centro de Investigación y Acción Comunitaria de la Universidad de Sevilla) y los equipos de visitas de las entidades del Servicio Jesuita a Migrantes en tres centros

Mié, 31/01/2024 - 12:49 | adminUS
La red EurofamNet avanza en su proyecto QA[4]EuroFam
La red pretende implementar un protocolo de calidad a nivel europeo, fortaleciendo su compromiso con la calidad en los servicios de apoyo familiar

Mar, 30/01/2024 - 08:52 | dircom7
Implementando la política europea Open Data en Arqueología
Investigadores de la US ponen en marcha PEPAdb (Prehistoric Europe’s Personal Adornment database), una herramienta online y accesible con datos referidos a elementos de adorno personal en la Prehistoria reciente.

Vie, 26/01/2024 - 11:40 | dircom7
El proyecto VTSkills impulsa la sostenibilidad en la viticultura mediterránea
La Universidad de Sevilla lidera este proyecto en el que participan otras 13 instituciones, y que persigue una viticultura más sostenible.

Mié, 24/01/2024 - 11:33 | dircom7
El proyecto AGERAR PLUS organiza una jornada sobre el desarrollo de comunidades energéticas
La jornada reunió a expertos del ámbito de la energía que abordaron diferentes iniciativas sobre transición energética sostenible

Mar, 16/01/2024 - 11:43 | dircom7
Investigadores de la US cartografían y datan una presa y un embalse andalusíes del siglo XII en la Sierra de Segura
La presa de la Garganta del Ciervo es uno de los escasos ejemplos que aún se conservan en la península ibérica de presas de embalse andalusíes. Además, su sistema constructivo se aleja por completo de la tradición constructiva hispanorromana de este tipo de estructuras hidráulicas y se relaciona más con la forma de construir las presas orientales

Lun, 15/01/2024 - 09:14 | dircom7
La US y el SAS solicitan una patente sobre un sistema de agregados de nanopartículas para el tratamiento del tromboembolismo venoso
Esta enfermedad tiene una incidencia de un caso por cada 1000 habitantes y es la tercera afección cardiovascular más frecuente

Vie, 12/01/2024 - 14:17 | dircom7
Apoyo institucional al proyecto de fusión nuclear de la Universidad de Sevilla
Fusion2Grid se consolida como proyecto de investigación pionero para crear una fuente de energía limpia y barata para el futuro

Vie, 12/01/2024 - 09:18 | dircom2
El IBIS, financiado con 2,5 millones de euros por el programa estatal 'Fortalece'
La mayor parte del personal investigador que lidera las seis líneas que se van a reforzar proceden de la Universidad de Sevilla

Vie, 22/12/2023 - 10:33 | dircom7
Descubren cinco nuevas especies de erizos de pelaje suave originarios del sudeste asiático
Un investigador de la US participa en esta investigación liderada por el museo Smithsonian de Washington D.C.

Jue, 21/12/2023 - 13:01 | dircom7
La US recibe 6 millones de euros para crear un centro de innovación de vehículos aéreos no tripulados
El liderazgo de la Universidad de Sevilla en el sector ha sido clave para la concesión de esta financiación por parte de la Junta de Andalucía

Mar, 19/12/2023 - 12:25 | dircom7
Investigadores internacionales se interesan por el proyecto del Tokamak de la US
El proyecto Fusion2Grid ha recibido en las últimas semanas la visita de investigadores de las universidades de Princeton (EEUU) y Cork (Irlanda)

Vie, 15/12/2023 - 14:31 | dircom9
La procedencia de las piedras del dolmen de Menga, en Antequera, revela una de las mayores proezas de ingeniería del Neolítico
Investigadores de la US participan en un estudio que muestra la aplicación de nuevas tecnologías de madera y piedra que permitieron la construcción de un monumento sin precedentes

Mié, 13/12/2023 - 14:27 | dircom2
Los Premios cicCartuja Ebro Foods reconocen el talento joven investigador de la US
Javier Castillo Seoane ha ganado el primer premio, Pedro de los Reyes Rodríguez, el primer accésit, y Marina Pérez Jiménez y Helena Corona García de Leaniz, el segundo accésit ex aequo
Mié, 13/12/2023 - 11:08 | dircom6
Resueltos los premios 'Andrés Esteban Arbués' a las mejores publicaciones 'jóvenes' de Psicología
Estos premios, que han experimentado un notable aumento de participación desde su creación en 2017, reconocen las mejores publicaciones científicas de Psicología en las que participen investigadores/as jóvenes

Lun, 04/12/2023 - 09:24 | dircom7
Cabimer reconoce el joven talento científico con la I edición de sus premios
La integridad y función de la cromatina, la inestabilidad genómica y cáncer y la epigenética y expresión génica han centrado los trabajos reconocidos en estos premios, que han contado con el patrocinio de la empresa Biomol

Vie, 01/12/2023 - 11:50 | loretoUS
Más de un centenar de participantes en el Research Day de la Facultad de Medicina
Research day es la I Jornada de investigación para estudiantes de grado, doctorado y especialistas en formación de la Facultad de Medicina

Jue, 30/11/2023 - 14:01 | dircom7
Representantes del proyecto INDICATE reciben el respaldo del Ministerio de Vivienda
El objetivo del proyecto es potenciar la descarbonización en el sector de la construcción

Jue, 30/11/2023 - 08:23 | dircom7
El IBiS comienza un nuevo programa de divulgación para dar visibilidad a la ciencia
El Instituto de Biomedicina de Sevilla celebra este viernes 1 de diciembre su primera jornada sobre el cáncer dentro de un nuevo programa llamado 'IBiSiviliza la ciencia'

Mié, 29/11/2023 - 10:32 | loretoUS
Tres proyectos de investigación biomédica participados por la US reciben financiación de Fundación “la Caixa”
Tres proyectos del Centro Nacional de Aceleradores y del Instituto de Biomedicina de Sevilla han obtenido financiación en la Convocatoria CaixaResearh en Salud 2023
Mar, 28/11/2023 - 12:35 | loretoUS
SESAR presenta soluciones a los desafíos aéreos y para impulsar el Cielo Único Europeo
ENAIRE y la Universidad de Sevilla acogen los SESAR Innovation Days, programa de la Comisión Europea para aportar soluciones digitales y tecnológicas a los desafíos de la aviación

Mar, 28/11/2023 - 10:49 | dircom7
¿Qué variables favorecen la concesión de las estrellas Michelin en España?
A partir de una amplia base de datos de los restaurantes galardonados durante 20 años, investigadores de la US han analizado el rol de los establecimientos con estrella Michelin como instrumento de desarrollo económico local, ofreciendo un conjunto de recomendaciones para su multiplicación

Mar, 28/11/2023 - 08:34 | dircom7
El programa ATRAE financiará dos proyectos de la US
La Universidad de Sevilla se sitúa a la cabeza de las universidades españolas por captación de fondos y número de proyectos seleccionados en esta nueva convocatoria del Ministerio de Ciencia, Innovación y Universidades

Lun, 27/11/2023 - 12:12 | dircom6
Filosofía en prisiones con el documental 'BOECIO. Pensar desde mentes encarceladas'
El reportaje, de reciente estreno, narra la historia de más de mil talleres en centros penitenciarios europeos y americanos

Lun, 27/11/2023 - 11:18 | dircom7
Jesús Rodríguez Baño, incluido en la lista de los investigadores más citados de todo el mundo
La última edición de la clasificación Highly Cited Researchers (autores altamente citados) recoge al catedrático de la US, que también desempeña su labor en el Hospital Universitario Virgen Macarena y el Instituto de Biomedicina de Sevilla

Vie, 24/11/2023 - 12:36 | dircom7
Cuatro investigadores andaluces recogen los XI Premios Manuel Losada Villasante a la actividad investigadora
Manuel Delgado Baquerizo, del Instituto de Recursos Naturales y Agrobiología de Sevilla, y los investigadores de la US Patricia González Rodríguez, Sergio Montserrat de la Paz y Laura Pastor Pérez han sido los galardonados

Vie, 24/11/2023 - 11:50 | dircom7
La Asociación Española de Científicos premia a la investigadora de la US Isabel González
Ha sido reconocida por sus contribuciones en el campo de la geología ambiental y la mineralogía aplicada

Vie, 24/11/2023 - 11:16 | dircom2
Los vecinos más antiguos refuerzan la cohesión en los barrios
Los investigadores han llevado a cabo encuestas a los residentes de los barrios de Amate, Ciudad Jardín, Los Pajaritos y Nervión

Vie, 24/11/2023 - 10:00 | loretoUS
Galardonado el proyecto Orienta-2O en los premios Educaweb de Orientación Educativa y Profesional
El proyecto Orienta-2O dirigido a jóvenes en situación de riesgo social, en el que participa la Universidad de Sevilla junto con la Fundación Don Bosco y la Asociación Arrabal AID, ha sido premiado en la categoría Instituciones de los premios Educaweb de Orientación Educativa y Profesional.
Jue, 23/11/2023 - 12:47 | dircom7
Eleonora Viezzer consigue una nueva beca del Consejo Europeo de Investigación por más de 2 millones de euros
Se convierte así en la primera investigadora de la US en conseguir dos ERC Grants

Mar, 21/11/2023 - 09:29 | dircom7
Amparo Graciani y Luis María Escudero, Premios Divulgación Científica de la US
El jurado ha decidido concederles el premio ex aequo por la gran calidad de su trabajo en el ámbito de la divulgación

Lun, 20/11/2023 - 16:41 | dircom7
El IBiS desarrolla nuevas herramientas para investigar sobre la prevención de la espina bífida
Una investigación del IBiS ha descubierto nuevos fenotipos de defectos del tubo neural en el modelo de ratón "loop-tail" resistente a la suplementación con ácido fólico. Estos hallazgos no solo amplían nuestra comprensión de la enfermedad, sino que proporcionan valiosas herramientas para investigaciones futuras sobre la prevención de condiciones como la espina bífida.

Vie, 17/11/2023 - 13:16 | raffervel1
Se ofrece tratamiento contra el tabaquismo para personas con diabetes mellitus tipo 2
El Grupo de Investigación en Adicciones de la Universidad de Sevilla está desarrollando un programa de investigación

Jue, 16/11/2023 - 11:06 | dircom7
Un centenar de investigadores de la US entre los mejores del mundo según la Universidad de Stanford
Estos datos colocan a la Universidad se Sevilla como la séptima universidad española por número de investigadores seleccionados.

Mié, 15/11/2023 - 14:36 | raffervel1
Ya se conocen los resultados de 'Quiero ser creativa'
'Quiero ser creativa' es un proyecto de investigación para la Igualdad de la Universidad de Sevilla

Mié, 15/11/2023 - 12:26 | dircom2
Investigadores de la US participan en el nuevo robot Haru que detecta señales sociales y emocionales en menores con cáncer
El robot operará en el Virgen del Rocío y abordará con conversación, juego y aprendizaje el deterioro cognitivo que ocasionan los tratamientos oncológicos

Mar, 14/11/2023 - 12:05 | dircom2
La Universidad de Sevilla se convierte en sede del americanismo
80 jóvenes promesas de la investigación americanista se dan cita en la Facultad de Geografía e Historia entre el 20 al 22 de noviembre, en unas jornadas en las que el 40% de los ponentes procede de universidades y centros de investigación internacionales

Mar, 14/11/2023 - 10:08 | dircom7
Descubren que las mutaciones en células tumorales se asocian frecuentemente a híbridos de DNA-RNA
Investigadores de la US, CABIMER y el IRB Barcelona demuestran por primera vez que estos híbridos son una fuente clara de mutaciones asociadas a cáncer

Lun, 13/11/2023 - 13:03 | adminUS
Cádiz acoge el XV encuentro ibérico de Electromagnetismo Computacional
Las jornadas están organizadas por profesores de la Universidad de Sevilla pertenecientes al grupo de Microondas

Lun, 13/11/2023 - 12:29 | dircom7
El IMSE coorganiza una reunión internacional sobre la exploración de Marte del equipo MEDA
Aprovechando el descanso que se tomará el rover Perseverance mientras el planeta Marte pasa justo por detrás del Sol, el equipo internacional de científicos e ingenieros del instrumento español MEDA se da cita en Sevilla, en la sede de la Agencia Espacial Española, para hacer balance de los resultados obtenidos hasta la fecha y discutir los planes de trabajo futuro

Jue, 09/11/2023 - 10:20 | dircom2
Una investigación del IBiS abre nuevas vías para mejorar los tratamientos oncológicos
Revela cómo se reorganiza el genoma en células tratadas con quimioterapia

Mié, 08/11/2023 - 12:28 | dircom7
Investigadores de la US crean un sistema de detección inmediata de personas armadas gracias a la Inteligencia Artificial
El proyecto DISARM, desarrollado por un equipo coordinado desde la US y la UCLM, será capaz de evitar tiroteos y amenazas en lugares públicos y privados incorporando el deep learning a cámaras de videovigilancia

Mié, 08/11/2023 - 09:44 | dircom7
El Museo Pedagógico de la Facultad de Ciencias de la Educación entabla hermanamiento con el Museu da Escola Catarinense.
Representantes de ambas instituciones se reúnen en Florianópolis (Brasil) para explorar la futura colaboración en torno al estudio, recuperación, difusión e interpretación del patrimonio histórico educativo
Mar, 07/11/2023 - 13:35 | dircom7
Se buscan participantes para un estudio sobre tabaco y emociones
El estudio se realizará en la Facultad de Psicología de la US y tendrá una duración de una hora

Mar, 07/11/2023 - 11:00 | dircom7
La US participa en la declaración de Menorca Talayótica como Patrimonio Mundial de la UNESCO
El departamento de Prehistoria y Arqueología trabaja desde hace más de 10 años en el estudio del yacimiento de Sa Mitja Lluna, incluido en la candidatura menorquina

Lun, 06/11/2023 - 13:19 | dircom2
XXIII Semana de la Ciencia de Andalucía extenderá la innovación y el conocimiento
El evento se celebra del 6 al 19 de noviembre y cumple 23 años acercando ciencia de calidad, sostenible e inclusiva a la ciudadanía andaluza

Jue, 02/11/2023 - 20:20 | dircom7
Cuatro investigadores andaluces reconocidos con los XI Premios Manuel Losada Villasante a la actividad investigadora
Manuel Delgado Baquerizo, del Instituto de Recursos Naturales y Agrobiología de Sevilla, y los investigadores de la US Patricia González Rodríguez, Sergio Montserrat de la Paz y Laura Pastor Pérez han sido los galardonados

Lun, 30/10/2023 - 11:42 | dircom6
Estudio sobre la dimensión espiritual en la práctica clínica
La tesis fue presentada en la Facultad de Enfermería, Fisioterapia y Podología

Lun, 30/10/2023 - 11:01 | raffervel1
Alberto Martín López, Premio de Investigación SCIE 2023
Los Premios de Informática celebran la excelencia de los investigadores que están contribuyendo a forjar la tecnología más transformadora y versátil de la historia

Mié, 25/10/2023 - 13:14 | dircom7
El Laboratorio de Robótica GRVC de la ETSI organiza el cierre del proyecto internacional AERIAL-CORE en ATLAS
El proyecto trabaja desde 2019 en el desarrollo de un sistema de robots aéreos para colaborar con operarios humanos en las actividades de inspección y mantenimiento de grandes infraestructuras

Mar, 24/10/2023 - 09:58 | dircom2
Expertos internacionales en biología tumoral se dan cita en la VII Escuela de Biomedicina UIMP-IBiS
La científica norteamericana M. Celeste Simon, "investigadora distinguida" del Instituto de Biomedicina de Sevilla por sus descubrimientos en el metabolismo del cáncer

Jue, 19/10/2023 - 10:53 | dircom2
Investigadores del IBIS desvelan nuevos avances en el abordaje de enfermedades relacionadas con el Alzheimer
El hallazgo podría abrir nuevas vías terapéuticas para la tauopatía primaria, enfermedad neurodegenerativa con una alta prevalencia en la población envejecida

Mié, 18/10/2023 - 10:30 | dircom2
Investigadores de la ETS de Ingeniería de la Universidad de Sevilla participan en la Misión Alpha que lanzará el primer satélite andaluz
Trabajarán en la carga útil, en el diseño y análisis de la misión, determinación de órbita y orientación del satélite y en el sistema de control

Mié, 18/10/2023 - 10:10 | adminUS
Celebrado el segundo seminario internacional de investigación Alentejo 2023
El seminario ha abordado los avances en la investigación sobre los paisajes extractivos del mármol y los instrumentos de protección del paisaje

Mié, 18/10/2023 - 09:26 | dircom2
Cultural Fit Solutions, galardonada con el primer premio de INTECMED por su plataforma de inteligencia empresarial
La EBC creada por la Universidad de Sevilla dispondrá de 30 000 euros para desarrollar su proyecto

Mié, 11/10/2023 - 14:11 | dircom2
Un estudio arqueológico liderado por la US ayuda a la conservación de las lapas gigantes en peligro de extinción
Investigadores han analizado una colección compuesta por 1 203 ejemplares procedentes de 36 yacimientos arqueológicos del primer invertebrado y la primera especie marina para la que se ha elaborado una estrategia nacional de conservación

Mié, 11/10/2023 - 13:49 | dircom6
Los 'Agrocafés' de la ETSIA dan comienzo con la investigadora Itziar Aguirre
Diferentes investigadores del centro pasarán este curso por estos amenos encuentros con la comunidad universitaria

Mar, 10/10/2023 - 12:08 | dircom7
Describen por primera vez el potencial terapéutico de eliminar la proteína SOS1 del microentorno de tumores de pulmón
El estudio del Centro de Investigación del Cáncer (CIC) y el Instituto de Biomedicina de Sevilla (IBiS) identifica nuevas dianas para tumores de pulmón con mutaciones en el gen KRAS

Mar, 10/10/2023 - 11:52 | dircom7
Una nueva función de una conocida proteína para mantener la estabilidad del genoma
Investigadores de la US y la Universidad de Texas desvelan el papel clave de la nucleasa de RNA DICER en la eliminación de híbridos DNA-RNA tóxicos, responsables de la inestabilidad genómica presente en las células cancerígenas

Lun, 09/10/2023 - 12:04 | dircom7
Un nanochip para proteger los dispositivos electrónicos frente a ciberataques
El chip, obtenido por investigadores del IMSE (CSIC-Universidad de Sevilla), permite generar una clave digital única del dispositivo que puede usarse para generar contraseñas criptográficas efímeras de alta seguridad

Mié, 04/10/2023 - 10:02 | raffervel1
Jennifer Ezema firma un trabajo sobre la violencia de género en Nigeria
La doctoranda de la Universidad de Sevilla, apoyada por el programa de becas de la Katholieke Universiteit Leuven (Universidad Católica de Lovaina), pone en relieve la situación en violencia de género de las mujeres nigerianas.

Lun, 25/09/2023 - 14:36 | dircom6
HASER se convierte en la segunda revista de Filosofía en Iberoamérica según JCR
Esta publicación se edita desde la Universidad de Sevilla y se ubica en el Departamento de Metafísica y Corrientes Actuales de la Filosofía, Ética y Filosofía Política de la Facultad de Filosofía
Lun, 25/09/2023 - 12:56 | adminUS
OPTIMA reconoce a la obra 'Flora Iberica' con la medalla de plata del trienio 2019-2021
La Universidad de Sevilla ha participado extensamente desde 1990 a 2021 en cinco volúmenes de la obra

Lun, 25/09/2023 - 12:04 | dircom7
Una herramienta de código abierto capaz de detectar patrones ocultos en los tejidos celulares
CartoCell es una herramienta de análisis de imágenes en 3D que utiliza inteligencia artificial para descubrir patrones de morfología celular escondidos en tejidos epiteliales, con aplicaciones tanto en ciencia básica como en desarrollo clínico y médico

Lun, 25/09/2023 - 11:15 | dircom7
Nuevas claves para entender las estelas prehistóricas ibéricas
Los últimos hallazgos del Grupo Atlas de la US en la necrópolis de Las Capellanías (Cañaveral de León, Huelva) permiten entender mejor estos elementos escultóricos

Vie, 22/09/2023 - 13:35 | adminUS
Trasplantes más exitosos con la aplicación de técnicas de inteligencia artificial
El grupo Minerva de la US y las unidades de Cirugía de los hospitales Virgen Macarena y Virgen del Rocío publican un estudio que mejora los trasplantes hepáticos

Vie, 22/09/2023 - 12:36 | dircom7
La US se vuelca con la divulgación científica destinada a los más jóvenes
Más de un centenar de alumnos de primaria y secundaria participan en las actividades previas a la Noche Europea de los Investigadores organizadas por la US

Vie, 22/09/2023 - 11:48 | dircom7
La ETSI pone a prueba drones bio-inspirados en el taller 'Energy-efficient flapping-wing robots'
Al evento han asistido más de una decena de expertos de Europa, América, Asia y Oceanía especializados en robots y vehículos aéreos no tripulados de ala batiente

Mar, 19/09/2023 - 11:53 | dircom7
La US participa en la organización del principal congreso de Microelectrónica en Europa
La edición de este año, que se ha celebrado en Lisboa, ha contado con casi un millar de asistentes

Lun, 18/09/2023 - 13:30 | dircom2
Investigadores de la US diseñan un sistema de IA que abarata el coste de la electricidad
La nueva metodología mejora la distribución eléctrica y perfecciona la calidad de la energía que se suministra a los clientes finales, evitando cortes o picos

Lun, 18/09/2023 - 12:27 | dircom2
Más de 3.000 científicos saldrán a la calle para dar a conocer su trabajo en La Noche Europea de los Investigadores
Este evento divulgativo, que se celebrará el 29 de septiembre, ofrece un programa de casi 1 000 actividades repartidas por toda Andalucía

Vie, 15/09/2023 - 12:07 | dircom2
Profesores de la ETS de Ingeniería descubren un método para producir microfibras de manera masiva
Pretende revolucionar los métodos convencionales ya que multiplicaría por mil la producción de unas microfibras que tienen multitud de usos

Vie, 08/09/2023 - 11:16 | dircom7
La Noche Europea de l@s Investigador@s vuelve a llenar Sevilla de ciencia el próximo 29 de septiembre
Más de 300 investigadores e investigadoras compartirán sus conocimientos con la ciudadanía en más de 120 actividades que tendrán lugar principalmente en la Plaza Nueva y otras localizaciones como Museo Casa de la Ciencia o Fundación Cajasol

Jue, 07/09/2023 - 11:39 | dircom2
Expertos de la US localizan posibles restos del circo de Itálica al este de la antigua ciudad romana
Ocuparía más de ocho campos de fútbol y tendría capacidad para acoger a unos 80.000 espectadores

Mié, 06/09/2023 - 12:24 | dircom2
Un estudio de la US permite hacer nuevas conexiones entre las enzimas y las enfermedades neurodegenerativas
Los investigadores desarrollaron unas trampas especiales que les permitieron resolver el puzle
Mié, 06/09/2023 - 11:56 | dircom7
Un estudio liderado por la US revela el papel de la proteína citocromo c en tejidos afectados por isquemia
La investigación, publicada en la prestigiosa revista Nature Communications, abre nuevos horizontes para el desarrollo de intervenciones terapéuticas en lesiones musculares por isquemia-reperfusión

Mié, 30/08/2023 - 13:27 | dircom2
Investigaciones de la US alertan del impacto del alga asiática sobre especies nativas de los fondos marinos
Proponen una red de estaciones centinela que permitan controlar la especie y prevenir que colonice nuevas zonas

Lun, 28/08/2023 - 11:17 | dircom7
El investigador de la US, Fernando Muñiz, participa en el hallazgo de abejas 'momificadas' de la época de los faraones
El descubrimiento de estas abejas, producido en el suroeste de Portugal, supone una oportunidad única para luchar contra el cambio climático

Lun, 07/08/2023 - 13:12 | dircom6
Un trabajo sobre el derecho a la vivienda de las trabajadoras sexuales, seleccionado en una convocatoria internacional de financiación
La investigación lleva por título 'Never Again Without Us': Strengthening Sex Workers’ Fight for Housing Rights from the Grassroots

Jue, 03/08/2023 - 11:07 | dircom6
El megalodón, un tiburón de 20 metros “que nadó y cazó en Sevilla”
El Museo de Geología de la US (MUGUS), ubicado en los servicios centrales de investigación (edificio CITIUS), conserva más de 5.000 piezas de minerales, rocas y fósiles, entre las que destaca el diente de un megalodón recolectado por Antonio Machado y Núñez

Vie, 28/07/2023 - 12:46 | dircom6
Una nueva vía para controlar la disminución del flujo de sangre en lesiones musculares
Un grupo del Instituto de Investigación Química del cicCartuja publica un estudio en Nature Communications que muestra la implicación de una proteína para la recuperación del flujo sanguíneo tras sufrir una isquemia

Jue, 27/07/2023 - 13:17 | dircom6
Un estudio abre nuevas posibilidades para el diagnóstico y tratamiento de un tipo de hemorragia cerebral
Un estudio descubre que las lipoproteínas de alta densidad (HDL) podrían constituir una nueva diana terapéutica para la hemorragia subaracnoidea aneurismática (HSAa). Los resultados del estudio podrían conducir al desarrollo de nuevas terapias para la HSAa, que es una de las principales causas de muerte y discapacidad por accidente cerebrovascular

Mié, 26/07/2023 - 12:26 | dircom6
Las interacciones indirectas entre especies también influyen en su adaptación al medio natural
Un equipo internacional con participación de la Universidad de Sevilla analiza por primera vez la importancia de las relaciones indirectas de una red natural para la conservación de las especies. La pérdida de biodiversidad y de interacciones, tanto directas como indirectas, tienen consecuencias ecológicas y también evolutivas

Mié, 26/07/2023 - 12:12 | dircom6
La asociación entre algas y cianobacterias, una simbiosis esencial en los océanos
Las algas diatomeas son responsables de una quinta parte de la fotosíntesis global. Las cianobacterias que viven en el interior del alga fijan mucho más nitrógeno que las de vida libre

Mar, 25/07/2023 - 14:55 | dircom2
La Agencia Espacial Europea elige a la US para analizar el estrés que limita la producción agrícola
Es uno de los tres proyectos financiados sobre agricultura a nivel mundial y responde a la emergencia por el cambio climático, en un contexto de crisis alimentaria motivada por la guerra de Ucrania y el aumento de los precios.

Vie, 21/07/2023 - 10:20 | dircom2
AENA lanza una convocatoria de ayudas para impulsar proyectos de investigación en el ámbito aeroportuario
Los beneficiarios serán grupos, equipos o departamentos de investigación relacionados con la sostenibilidad social y ambiental y la transformación sostenible del transporte aéreo

Jue, 20/07/2023 - 14:31 | dircom7
La US participa en un proyecto que usa la IA para detectar el punto óptimo del aguacate
El proyecto de I+D+i Arpodes desarrolla una tecnología autónoma y no intrusiva para ayudar a los productores a llevar el aguacate, del que Andalucía produce el 70% de toda Europa, al punto de venta en el momento óptimo

Mié, 19/07/2023 - 11:30 | dircom7
Descubren huellas de aves raptoras del Pleistoceno en el suroeste de Europa
Los científicos, entre los que participa el profesor Fernando Muñiz de la US, atribuyen a los espectaculares rastros hallados comportamientos similares al de la grajilla occidental y el gran búho real

Mar, 18/07/2023 - 11:37 | dircom7
Diseñan una parada de autobús bioclimática que reduce hasta 20 grados la temperatura en su interior
El objetivo de esta estructura es lograr un refugio climático donde los tiempos de espera sean más cómodos y agradables para el usuario durante las épocas de calor extremo. El primer prototipo se instalará en Sevilla y estará operativo a partir de 2024

Vie, 14/07/2023 - 14:19 | dircom7
El CSIC y la US colaboran en un proyecto para mejorar el tratamiento del cáncer
El proyecto, dotado con 2,7 millones de euros por la Unión Europea, permitirá desarrollar nuevos tratamientos que superen la inherente heterogeneidad del cáncer

Jue, 13/07/2023 - 14:18 | dircom2
Investigadores del IBIS y el Virgen del Rocío utilizan cultivo en 3D para determinar la agresividad del sarcoma más frecuente en la infancia
La enfermedad tiene una tasa de supervivencia inferior al 20%
Vie, 07/07/2023 - 13:12 | dircom2
Un nuevo estudio abre la puerta a diferenciar mejor el alzhéimer de otras demencias
Gracias a este hallazgo del IBIS, podría diagnosticarse antes y con más precisión, mediante técnicas de imagen, enfermedades que a menudo se confunden con el alzhéimer, permitiendo un tratamiento más personalizado y eficaz

Mié, 05/07/2023 - 12:08 | dircom7
Una investigación de la Universidad de Sevilla revela la existencia de mujeres líderes en la Edad del Cobre
El trabajo muestra que el sujeto más destacado de este periodo en la península ibérica fue una mujer a la que el equipo investigador ha bautizado como 'La Señora del Marfil'
Mar, 04/07/2023 - 10:45 | dircom6
HASER se posiciona como Q2 en el último ránking de JCR (Clarivate)
Esta revista internacional se convierte en la primera revista académica internacional sobre Filosofía Aplicada y Filosofía para Niños

Mar, 27/06/2023 - 12:08 | jensenort
El grupo Cármides de la US realiza un estudio sobre bienestar psicológico en el trabajo
El estudio, liderado por el investigador José María León-Pérez determina que el 11,2% de los trabajadores en España está en riesgo elevado de sufrir acoso laboral. Los trabajadores con mayor probabilidad de sufrir acoso tienen casi cinco veces más probabilidades de desarrollar un trastorno de ansiedad generalizada

Mar, 27/06/2023 - 11:00 | dircom7
Investigadores de la US y la UCA hallan una nueva molécula que mejora la memoria
Este compuesto, que deriva de una planta, puede ser suministrado por vía intranasal, como se recoge en el estudio publicado en la revista Aging Cell

Jue, 15/06/2023 - 13:54 | dircom7
Un estudio muestra el uso de unos marcadores del hígado como prueba para la detección de la Esteatosis hepática Metabólica
El estudio, publicado en la revista Liver International, ha sido seleccionado como lo mejor del Congreso Americano para el Estudio del Hígado

Jue, 15/06/2023 - 11:33 | mangalgor
Dos profesores de la US desarrollan un sistema para localizar vehículos con más precisión
Este trabajo valida un algoritmo que mejora la eficiencia y que tiene aplicaciones en campos como los transportes, la navegación o el rescate
Mié, 14/06/2023 - 08:41 | adminUS
Foro europeo sobre apoyo familiar 'Creando una Agenda para 2030'
EurofamNet organiza un foro europeo en Madrid con investigadores, responsables políticos y representantes del tercer sector

Vie, 09/06/2023 - 11:27 | dircom7
Una app ofrece consejos para prevenir la obesidad
'Saibi Educa' es una aplicación de la US y el Distrito Sanitario de Sevilla que acaba de ser premiada por prevenir la obesidad a través de la alimentación saludable y la práctica de deporte

Mié, 07/06/2023 - 11:48 | dircom7
Una investigación del IBiS descubre una proteína clave en el desarrollo del párkinson
El estudio del Instituto de Biomedicina de Sevilla abre la puerta a nuevas posibilidades en el manejo, mitigación y tratamiento de la enfermedad de Parkinson

Mar, 06/06/2023 - 09:45 | mangalgor
El doctor por la US Alberto Martín López es reconocido por la SCIE como investigador joven
La Sociedad Científica Informática de España le concede esta distinción en la edición 2023 de los premios que concede junto con la Fundación BBVA

Mié, 31/05/2023 - 14:04 | dircom7
La US se posiciona como referente en el desarrollo de herramientas TIC
El Instituto de Microelectrónica de Sevilla (IMSE) presentará los resultados del proyecto SPIRS sobre seguridad de los sistemas de comunicación y tecnologías de la información

Mié, 31/05/2023 - 10:52 | dircom7
Un ensayo del IBiS determina la pauta óptima de revacunación contra la hepatitis B
Investigadores del Instituto de Biomedicina de Sevilla (IBiS) y del Hospital Virgen del Rocío (HUVR) han consolidado la recomendación de revacunar frente a la hepatitis B a los pacientes con cirrosis

Lun, 29/05/2023 - 13:45 | jensenort
Hada Sánchez, docente de la FCom, presenta su libro 'Estrategias del periodismo en la esfera digital'
La profesora realiza un profundo análisis sobre las estrategias comunicativas que emplean los medios de comunicación en el contexto de la digitalización y resalta la importancia de la formación de los futuros periodistas en esta materia

Mié, 24/05/2023 - 09:09 | adminUS
El proyecto MicroMundo@Sevilla acerca la Microbiología a los jóvenes de la provincia
Mediante actividades prácticas y divulgativas pretenden concienciar sobre el uso racional de medicamentos y activar el interés por la ciencia

Lun, 15/05/2023 - 11:00 | dircom2
La US organiza el Congreso Internacional de Neandertales que reúne por primera vez a 40 investigadores punteros
Analizarán la huella de nuestros ancestros europeos en la península ibérica, donde se han documentado algunas de las últimas poblaciones de Europa y Asia

Jue, 11/05/2023 - 13:38 | dircom7
Una investigación liderada por la US y el IBiS identifica un nuevo tipo celular clave en el desarrollo de la memoria y aprendizaje
El estudio revela un nuevo tipo celular que está involucrado en muchas funciones importantes del cerebro durante el desarrollo posnatal temprano
Mar, 09/05/2023 - 13:42 | mangalgor
La docente de la US Ana Cristina Gallego, finalista del Premio Nacional del Derecho a la Salud
Gallego es también secretaria del IEAL, que ha desarrollado una ingente labor investigadora y divulgadora durante la pandemia de la COVID-19

Vie, 05/05/2023 - 10:32 | mangalgor
Dos jóvenes investigadoras de la US reciben un premio en las categorías pre y posdoctoral
Rocío Cáceres y María del Carmen Torrejón han sido reconocidas por la Sociedad Científica para el Estudio del Alcohol, las Drogas y las Otras Toxicomanías

Jue, 04/05/2023 - 12:02 | adminUS
Mejoran la resolución de problemas en el control de plantas termosolares con inteligencia artificial
Un equipo de investigación de la Universidad de Sevilla ha aplicado un modelo basado en coaliciones que reduce el tiempo de cómputo en la resolución de problemas de un tipo de colectores solares. El método propuesto permite minorar los fallos y predecir con mayor precisión las necesidades de configuración para obtener un mayor rendimiento de los sistemas

Mié, 03/05/2023 - 09:21 | adminUS
Investigadores de universidades iberoamericanas idean una plataforma de estudio de los paisajes históricos de la producción
La US ha organizado un seminario celebrado en la ciudad de São Paulo junto a universidades brasileñas, además de un taller experimental

Mié, 19/04/2023 - 15:36 | dircom2
10 investigadores de la US integran la exposición que divulga la ciencia en la avenida de la Constitución
“Es un orgullo que ciudadanos y visitantes vean que Sevilla valora la ciencia y nos pone cara”

Mar, 18/04/2023 - 09:01 | dircom7
¿Abrazar la tradición frente a los peligros? Nuevo estudio internacional en el que participa la US
Los resultados de esta investigación, liderada por la UCLA (Universidad de California), podrían ser útiles para la comunicación sobre medidas de salud ante próximas pandemias

Lun, 17/04/2023 - 14:14 | dircom6
Rocío de Diego gana el 43º Certamen Nacional de Investigación en Enfermería San Juan de Dios
En su evaluación, se ha tenido en especial consideración el interés científico del contenido, la originalidad, el valor de la investigación, así como las posibilidades de aplicación

Vie, 31/03/2023 - 11:04 | adminUS
La US lidera un proyecto internacional clave para descarbonizar la edificación
El objetivo del proyecto es superar la barrera más común a la hora de elaborar políticas que garanticen una construcción climáticamente neutra: la falta de datos fiables e integrales

Lun, 27/03/2023 - 11:34 | adminUS
Investigadores de la US profundizan en los mecanismos de la paraplejia espástica hereditaria
Los resultados del estudio sugieren un posible origen de la enfermedad, que se caracteriza por síntomas como espasticidad, parálisis y/o falta de sensibilidad en las piernas

Jue, 23/03/2023 - 11:46 | adminUS
Una investigación sevillana describe las claves de riesgo de infección por enterobacterias multirresistentes en pacientes
Coordinado por el grupo investigador del Hospital Macarena, la Universidad de Sevilla y el IBiS ha sido publicado en eClinicalMedicine, con la participación de 50 hospitales europeos de 10 países con alta incidencia de estos patógenos

Mié, 22/03/2023 - 13:12 | adminUS
Un estudio acota los riesgos asociados al cambio estacional de la hora
Investigadores de la Universidad de Sevilla y la Universidad de Santiago de Compostela estudian cómo se ve afectada la salud la semana posterior al cambio horario

Mié, 22/03/2023 - 08:54 | adminUS
Nuevo estudio sobre el ‘tsunami’ de las nubes de Venus
Expertos de las universidades de Sevilla y del País Vasco creen que la discontinuidad puede estar jugando un papel muy relevante en la aceleración de atmósfera de este planeta

Mar, 21/03/2023 - 12:26 | adminUS
Celebrada la primera conferencia del 'Aula Proyectos de Ingeniería en Acción'
La Cátedra GOYA - Antonio Unanue ha comenzado un ciclo de conferencias como una de sus primeras actividades

Mar, 21/03/2023 - 11:45 | adminUS
Un estudio esclarece la relación entre la respuesta inflamatoria periférica y la enfermedad de Parkinson
Un equipo del IBiS desvela aspectos relevantes en el desarrollo de la conocida como respuesta inflamatoria inmunitaria periférica y apunta a la importancia de las variantes genéticas en desarrollo de la enfermedad
Mar, 21/03/2023 - 11:07 | adminUS
La profesora Eva Bravo, Scientific Advisory Board del Center for Ibero-American Studies
El HCIAS es una de las instituciones científicas centrales de la germana Universidad de Heidelberg

Lun, 20/03/2023 - 12:17 | dircom6
La US participa en un proyecto europeo que estudiará los riesgos y condiciones que sitúan a los llamados "cuidadores" en posiciones vulnerables
CARE4CARE incidará además en su percepción en el mercado laboral dentro de seis Estados miembros de la UE: Francia, Alemania, Italia, Polonia, España y Suecia

Jue, 16/03/2023 - 11:02 | adminUS
Investigadores promueven la creación de una sociedad científica de criobiología
SECrio es la sociedad científica que acogerá a especialistas en el ámbito de la criobiología en España
Mié, 15/03/2023 - 15:58 | dircom6
La Facultad de Filología participa en el proyecto de igualdad 'Merezco una calle' de realidad virtual
El objetivo es reconocer y poner en valor la aportación de las mujeres reales en los callejeros de los municipios e incrementar la presencia de mujeres en el callejero de los municipios
Mié, 15/03/2023 - 12:43 | dircom7
Una ventana hacia el universo
Nace la Red Iberoamericana asociada a la Red Internacional de Investigación en Astrofísica Nuclear
Mar, 14/03/2023 - 13:25 | dircom7
Resumen sobre el estudio y representación de Pi, su segunda potencia y sus aplicaciones
Este estudio tiene potenciales aplicaciones en arqueología, astronomía o biotecnología, así como en la construcción de túneles

Mar, 14/03/2023 - 11:55 | adminUS
EurofamNet presenta en Bruselas mensajes clave en la provisión de apoyo familiar
Desde el proyecto se trabaja en establecer una red paneuropea que afronte algunos de los retos actuales en investigación

Vie, 10/03/2023 - 11:11 | dircom2
La Cátedra Metropol-Parasol presenta dos estudios sobre el impacto económico-social y de imagen de Setas de Sevilla
El impacto económico total de la obra durante su proceso de edificación fue de 154M€, es decir, cada euro público invertido en la construcción ha generado otro más adicional en la ciudad.

Jue, 09/03/2023 - 13:36 | dircom7
Físicos españoles discrepan con la Sociedad del Sueño y defienden el cambio de hora en Estados Unidos
Los profesores José María Martín Olalla, de la Universidad de Sevilla, y Jorge Mira Pérez, de la Universidad de Santiago de Compostela, cuestionan el manifiesto difundido por la Sleep Research Society en el que se defiende la adopción del horario de invierno de forma permanente

Jue, 23/02/2023 - 12:55 | dircom2
La revista Araucaria, evaluada como publicación A1 por el portal brasileño CAPES
Esta publicación, que cumple 25 años, se centra en las ciencias sociales y humanidades en el ámbito de la sociedad e historia iberoamericanas

Jue, 23/02/2023 - 12:29 | dircom7
Los beneficios del aceite de oliva para la salud y el bienestar
El ácido oleico, principal componente del aceite de oliva, ofrece propiedades que ayudan a prevenir el cáncer, el Alzheimer o reducir el colesterol

Mar, 21/02/2023 - 12:24 | dircom2
El proyecto de la US Fusion2Grid ve la luz con la presentación del tokamak SMART
Con este proyecto, investigadores de la Universidad de Sevilla se proponen hacer realidad la fusión como fuente de energía comercial en la próxima década.

Lun, 20/02/2023 - 11:13 | dircom7
La inhibición de una proteína palía el deterioro neuronal asociado al Alzheimer
Un estudio internacional en el que participan investigadores de la US identifica el papel de la proteína Gal-3 en el deterioro neuronal y de las oscilaciones gamma del hipocampo, estructura involucrada en el aprendizaje y la memoria
Mar, 14/02/2023 - 13:34 | dircom6
Llamada a artículos, artículos visuales y reseñas para la revista Astrágalo
Esta revista de la US busca contribuciones bajo el tema 'CIUDAD, GÉNERO Y CUIDADO'

Mar, 14/02/2023 - 13:26 | dircom6
Un grupo de la ETSIE realiza la digitalización completa del manto procesional de la Virgen del Socorro
Esta obra de la Hermandad del Amor se ha recreado en 3D
Mar, 14/02/2023 - 12:39 | dircom6
Jose Candón-Mena coordina el monográfico 'Deliberación democrática en la Red: del diálogo al ruido digital'
El monográfico ha sido publicado en la revista Teknokultura

Vie, 03/02/2023 - 12:23 | adminUS
La US participa en un proyecto de tecnología de hidrógeno y energías renovables
El proyecto AD-GRHID, aprobado recientemente por la Corporación Tecnológica de Andalucía, es una plataforma de gestión avanzada para la interoperabilidad de hidrógeno y energías renovables

Jue, 02/02/2023 - 09:51 | dircom2
Nueva monografía con importantes descubrimientos sobre el dolmen de Menga
En esta obra se presenta un completo estudio científico del registro obtenido en las excavaciones arqueológicas llevadas a cabo en Menga entre octubre de 2005 y febrero de 2006, y que permanecían casi completamente inéditas

Jue, 26/01/2023 - 08:36 | dircom7
El IMSE diseña circuitos integrados que son clave para comprender la climatología en Marte
Estos circuitos son fruto de décadas de estudios relacionados con la radiación espacial y bajas temperaturas marcianas
Mié, 25/01/2023 - 08:42 | adminUS
SingulaCity, entre los ganadores del Climate Smart Cities Challenge
La propuesta se integra en Green Routes, consorcio de empresas que se hicieron con el premio final

Mar, 24/01/2023 - 10:57 | dircom7
Elio Antonio de Nebrija: de referente académico a objeto de burla
Una de las obras más populares del gramático español fue usada como objeto de burla en una sátira del matrimonio apenas un siglo después de su muerte

Lun, 23/01/2023 - 12:01 | mangalgor
Los investigadores de la US reciben herramientas para difundir su actividad en redes sociales
La Dirección General de Comunicación les dota de recomendaciones, material gráfico y ofrecerá cursos especializados para que puedan amplificar los resultados de sus trabajos

Vie, 20/01/2023 - 11:11 | dircom2
Una investigación rastrea la huella urbana de los ritos de la ciudad del siglo XIII al XIX
El arquitecto javier Navarro dibuja en este trabajo los relatos de cuatro cronistas: Diego Ortiz de Zúñiga, Justino Matute y Gaviria, José Velázquez y Sánchez y Alejando Guichot y Sierra.

Mar, 17/01/2023 - 10:59 | dircom7
La paradoja de Leonardo da Vinci resuelta
Dos investigadores de la Universidad de Sevilla y la Universidad de Bristol resuelven esta incógnita sobre la inestabilidad de la trayectoria de una burbuja de aire que asciende en el agua

Mar, 10/01/2023 - 12:18 | dircom6
Investigan la resistencia de las plantas a los cambios del clima pasados y sus patrones actuales de diversidad
Un equipo de investigación de la US presenta un documental con los planteamientos, objetivos y resultados de este proyecto

Lun, 09/01/2023 - 12:38 | dircom7
Investigadores del IBiS y CNB demuestran que una vacuna del CSIC contra la COVID-19 protege de la infección y el daño cerebral causado por el virus
El estudio, que se publica en la prestigiosa revista Nature Neuroscience, ha sido realizado por investigadores españoles del Instituto de Biomedicina de Sevilla (IBiS, Hospital Universitario Virgen del Rocío/CSIC/Universidad de Sevilla) y del Centro Nacional de Biotecnología (CNB-CSIC)

Lun, 09/01/2023 - 12:19 | dircom6
Premio para los avances en la cadena de suministro
El proyecto COHESION, desarrollado en HEINEKEN ESPAÑA con la colaboración de un grupo de investigación de la ETSI, ha sido galardonado en los premios CEL (Centro Español de Logística) 2022

Lun, 09/01/2023 - 11:42 | dircom6
¿Quieres un proyecto europeo? Consíguelo con el Programa Erasmus +
La convocatoria de propuestas 2023 del programa Erasmus+ cuenta con un presupuesto de más de 3.300 millones de euros

Mié, 21/12/2022 - 09:23 | dircom6
Los efectos de la separación de la madre con cesárea y su recién nacido
Una tesis estudia los efectos que tiene la separación de la madre con cesárea y su recién nacido al no realizar contacto piel con piel
Lun, 19/12/2022 - 10:50 | dircom6
Llamada a capítulos para el monográfico 'Sostenibilidad de los medios en la era digital: economía política de los medios públicos, privados y comunitarios'
Se podrán enviar hasta el 30 de diciembre de 2022

Jue, 15/12/2022 - 12:29 | dircom6
Realidades híbridas en el periodismo y la comunicación
Profesores del Grupo de Investigación de Análisis y Técnica de la Información (GIATI) de la Universidad de Sevilla publican un libro sobre la digitalización y los espacios inmersivos del periodismo
Mié, 14/12/2022 - 10:03 | dircom6
Comunicación estratégica para el ejercicio del liderazgo femenino
La catedrática de la US Catalina Fuentes, junto con la profesora de la Universidad de Córdoba Ester Brenes, publica este volumen sobre análisis del discurso y la lingüística de género

Mié, 14/12/2022 - 09:53 | adminUS
La profesora Eleonora Viezzer recibe el Premio Investigador Joven en Física Experimental
La egresada de la US Carolina Clavijo ha sido galardonada con el Premio Enseñanza y Divulgación de la Física. La Real Sociedad Española de Física (RSEF) y la Fundación BBVA reconocen la creatividad, el esfuerzo y el logro en el campo de la física para servir así de estímulo a los profesionales que desarrollan su labor en la investigación

Vie, 09/12/2022 - 10:11 | dircom2
La US sede en el lanzamiento del proyecto CEEGS
La Escuela Técnica Superior de la Universidad de Sevilla ha sido sede de la reunión de expertos europeos para el lanzamiento de esta iniciativa sobre un novedoso sistema de almacenamiento de energía renovable.

Mar, 29/11/2022 - 12:00 | dircom6
'Creatividad en acción' presenta seis vídeos de profesionales de la comunicación publicitaria
El proyecto presenta los cambios producidos en los últimos tiempos en los perfiles profesionales relacionados con la creatividad publicitaria

Lun, 28/11/2022 - 12:53 | adminUS
La vivienda colaborativa en una era de pandemia
Investigadores de las universidades de Sevilla, Lund, Lyon, Técnica de Viena y Tampere se reúnen para abordar los beneficios de la vivienda colaborativa

Vie, 25/11/2022 - 12:09 | dircom6
Publicado el segundo número de la Revista ADyC de Arte, Diseño y Comunicación
La revista #RevADyC nace al amparo del grupo de investigación HUM337 bajo la dirección de Manuel Fernando Mancera Martínez, y con artículos de profesionales y trabajos de investigación de alumnos destacados junto a egresados como referencia

Mié, 23/11/2022 - 10:50 | dircom7
Un nuevo vídeo recrea la desaparecida Puerta de Triana en Sevilla
Sus autores tratan de valorar y reconstruir un importante patrimonio demolido en 1868

Vie, 18/11/2022 - 12:00 | dircom6
La violencia de género en jóvenes y adolescentes
Un nuevo libro de la Editorial US, elaborado por investigadores de la propia Universidad, pone el foco en este segmento de la población

Mié, 16/11/2022 - 13:39 | dircom7
Once investigadores de la US entre los protagonistas de la exposición ‘Sevilla también es ciencia’
La iniciativa trata de acercar a la ciudadanía la labor del personal investigador que trabaja en Sevilla

Mié, 16/11/2022 - 12:32 | dircom7
Tres estudiantes de la US reciben los premios a las mejores Tesis en Química de Andalucía Occidental
La sección territorial de la Real Sociedad Española de Química entrega sus galardones en un acto que se celebrará en la Facultad de Química de la US

Mié, 16/11/2022 - 12:24 | adminUS
El IBiS reúne a 300 jóvenes investigadores internacionales
El congreso FEBS - IUBMB – ENABLE promueve la excelencia en las ciencias biomédicas a nivel internacional apoyando a jóvenes investigadores e investigadoras, fortaleciendo carreras científicas y acercando la biomedicina a la sociedad

Mar, 15/11/2022 - 11:01 | adminUS
La US participa en un consorcio europeo para potenciar doctorados de jóvenes investigador y proyectos de investigación
La Universidad de Sevilla, CTA, Flying Robotic Solutions S.L. y el Centro Avanzado de Tecnologías Aeroespaciales (CATEC) son los miembros españoles que forman parte de este consorcio europeo

Jue, 10/11/2022 - 11:34 | dircom2
La US entrega dos banderas del sindicato de cigarreras en el IAPH
El IAPH realizará un informe sobre el estado de conservación y un presupuesto para su restauración

Mié, 09/11/2022 - 12:03 | dircom2
La US reconoce a cinco de sus mejores investigadores con el Premio Fama
Estos galardones reconocen cada año la labor de cinco investigadores, uno por cada uno de las grandes áreas de conocimiento.

Mar, 08/11/2022 - 08:54 | adminUS
Ana Romera recibe el premio a la mejor tesis otorgado por la AJIHLE
La investigadora recibe el reconocimiento de la Asociación de Jóvenes Investigadores en Historiografía e Historia de la Lengua Española

Mié, 02/11/2022 - 13:16 | adminUS
Desarrollan modelos de simulación junto con Mevea bajo el proyecto europeo THREAD
El grupo de investigación de Ingeniería Mecánica de la US colabora con la empresa finlandesa de alta tecnología

Mié, 02/11/2022 - 12:17 | dircom7
La US, tercera universidad española en captación de fondos y proyectos dentro Plan Estatal de Investigación
En otras convocatorias de investigación a nivel andaluz también se sitúa en las primeras posiciones, con una financiación de más de 15 millones de euros

Lun, 31/10/2022 - 10:10 | adminUS
Investigadores de la US, premiados con el Best Student Paper del congreso BPM
El estudio, reconocido a nivel internacional, trata sobre cómo los analistas de procesos aplican técnicas de análisis de datos para resolver problemas reales

Mié, 26/10/2022 - 13:40 | dircom6
Las 'Orlas Siglo XXI' de la Facultad de Bellas Artes llegan a la vida real
Este proyecto virtual, nacido en el curso 2017-2018, decora actualmente la cafetería del centro

Mié, 26/10/2022 - 10:15 | adminUS
Comienza la construcción de TARSIS, el instrumento de próxima generación para el telescopio de 3.5 metros de Calar Alto
La Universidad de Sevilla participa en este proyecto, que presenta características únicas al poder detectar luz en el ultravioleta cercano y un campo de visión sin precedentes

Vie, 21/10/2022 - 11:35 | dircom7
Un profesor de la US, reconocido por la American Physical Society por sus contribuciones a la Física
En la última década ningún profesor español ha recibido este reconocimiento en el área de Mecánica de Fluidos

Vie, 21/10/2022 - 07:44 | dircom2
El consejero de Política Industrial valora el Puerto como núcleo de actividad industrial
El rector de la US ha destacado la estrecha colaboración con la APS y las empresas de base industrial en proyectos como el Centro Universitario de Innovación del Puerto de Sevilla y el Programa de Emprendimiento Tecnológico.

Mar, 18/10/2022 - 09:49 | adminUS
La investigadora Isabel Corrales, reconocida en los Premios San Lucas 2022
El Colegio de Médicos recupera la tradicional celebración de San Lucas destacando la importancia de la investigación médica-científica
Lun, 17/10/2022 - 09:19 | adminUS
Llamada a capítulos para el monográfico 'Sostenibilidad de los medios en la era digital'
El plazo para el envío de resúmenes se extiende hasta el 30 de diciembre, estando prevista la publicación para 2023
Mar, 11/10/2022 - 09:07 | dircom7
Estudiantes de doctorado en Física realizan experimentos con neutrones
El Centro Nacional de Aceleradores (CNA) ha organizado una formación donde estudiantes e investigadores de más de 10 ciudades europeas han podido realizar experimentos con neutrones en la instalación HISPANOS

Vie, 07/10/2022 - 09:33 | adminUS
Técnicas de inteligencia artificial frente al hígado graso no alcohólico
Una alianza estratégica con la empresa americana PharmaNest y los grupos de investigación del IBiS y CiberEHD hacen posible este programa, en el que participarán más de 600 pacientes del Hospital Virgen del Rocío
Mié, 05/10/2022 - 17:03 | adminUS
Investigadores de la US consiguen el Premio al Artículo Distinguido en la ESEC/FSE
Con este trabajo proponen un método de pruebas automatizadas que permite detectar errores en aplicaciones tan populares como YouTube, Spotify o Yelp
Mié, 05/10/2022 - 11:56 | adminUS
Fátima León, galardonada con el Premio Nacional en Anticoncepción
La profesora del departamento de Enfermería recibe el reconocimiento por su trabajo sobre el acceso de las mujeres a los servicios de salud sexual y reproductiva durante el confinamiento

Mar, 04/10/2022 - 14:26 | dircom7
El Istmo de Tehuantepec, paso interoceánico en el siglo XVI
Demuestran con métodos cartográficos que la región del Istmo de Tehuantepec (México) se utilizó como paso interoceánico en el siglo XVI

Mar, 04/10/2022 - 12:11 | dircom7
Un proyecto de 'agromonitorización' para lograr un cultivo de arroz más sostenible
El proyecto SAMA, en el que participa la Universidad de Sevilla, aplica imágenes satelitales para un cultivo de arroz más sostenible en Sevilla y Cádiz

Mar, 04/10/2022 - 11:04 | dircom6
Los 500 años de Nebrija, en metaverso
Podrán conocer hasta final de año, con su respectivo avatar, las acciones desarrolladas en torno a la figura de Nebrija

Vie, 30/09/2022 - 11:18 | dircom7
La US participa en EERES4WATER, el proyecto europeo sobre agua y energía
El proyecto EERES4WATER ha contribuido a facilitar a los ciudadanos un acceso al agua más barato y sostenible en el Espacio Atlántico

Jue, 29/09/2022 - 10:29 | adminUS
Investigadores del IBiS describen el mecanismo mediante el que se detecta el oxígeno de la sangre
El trabajo desarrollado en el IBiS con colaboración internacional ha sido co-dirigido por el José López Barneo, Patricia Ortega y Daniel Cabello. Los autores principales son investigadores del IBiS y miembros del Departamento de Fisiología Médica y Biofísica de la Facultad de Medicina de Sevilla

Mié, 28/09/2022 - 10:54 | dircom7
La Noche Europea de l@s Investigador@s trae a Sevilla más de un centenar actividades
Más de 300 investigadores e investigadoras compartirán sus conocimientos con la ciudadanía en actividades presenciales

Mié, 28/09/2022 - 10:46 | adminUS
La molécula del origen de la vida, clave en la investigación contra el cáncer
Investigadores en España y Dinamarca encuentran en la producción de una de las moléculas del origen de la vida, una forma de atacar a las células del cáncer

Lun, 26/09/2022 - 12:13 | dircom7
Desarrollan una nueva tecnología para prevenir obstrucciones en catéteres de pacientes con hidrocefalia
Permitiría el tratamiento preventivo de una frecuente complicación que afecta aproximadamente a 8.000 personas solo en Andalucía

Vie, 23/09/2022 - 13:01 | dircom2
Margarita Robles clausura unas jornadas sobre legislación y conflictos armados
La ministra de Defensa, Margarita Robles, ha clausurado las jornadas “Los nuevos conflictos armados ante los nuevos medios y métodos de combate”, organizadas por el grupo de investigación 'Política y Derecho Internacional' con la financiación del Ministerio de Defensa.
Mié, 21/09/2022 - 11:17 | jensenort
Profesorado de la FCom coordinará un proyecto de innovación docente sobre los medios del Tercer Sector de la Comunicación
El propósito principal del proyecto es mejorar la formación de los estudiantes de la Facultad de Comunicación de la US a través de la metodología didáctica del Aprendizaje de Servicio
Mar, 20/09/2022 - 11:27 | adminUS
Becas JAE 2022 de introducción a la investigación en inteligencia artificial
Se ofertan dos becas en el Instituto de Microelectrónica de Sevilla, un instituto de investigación mixto US-CSIC

Mar, 20/09/2022 - 10:54 | dircom7
El investigador de la US Andrés Aguilera recibe 500.000€ para su estudio sobre el cáncer
Su proyecto tiene como objetivo comprender el papel de los nuevos factores que provocan inestabilidad genómica en esta enfermedad

Lun, 19/09/2022 - 12:42 | dircom7
Casi 3.000 científicos acercarán la ciencia a la ciudadanía en la Noche Europea de Los Investigadores
Darán a conocer su trabajo el próximo 30 de septiembre a través de más de 800 actividades programadas en las calles de las ocho provincias de Andalucía

Mar, 13/09/2022 - 14:01 | adminUS
Profesores de la US reciben el premio a la mejor ponencia de aplicación de PLS-SEM
Sostienen que la economía circular es uno de los enfoques más recientes para abordar los retos de sostenibilidad a los que se enfrentan las sociedades actuales

Mar, 06/09/2022 - 12:45 | adminUS
La ministra de Ciencia e Innovación visita la US
Diana Morant participa en la Universidad de Sevilla en una jornada de trabajo de las Instalaciones Científico-Técnicas Singulares de España

Mar, 30/08/2022 - 13:07 | adminUS
Investigadoras de la US crean una herramienta para cuantificar el papel de los océanos como pulmones de la Tierra
La investigación compila datos que permiten analizar el ciclo del carbono en los océanos del último medio siglo

Mar, 23/08/2022 - 12:24 | dircom2
La generación de nuevas especies a partir de cromosomas holocéntricos
En el artículo, publicado en la revista Trends in Ecology and Evolution, los investigadores argumentan que los individuos con diferentes citotipos son capaces de aparearse entre sí. Esto convierte a los organismos con cromosomas holocéntricos en organismos modelo para estudiar procesos de evolución y especiación cromosomática.

Vie, 12/08/2022 - 10:50 | dircom7
En busca de nuevas chaperonas farmacológicas para tratar la enfermedad de Fabry
La US firma un acuerdo con el CSIC y la farmacéutica Amicus Therapeutics desarrollar medicamentos que ayuden a contrarrestar esta patología

Mar, 09/08/2022 - 11:55 | dircom7
Una plataforma permite calcular automáticamente las equivalencias de dosis en psicofármacos
La herramienta convierte de manera rápida y sencilla la dosis de cualquier tratamiento con psicotrópicos en dosis mili-equivalentes de gold-estándars

Jue, 04/08/2022 - 11:20 | dircom2
La inflamación del colon puede ser un factor de riesgo en el desarrollo de algunas patologías
Investigadores de la US y la UCA concluyen que una inflamación intestinal aguda produce neuroinflamación e hiperexcitabilidad en la corteza motora y altera la coordinación motora

Lun, 01/08/2022 - 12:04 | dircom7
Un nuevo método para detectar el ibuprofeno en mejillones
Además de evaluar las condiciones del animal, la nueva herramienta permite conocer los niveles de contaminación de las aguas a causa de este medicamento

Mar, 26/07/2022 - 11:27 | adminUS
Los eventos de mortalidad masiva por olas de calor marinas podrían ser la nueva normalidad en el Mediterráneo
La US participa en un estudio que prueba que entre los años 2015 y 2019, estos eventos afectaron a toda la cuenca mediterránea

Vie, 22/07/2022 - 12:59 | dircom2
US, Puerto de Sevilla y Junta de Andalucía presentan el edificio del Centro de Innovación
El objetivo principal de este proyecto es la construcción y operación de un Centro de Innovación conjunto de las Universidades de Sevilla, Algarve y Évora, especializado en los campos de Industria 4.0, Logística, Materiales y Sostenibilidad

Mié, 20/07/2022 - 14:34 | dircom6
José Candón consigue financiación para reforzar el Tercer Sector andaluz en comunicación
Jose Candón coordinará el Proyecto de Cooperación 'Fortalecimiento del Tercer Sector andaluz en comunicación, TIC e innovación social mediante el aprendizaje-servicio de mujeres universitarias'
Mié, 20/07/2022 - 10:55 | dircom2
Analizan joyas de oro de los prestigiosos orfebres italianos Castellani
Expertos de la Universidad de Sevilla han comprobado la presencia de cadmio, un metal añadido a las soldaduras de oro a partir del siglo XIX y utilizado a menudo para los estudios de autenticidad

Mar, 19/07/2022 - 11:07 | adminUS
José Luis García León, premio al mejor expediente de Máster Nuclear 2022
La Sociedad Nuclear Española ha concedido este premio a un estudiante del Máster en Física Nuclear de la Universidad de Sevilla 2020-2021

Lun, 18/07/2022 - 12:20 | dircom7
Investigadores de la US diseñan una pila de combustible PEM bioinspirada
Estos dispositivos permiten convertir directamente la energía química de combustibles como el hidrógeno en electricidad

Vie, 15/07/2022 - 13:01 | jensenort
La US lidera un proyecto a favor de la sostenibilidad del cultivo de arroz
El departamento de Geografía Física y Análisis Geográfico Regional de la US dirige el proyecto SAMA que desarrolla una plataforma de agromonitorización de cultivos de arroz en la provincia de Sevilla

Vie, 15/07/2022 - 10:04 | dircom7
Por qué algunas proteínas se pliegan de forma incorrecta y dan lugar al Alzheimer o la diabetes tipo II
Un equipo internacional de investigación, liderado por el Instituto de Biomedicina de Sevilla (IBiS) y la Universidad de Sevilla, aporta nuevos datos sobre el importante papel que juegan las denominadas proteínas ribosómicas durante el proceso celular de traducción

Mié, 13/07/2022 - 14:31 | dircom7
Un nuevo principio matemático explica cómo se conectan las células entre sí para formar tejidos y órganos
Una investigación internacional, liderada por el Instituto de Biomedicina de Sevilla (IBiS) y el Instituto de Biología Integrativa de Sistemas (I2SysBio), desvela importantes propiedades de la conectividad celular

Lun, 11/07/2022 - 10:59 | mangalgor
Científicos de la US describen un nuevo mecanismo de regulación de la degradación y el reciclado de proteínas
La investigación del equipo formado por miembros del Departamento de Genética ha aparecido en la prestigiosa revista 'BMC Biology'

Vie, 08/07/2022 - 13:08 | dircom2
La US obtiene casi 12 millones de euros de fondos para la investigación del Plan Estatal
La Universidad de Sevilla ha obtenido 11’93 millones de euros de financiación para proyectos de investigación procedentes de la convocatoria 2021 del Plan Nacional, concedidos por el Ministerio de Ciencia e Innovación.

Vie, 08/07/2022 - 12:05 | dircom2
Ochenta expertos de veinte de países en un congreso sobre la obra de Emily Dickinson
El encuentro tiene lugar en la Facultad de Filología del 12 al 14 de julio, bajo el nombre ‘Dickinson and Foreignhood’
Lun, 04/07/2022 - 12:27 | dircom2
Expertos de la US confirman una teoría que ya predijo Darwin
Expertos de la US han comprobado los patrones de cruzamiento en Narcissus papyraceus. De la hipótesis de Darwin se deduce que las plantas con órganos sexuales a alturas más similares tendrán más éxito de cruzamiento, es decir, mayor probabilidad de tener descendencia

Vie, 01/07/2022 - 12:46 | dircom7
El ‘Taller de espías’ y el Proyecto CHON ganan los Premios a la Divulgación de la US
Se han concedido los galardones correspondientes a las convocatorias 2020 y 2021

Vie, 01/07/2022 - 11:56 | dircom2
El libro "Sevilla. Historia de su forma urbana", Premio Nacional de Edición Universitaria
Esta obra el resultado del trabajo de un conjunto de investigadores y profesores universitarios que han analizado los cambios urbanísticos producidos en la Sevilla desde diferentes áreas de conocimiento: geografía, historia, arqueología, ecología e historia del arte.

Jue, 30/06/2022 - 12:35 | dircom2
La EUS publica un estudio sobre la música de cine en femenino en la obra de Dimitri Tiomkin
Lucía Pérez García en este estudio, desarrollado para su tesis doctoral, ha puesto en valor el tratamiento musical de la mujer en todas las películas cuya melodía compuso Dimitri Tiomkin, a través de los diferentes géneros cinematográfi cos.

Jue, 30/06/2022 - 12:13 | dircom7
Cuatro investigadores andaluces recogen los X Premios Manuel Losada Villasante
Lino Camprubí Bueno, María Esther Reina Romo, Dolores Fernández Ortuño y Tomás Ramírez Reina han sido los elegidos por el jurado de estos galardones por sus investigaciones sobre geopolítica, ingeniería mecánica, nanotecnología, e hidrógeno verde

Vie, 24/06/2022 - 10:19 | dircom7
Hallan una estela prehistórica en el complejo funerario de Cañaveral de León
Se trata de la segunda estela localizada en este yacimiento, que fue descubierto recientemente gracias a la aparición de una primera estela

Mié, 22/06/2022 - 12:25 | jensenort
Próxima finalización de convocatorias para estancias en la Universidad de Harvard
La US ofrece estancias de investigación y estudios en la Universidad de Harvard para profesores, investigadores, doctorandos y egresados

Mar, 21/06/2022 - 13:21 | dircom7
Un mecanismo controla la correcta distribución de las proteínas en las células
Este hallazgo, realizado por un equipo internacional de científicos y coordinado por el Instituto de Biomedicina de Sevilla (IBiS) y la Universidad de Sevilla, permite entender cómo las células podrían evitar defectos en la distribución de las proteínas, algo que provoca patologías como el cáncer o enfermedades neurológicas, como el Alzheimer o el Parkinson
Lun, 13/06/2022 - 11:41 | mangalgor
El Portal del Investigador de la US se renueva tras un proceso de recepción de sugerencias
Se pone en marcha la aplicación "Datos económicos" y se optimiza el espacio "Reservas de crédito"

Vie, 10/06/2022 - 11:54 | dircom7
Una plataforma de agromonitorización permitirá hacer más sostenibles los cultivos extensivos
El departamento de Geografía Física y Análisis Geográfico Regional de la US lidera el proyecto MoniCa, que desarrolla en Cádiz una plataforma de agromonitorización de cultivos extensivos que aplica IoT, Inteligencia Artificial y datos de satélites para hacer más sostenibles los cultivos extensivos herbáceos en toda la provincia de Cádiz

Mié, 08/06/2022 - 14:12 | adminUS
Premiados tres trabajos de estudiantes de la US en el Certamen Universitario Arquímedes
Las estudiantes María Salas, Nuria Gómez y Carmen Ramírez son las autoras de los trabajos galardonados

Vie, 03/06/2022 - 12:32 | dircom7
Un método innovador para producir microfibras de forma masiva
La nueva técnica permite convertir un volumen de líquido en cientos de miles de microfibras sólidas mediante campos eléctricos

Jue, 02/06/2022 - 16:41 | dircom2
Fallados los Premios Manuel Losada Villasante a la actividad investigadora
Lino Camprubí Bueno, María Esther Reina Romo, Dolores Fernández Ortuño y Tomás Ramírez Reina han sido los elegidos por el jurado de estos galardones por sus investigaciones sobre geopolítica, ingeniería mecánica, nanotecnología, e hidrógeno verde.

Mar, 31/05/2022 - 11:42 | adminUS
Investigadores andaluces crean una herramienta para enseñar la historia de Andalucía en la Edad Moderna
El catedrático de la US Juan José Iglesias coordina este proyecto de investigación con el fin de ofrecer al sistema educativo un instrumento de transferencia útil

Vie, 27/05/2022 - 10:03 | dircom7
Un profesor de la US recibe el Premio Nacional de Informática
La Sociedad Científica Informática de España ha reconocido a Antonio Ruiz por sus contribuciones en el área de la ingeniería de software

Mar, 24/05/2022 - 11:51 | dircom2
La US participa en TARSIS, el futuro instrumento del telescopio de 3,5 m de Calar Alto
La combinación de un amplio campo de visión y una alta sensibilidad, desde el ultravioleta hasta longitudes de onda rojas, hacen de TARSIS un instrumento único

Lun, 23/05/2022 - 13:59 | dircom7
Estudian el diseño de nuevos complejos de plata como alternativa a los antibióticos
Tres departamentos de la Universidad de Sevilla y el Instituto de Investigaciones Químicas colaboran en el análisis de estos compuestos para combatir dos de las bacterias que producen más mortalidad en el ser humano

Lun, 23/05/2022 - 13:50 | dircom6
12 millones de euros para valorizar residuos mineros
La Universidad de Sevilla forma parte del proyecto europeo RAWMINA, cuyo objetivo es extraer valiosas materias primas críticas de los subproductos residuales de la minería
Vie, 20/05/2022 - 12:05 | adminUS
El proyecto de I+D+i PACO y PACA, entre los galardonados con el Premio Estrategia NAOS
La profesora Nuria Castro-Lemus participa como investigadora en el proyecto que ha recibido el premio a la promoción de la práctica de la actividad física en el ámbito escolar

Vie, 20/05/2022 - 09:49 | dircom7
Los Premios cicCartuja-Ebro Foods 2021 reconocen un ganador y tres accésits
Por primera vez en la historia de los Premios, dada la alta calidad de los trabajos, se han concedido tres accésits, uno a cada instituto
Mar, 17/05/2022 - 09:18 | mangalgor
Congreso Internacional 'Cultura de Frontera y Patrimonio'
Se celebrará en modalidad presencial los días 23 y 24 de septiembre en las localidades de Sanlúcar de Guadiana (Huelva) y Alcoutim (Portugal)
Vie, 13/05/2022 - 08:51 | dircom6
Javier García imparte el seminario 'Gestión de activos en un servicio de electromedicina'
Javier García es miembro del Servicio de Electromedicina del Hospital Universitario Virgen del Rocío
Mié, 11/05/2022 - 15:53 | dircom6
Newsletters del proyecto europeo NEWFRAC
Ya se pueden consultar los primeros cuatro boletines de este proyecto europeo coordinado por la US

Mar, 10/05/2022 - 11:56 | dircom7
La US participa en la 20ª Feria de la Ciencia de Sevilla
La cita, que vuelve este año a la modalidad presencial, se desarrollará del 12 al 14 de mayo en el Palacio de Exposiciones y congresos de FIBES y podrá seguirse también online a través de www.feriadelacienciavirtual.org

Mar, 10/05/2022 - 11:50 | jensenort
José Manuel García Arroyo publica 'Psicología para odontólogos'
Esta publicación se centra en divulgar los rasgos y características de personalidad que tienen que conocer los odontólogos para entender a los pacientes de diferentes edades

Mar, 10/05/2022 - 09:04 | dircom7
El daño que el VIH hace en el sistema inmunitario altera el microbioma intestinal
Una investigación llevada a cabo en el Instituto de Biomedicina de Sevilla (IBiS) sugiere que podría mejorarse la recuperación inmunológica de estos pacientes mediante intervenciones que modulen la composición del microbioma, como la dieta, determinados pro y prebióticos o incluso el trasplante de heces. Se daría solución así a un importante reto clínico, debido a la alta tasa de mortalidad que tienen los pacientes con pobre recuperación inmunológica

Jue, 05/05/2022 - 13:08 | dircom7
Dos profesores de la US reciben sendos Premios Nacionales de Investigación 2021
Aníbal Ollero y Montserrat Vilá han recogido sus galardones en un acto celebrado en Barcelona y presidido por los Reyes

Mié, 27/04/2022 - 15:35 | dircom7
La profesora Eleonora Viezzer recibe el premio Princesa de Girona a la Investigación Científica
La investigadora de la US ha sido galardonada por sus trabajos sobre la fusión nuclear

Mar, 26/04/2022 - 12:00 | adminUS
Nueva publicación, 'Mujeres creadoras: dibujo, trazo y discurso'
Las profesoras e investigadores María Aguilar Alejandre y María del Carmen Molina editan el libro publicado por la editorial Comares

Mar, 26/04/2022 - 11:31 | adminUS
El departamento de Fisiología de la Facultad de Farmacia utiliza las redes sociales como un método de innovación docente
Estudiantes, supervisados por profesores, divulgan contenidos sobre fisiología a través de Instagram y YouTube

Jue, 21/04/2022 - 11:11 | dircom7
Investigadores del IBiS detectan patrones inmunitarios asociados a la Covid-19 leve
El Instituto de Biomedicina de Sevilla (IBiS) y los equipos COVID-19 del Hospital Universitario Virgen del Rocío y COHVID-Galicia Sur descifran la calidad de la respuesta de células 'T', específicas del SARS-CoV-2

Mié, 20/04/2022 - 12:27 | mangalgor
Hada Sánchez edita 'La digitalización en el periodismo. Transformación, retos y oportunidades'
La autora, profesora de la FCom, reúne en la obra los trabajos de veintisiete académicos e investigadores de varias universidades
Mar, 19/04/2022 - 13:38 | mangalgor
'Imágenes de la infancia en la Comunicación y la Cultura', nueva publicación de dos profesoras de la FCom
La obra, escrita a cuatro manos por Ángeles Martínez-García y Mar Ramírez, analiza las diversas representaciones de la niñez a lo largo de la historia

Lun, 18/04/2022 - 11:21 | dircom7
Nueva ruta metabólica de control de la calidad de proteínas ancladas a membranas a través de GPI
Los investigadores coordinados por el profesor Goder llevan a cabo desde hace más de 10 años estudios sobre control celular de la calidad de proteínas, cuyos resultados han dado lugar a hallazgos relevantes que son de gran interés e impacto en la comunidad científica, tanto nacional como internacional

Vie, 08/04/2022 - 12:56 | dircom7
La US muestra su potencial investigador ante una delegación europea
Responsables del Joint Research Centre (JRC) de la Comisión Europea y de varias universidades europeas han dialogado sobre las principales líneas de la actividad investigadora de la US y han conocido de primera mano los avances del profesor Aníbal Ollero

Vie, 08/04/2022 - 11:02 | jensenort
Jorge David Fernández, docente de la FCom, presenta Strategic Advertising Mechanisms
Fernández Gómez hace un recorrido por las principales técnicas publicitarias de la historia moderna en su trabajo más reciente, Strategic Advertising Mechanisms

Jue, 07/04/2022 - 09:17 | dircom7
Un estudio de CSIC y US logra mejorar cerámicas al incorporar nanoestructuras de grafeno
El estudio, realizado en su totalidad por investigadoras de la Universidad de Sevilla y del Consejo Superior de Investigaciones Científicas, ha obtenido unos resultados que demuestran que estos materiales con grafeno presentan mayor resistencia al envejecimiento hidrotermal y una alta tolerancia al daño asociado a este envejecimiento

Mar, 05/04/2022 - 12:18 | dircom7
Un paso más en el aprovechamiento de los residuos de la industria del vino
Expertos de la Universidad de Sevilla confirman que en los residuos obtenidos en cada una de las etapas del procesado del orujo existen cantidades considerables de proteínas, fibra y fenoles que no se han extraído totalmente durante el proceso

Lun, 04/04/2022 - 11:45 | adminUS
cicCartuja celebra sus 25 años como uno de los referentes en ciencia de Andalucía
El centro alberga tres institutos de investigación: Instituto de Investigaciones Químicas, Instituto de Bioquímica Vegetal y Fotosíntesis e Instituto de Ciencia de los Materiales de Sevilla

Vie, 01/04/2022 - 09:55 | dircom7
La US supera las 2.600.000 lecturas en The Conversation
El portal de divulgación científica cuenta ya con 116 artículos firmados por investigadores de la Universidad de Sevilla

Vie, 01/04/2022 - 09:47 | dircom6
Un trabajo sobre Fernando de Herrera, premiado como la Mejor Tesis Doctoral en Humanidades Digitales
Laura Hernández Lorenzo se hace con la primera edición de este premio convocado por la Sociedad Internacional de Humanidades Digitales Hispánicas y la Fundación BBVA

Jue, 31/03/2022 - 11:42 | dircom7
El IBiS describe una proteína epigenética asociada al proceso metastásico en Sarcoma de Ewing
La histona metiltransferasa G9a aumenta la probabilidad de desarrollar metástasis en estas neoplasias de hueso o tejidos blandos y su tratamiento con el fármaco BIX01294 podría mejorar el control de la metástasis en pacientes
Mié, 30/03/2022 - 14:00 | dircom7
Una investigación de la US aparece en la portada de ‘Chemistry of materials’
El trabajo analiza las propiedades termodinámicas de una veintena de materiales de la familia de las calcopiritas

Lun, 28/03/2022 - 11:19 | dircom7
Investigadores de la US proponen aumentar la representación en el Congreso hasta 360 diputados
Han estudiado dos modelos compatibles con la Constitución, descartan una ampliación a 400 diputados y sugieren incluso una reducción a 300

Vie, 25/03/2022 - 09:06 | dircom7
Un procedimiento pionero permite tratar los efluentes hospitalarios contaminados con fármacos citostáticos
Esta innovación ha sido desarrollada por el consorcio que integran Athisa Biogeneración, nazaríes y ANQUIMED (Análisis Químico Industrial y Medioambiental de la Universidad de Sevilla)

Vie, 18/03/2022 - 11:08 | dircom7
Los procesos de urbanización modifican las características de algunas especies vegetales
La revista Science publica el trabajo de una investigadora de la Universidad de Sevilla que analiza la evolución adaptativa del trébol blanco a escala global

Mié, 16/03/2022 - 10:53 | dircom7
Una doctoranda de la US presenta la primera tesis sobre ‘Comunidades Compasivas al final de la vida’ de España
La doctora Silvia Librada ha obtenido la calificación ‘Cum Laude’ en la presentación de la tesis doctoral realizada en Sevilla, en donde desde la Fundación New Health, dirige el programa ‘Sevilla Contigo, Ciudad Compasiva’ dirigido a más de 100.000 personas con el apoyo de Fundación La Caixa, Fundación Cajasol, Ayuntamiento de Sevilla y del Servicio Andaluz de Salud (SAS)
Lun, 14/03/2022 - 13:02 | dircom7
Un documental repasa los trabajos de la US en el yacimiento de Saruq Al Hadid
La producción, financiada por la Embajada de España en los Emiratos Árabes Unidos, ha sido presentada en la Exposición Universal de Dubai
Vie, 11/03/2022 - 08:51 | dircom6
Envío de comunicaciones e inscripciones para el Congreso Internacional Cultura de Frontera y Patrimonio
La reunión científica tendrá lugar los días 23 y 24 de septiembre de este año

Mié, 09/03/2022 - 11:11 | dircom7
Avistamiento inesperado de la superficie de Venus
Un investigador de la US ha sido el encargado de diseñar la estrategia de observación del planeta. Los resultados de la observación permitirían sumar nuevos objetivos científicos a la misión Parker

Lun, 07/03/2022 - 09:59 | dircom7
La igualdad de género ha progresado considerablemente en España en los últimos 20 años
Un estudio de la US y la UPO destaca la reducción de la brecha entre hombres y mujeres para acceder a la educación, el trabajo y los puestos de decisión, aunque alerta de la ralentización de ese proceso

Vie, 04/03/2022 - 11:03 | dircom7
Tomates de igual calidad con menos agua de riego
Los resultados de este estudio pueden contribuir al ahorro de agua para irrigación a nivel mundial y a la producción de tomates más saludables

Vie, 25/02/2022 - 08:57 | dircom7
‘ConCiencia ConHumor’, el humor gráfico como herramienta para la divulgación científica
La US participa en esta exposición instalada en el Rectorado de la Universidad de Alcalá de Henares que destaca la importancia de fomentar la divulgación científica para acabar con bulos, desmontar mitos y potenciar el pensamiento crítico

Mié, 23/02/2022 - 13:26 | dircom7
Una investigadora de la US estudiará las propiedades de la cerveza gracias a la beca Manuel de Oya
Se integrará en el grupo de investigación CTS-259 de Farmacología Experimental y Farmacia Clínica de la US

Lun, 21/02/2022 - 14:47 | dircom7
Una terapia combinatoria experimental logra eliminar un tumor cerebral incurable
Investigadores del Instituto de Biomedicina de Sevilla y del Imperial College de Londres hallan una nueva terapia para el tratamiento del tumor cerebral más común en seres humanos consistente en la combinación de un fármaco y radioterapia focal cerebral

Vie, 18/02/2022 - 12:52 | dircom7
Cuatro investigadores andaluces recogen los IX Premios Losada Villasante
Elvira Fialló, Manuel Baena, Pedro Medina y Ana Isabel Borrás recogen sus galardones en un acto presidido por el consejero de Transformación Económica, Industria, Conocimiento y Universidades

Vie, 18/02/2022 - 08:44 | dircom7
Desarrollan una tecnología óptica de detección rápida de la Covid-19
Esta nueva herramienta ha permitido detectar el SARS-CoV-2 en exudado de pacientes sintomáticos con una sensibilidad del 100% y especificidad del 87.5%

Mar, 15/02/2022 - 09:46 | dircom7
El proceso de recuperación del infarto de miocardio
Un estudio abre la puerta a la administración de una molécula como potencial tratamiento para regular los procesos de recuperación tras el evento isquémico

Jue, 10/02/2022 - 12:41 | dircom7
La US participa en el primer experimento de contextualidad cuántica «sin escapatorias»
La contextualidad es esencial para explicar el poder de los ordenadores cuánticos y la seguridad de las comunicaciones cuánticas.

Mié, 09/02/2022 - 13:46 | dircom7
Un experimento europeo alcanza un nuevo récord de energía de fusión
Los investigadores Eleonora Viezzer y Manuel García Muñoz, del grupo de Plasma Science and Fusion Technology de la US, han participado en el proyecto

Mié, 09/02/2022 - 11:17 | dircom7
Recuperan un antibiótico olvidado para infecciones de bacterias resistentes
Se trata del resultado de un trabajo en el que han colaborado investigadores de 22 hospitales diferentes y que ha sido liderado por el Hospital Virgen Macarena de Sevilla.

Mar, 08/02/2022 - 08:56 | dircom7
La US participa en un proyecto para la transformación digital del sector agroalimentario
El departamento de Geografía Física y Análisis Geográfico Regional de la US participa en el proyecto AgrarIA, el primer gran proyecto de Inteligencia Artificial a nivel nacional y empresarial para la transformación digital del sector agroalimentario, con un presupuesto de 9,75 millones de euros.

Vie, 04/02/2022 - 08:48 | adminUS
La profesora Ruth Pliego participa en la coordinación del proyecto MONOM
La reunión inaugural del proyecto 'La moneda en el Occidente mediterráneo' se celebra los días 17 y 18 de febrero en la Casa de Velázquez de Madrid

Mié, 02/02/2022 - 08:46 | adminUS
CulturalFit Solutions lanza su nueva plataforma digital
Se basa en técnicas de data science para conocer el grado de ajuste entre los valores de los miembros de un equipo y una organización y que explican el rendimiento y el éxito empresarial

Mar, 01/02/2022 - 11:32 | dircom7
La US celebra el 11 de febrero con sus científicas
Una decena de investigadoras de la US nos cuentan por qué es importante visibilizar la labor de la mujer en la ciencia. Además, se han programado diversas actividades para conmemorar el Día de la Mujer y la Niña en la Ciencia.

Mar, 01/02/2022 - 09:57 | dircom2
IV edición de las Jornadas de Comunicación y Cultura de Masas del grupo IDECO
La Facultad de Comunicación de la Universidad de Sevilla acoge la IV edición de estas jornadas los próximos días 23 y 24 de febrero de 2022. La inscripción se cierra el día 18 de febrero.

Vie, 28/01/2022 - 09:34 | adminUS
Reducir el coste eléctrico de las fábricas utilizando herramientas de inteligencia artificial
La US y el sector cementero andaluz realizan un proyecto de investigación industrial en el marco de un Doctorado con vocación de transferencia de resultados
Mié, 26/01/2022 - 13:19 | dircom6
La emergencia climática, a debate en el número 55 de la revista Ámbitos
La revista aborda además asunto relacionados con el periodismo, la publicidad o el cine

Lun, 24/01/2022 - 14:58 | dircom7
Los emprendedores nuevos y nacientes crecieron en Sevilla a pesar de la pandemia
En 2020, estos indicadores registraron tasas del 2,7% en el caso de los emprendeores nacientes y del 3,9% para los emprendedores nuevos

Jue, 20/01/2022 - 11:07 | dircom7
Determinan el riesgo de padecer cáncer de hígado tras superar la infección por Hepatitis C
Los resultados del estudio, desarrollado desde el Hospital Virgen del Rocío, manifiestan la importancia de la medicina personalizada y la evaluación de cada paciente

Mar, 18/01/2022 - 17:00 | dircom7
Las matemáticas generaron 123.000 puestos de trabajo directos en Andalucía durante 2019
El Instituto Andaluz de Matemáticas presenta un estudio que mide el impacto socioeconómico de las Matemáticas en Andalucía y España

Mar, 18/01/2022 - 13:26 | dircom6
Emilio Fernández Espejo consigue el Premio Espina y Capó de Investigación sobre Neurociencias
El investigador de la US se hace con el galardón gracias a una investigación sobre párkinson

Mar, 18/01/2022 - 11:16 | dircom7
Entendiendo la pérdida de memoria en la enfermedad de Alzheimer
Los resultados apuntan a la acumulación de una proteína en el cerebro como causa principal

Mar, 18/01/2022 - 09:01 | dircom7
La Fundación "la Caixa" beca a un investigador de la US
La ayuda, dotada con más de 300.000 euros, le permitirá continuar su investigación sobre la leucemia mieloide aguda durante los próximos tres años

Lun, 17/01/2022 - 10:07 | dircom7
El IBiS contará con una infraestructura singular de vanguardia para el estudio molecular de las enfermedades
La financiación de 1,35 millones de euros procede del Instituto de Salud Carlos III con cargo a los fondos europeos de Recuperación, Transformación y Resilencia. Además, la Infraestructura Singular para Investigaciones Biomédicas en Células Individuales (ISIBiSCI) cuenta con fondos para facilitar su uso por investigadores de otros centros de cinco comunidades autónomas.
Mié, 12/01/2022 - 15:54 | dircom6
¿Quieres un proyecto europeo? El Programa Erasmus + es una oportunidad única para conseguirlo
Erasmus + es el programa de la Unión Europea en los ámbitos de la Educación Formación Juventud y Deporte para el periodo 2021-2027
Lun, 27/12/2021 - 11:57 | dircom2
Las Universidades de Colonia, Leipzig y Sevilla realizan una investigación arqueológica en Carissa Aurelia
Gracias a este trabajo se han establecido las zonas más interesantes del yacimiento para llevar a cabo excavaciones arqueológicas en un futuro próximo

Jue, 23/12/2021 - 12:17 | dircom6
Llega a más con tu investigación
Una Empresa Basada en el Conocimiento puede dar alas a tu investigación. Conoce cómo la Universidad de Sevilla te ayuda y te asesora en lo que necesitas

Lun, 20/12/2021 - 10:05 | dircom6
El blog de psicología E-Voluntas supera el millón de visitas
El blog parte del Laboratorio de Redes Personales y Comunidades del Departamento de Psicología Social de la Universidad de Sevilla

Mié, 15/12/2021 - 10:26 | dircom2
Hallados restos de edificaciones antiguas localizados entre Camposoto y Sancti Petri
Estas estructuras podrían corresponder al templo fenicio-púnico de Melqart y de Hércules en época romana

Vie, 03/12/2021 - 12:11 | dircom7
Nuevos avances sobre el mecanismo de producción de energía en las células
Los estudios recientes de los investigadores de la Universidad de Sevilla suponen un cambio de paradigma en los mecanismos íntimos de transferencia electrónica y acoplamiento energético en el mundo vivo

Jue, 02/12/2021 - 11:52 | adminUS
Francisco Sierra publica un nuevo ensayo sobre ciberactivismo
El texto aborda los procesos de activismo digital en Europa y América Latina desde una visión crítica

Jue, 02/12/2021 - 09:38 | dircom2
La US colabora con el Ayuntamiento para generar espacios públicos con más sombra y confort térmico
Con la creación de la Cátedra de Urbanismo Ecológico de Sevilla un equipo académico multidisciplinar de la US trabajará con la Gerencia de Urbanismo en las necesidades más urgentes y las soluciones más sostenibles.

Mar, 30/11/2021 - 11:17 | dircom7
Un libro analiza los medios de comunicación andaluces en homenaje al profesor Antonio Checa
Su trayectoria profesional abarca más de medio siglo como periodista y también como profesor e investigador en la Facultad de Comunicación de la Universidad de Sevilla
Mié, 24/11/2021 - 11:18 | dircom2
La sede del Festival de los Patios, en Córdoba, gana el VII Concurso de Ideas de la Cátedra Metropol-Parasol
Treinta participantes de diez universidades españolas y extranjeras han optado al concurso de ideas con mayor dotación económica de la Universidad de Sevilla

Mar, 23/11/2021 - 11:40 | dircom7
Los Premios Nacionales de Investigación 2021 distinguen a dos representantes de la US
Estos galardones, otorgados por el Ministerio de Ciencia e Innovación, son el reconocimiento más importante de España en el ámbito de la investigación científica

Mar, 23/11/2021 - 09:56 | adminUS
87 investigadores ocupan posiciones destacadas en la lista de alto impacto científico de la Universidad de Stanford
En el ranking por áreas se observa que los investigadores de la US destacan en 15 de las 22 áreas científicas analizadas y en 37 de las 176 subáreas de investigación

Mar, 23/11/2021 - 08:46 | dircom2
Los Premios Manuel Losada Villasante reconocen la actividad investigadora y la excelencia
Elvira Fialló, Manuel Baena, Pedro Medina y Ana Isabel Borrás han sido los elegidos por el jurado de estos galardones por sus investigaciones sobre sostenibilidad, el CO2., el cáncer, y la nanotecnología.

Mié, 17/11/2021 - 13:57 | dircom7
Tercera edición del concurso Tesis en 3 Minutos en la US
Los estudiantes de doctorado participantes tendrán que presentar sus investigaciones de modo divulgativo y en un máximo de 3 minutos
Mié, 17/11/2021 - 12:10 | dircom7
Una herramienta online de estimación de riesgo COViD-19 basada en la transmisión por aerosoles
Investigadores de la US desarrollan este nuevo sistema que permite a profesionales y público general evaluar la probabilidad de transmisión aérea en un recinto

Lun, 15/11/2021 - 11:21 | dircom7
La contaminación por mercurio más antigua del mundo, documentada en la Edad del Cobre ibérica
Investigadores de la US participan en una investigación que profundiza en la compleja relación del ser humano con el mercurio a través del tiempo

Jue, 11/11/2021 - 12:04 | dircom7
Los Premios cicCartuja-Ebro Foods 2019 y 2020 reconocen la excelencia científica en jóvenes investigadores
Tras el paréntesis provocado por la pandemia, se han entregado los premios correspondientes a las ediciones 2019 y 2020

Jue, 11/11/2021 - 10:22 | dircom7
Investigadoras de la US consiguen uno de los reconocimientos ODS Local Andalucía
El galardón ha sido concedido por el Fondo Andaluz de Municipios para la Solidaridad Internacional (FAMSI)

Mié, 10/11/2021 - 11:50 | dircom6
Un profesor de la US y Macarena coordina el primer Tratado de Neumología Pediátrica
El documento, editado por la Sociedad Española de Neumología Pediátrica (SENP) y la Sociedad Española de Neumología y Cirugía Torácica (SEPAR), tiene un eminente carácter práctico y ofrece información clínica actualizada sobre distintas enfermedades respiratorias infantiles, desde su nacimiento hasta la adolescencia y su transición a la etapa adulta

Mar, 09/11/2021 - 11:14 | dircom7
Análisis de la adaptación al medio acuático en mamíferos
Investigadores de la Universidad de Málaga utilizan el TC del CNA para la investigación del proceso evolutivo de delfines. Para ello, han utilizado esqueletos de tres ejemplares de delfines de agua dulce procedentes de una expedición de Félix Rodríguez de la Fuente
Vie, 05/11/2021 - 10:02 | adminUS
FECYT publica la convocatoria de ayudas para el fomento de la cultura científica, tecnológica y de la innovación 2021
El plazo interno de presentación de solicitudes de la US finaliza el 24 de noviembre

Jue, 04/11/2021 - 10:57 | dircom2
Antonio el Bailarín cumple 100 años con reconocimiento académico
La inauguración del Congreso "Antonio: Cien años de Baile" ha tenido lugar en el Paraninfo de la US con una conferencia de Juan Manuel Suarez Japón titulada “Antonio Ruiz Soler. El marco histórico-cultural de su larga trayectoria artística”.

Jue, 04/11/2021 - 09:00 | dircom7
Nuevas opciones terapéuticas en la enfermedad de Parkinson
Estos avances han sido recogidos en un nuevo artículo científico publicado en la revista internacional Nature, producto de la colaboración entre Northwestern University (Chicago), Weill Cornell Medical College (Nueva York) y el Instituto de Biomedicina de Sevilla HUVR/CSIC/US/ y Ciberned

Mié, 03/11/2021 - 14:15 | adminUS
Celebrado el primer encuentro nacional de la red EurofamNet
La US coordina una red multidisciplinar que pretende informar sobre las políticas y prácticas familiares a nivel europeo

Mié, 27/10/2021 - 10:39 | dircom2
Conceptualising Metrical Epigraphy Network
En el marco de este proyecto la Universidad de Sevilla realiza diversas actividades entre el 2 y el 10 de noviembre y recibe a los once doctorandos adscritos

Lun, 25/10/2021 - 11:36 | adminUS
Premios Fama a los investigadores más excelentes
El rector advierte que "el futuro de la investigación universitaria está actualmente en peligro en nuestro país" y requiere "un giro de las políticas de investigación con una financiación equiparable al resto de Europa"

Vie, 22/10/2021 - 09:16 | adminUS
Los riesgos para la salud de eliminar el cambio estacional de hora
Un estudio de la US defiende que el cambio de hora ayudó a mantener la alineación del comienzo de la actividad con la salida del Sol durante todo el año

Mar, 19/10/2021 - 13:25 | adminUS
'Vence-remos', una clara alusión a la lucha contra el cáncer a través del deporte
Esta novedosa propuesta liderada por el profesor Juan Gavala está basada en la actividad física mediante el remo ajustada a las necesidades de las mujeres supervivientes de cáncer de mama

Jue, 14/10/2021 - 13:40 | dircom7
Un equipo de la US estudia a un pez luna de más de 1.000 kg
El ejemplar, que fue localizado en aguas de Ceuta, fue liberado de la red en la que había quedado atrapado y devuelto al mar

Jue, 14/10/2021 - 11:33 | dircom2
Las inscripciones latinas de la Casa Palacio de la Condesa de Lebrija
Este libro reúne la edición crítica y comentario de quince inscripciones latinas conservadas en la Casa Palacio de la Condesa de Lebrija, situada en la calle Cuna de la ciudad de Sevilla, donde se conservan y exhiben materiales procedentes de Itálica.

Vie, 08/10/2021 - 12:49 | dircom7
Apuesta por los biocombustibles del futuro
El proyecto NICER BIOFUELS recibe 900.000 euros para el desarrollo de tecnologías pioneras en la conversión de residuos en biocombustibles para el transporte pesado

Mar, 05/10/2021 - 09:30 | dircom7
La US reconoce a cinco de sus investigadores con el Premio Fama
Francisca de Asís Chávez Tristán, José Carlos García Gómez, Catalina Alarcón de la Lastra Romero, Concepción Barrero Rodríguez y José Domínguez Abascal han sido los elegidos por el jurado de esta XIV edición del Premio

Vie, 01/10/2021 - 13:14 | dircom7
El CNA y ENRESA avanzan en la clasificación de residuos radiactivos
El resultado de esta colaboración provocará una sinergia que puede reducir considerablemente el volumen de residuos radiactivos en España

Mar, 28/09/2021 - 09:10 | dircom7
La reacción de las plantas ante el estrés
Entender como son capaces de responder a estas condiciones de estrés permitirá diseñar soluciones para minimizar el impacto en la agricultura de factores como el cambio climático

Jue, 23/09/2021 - 12:53 | dircom7
La intervención del ARN mensajero en la reparación del ADN
Investigadores de la US participan en un estudio que conecta la reparación de las roturas del ADN y los factores modificadores del ARN mensajero

Mar, 21/09/2021 - 13:06 | dircom7
La Noche Europea de l@s Investigador@s trae a Sevilla más de un centenar de actividades el 24 de septiembre
Más de 200 investigadores e investigadoras compartirán sus conocimientos con la ciudadanía en actividades presenciales y telemáticas

Mar, 21/09/2021 - 11:22 | dircom7
La importancia del entorno en los enfermos de Alzheimer
Un estudio impulsado desde las universidades de Sevilla y Málaga busca soluciones arquitectónicas y aplicaciones prácticas en el diseño de edificios destinados a personas con esta enfermedad

Mié, 15/09/2021 - 16:15 | dircom7
Andalucía celebra el 24 de septiembre La Noche Europea de l@s investigador@s con actividades presenciales y virtuales
Más de 2.500 investigadores e investigadoras acercarán su trabajo a la ciudadanía con más de 700 actividades en las que se garantizan las medidas de seguridad para hacer frente a la Covid-19
Mar, 14/09/2021 - 12:12 | dircom7
El origen de las variaciones en la virulencia de la Salmonella
Una investigación desarrollada en la US permite entender por qué las enzimas de Salmonella tienen ciertos sustratos humanos específicos y no son de amplio espectro

Mié, 08/09/2021 - 12:09 | dircom7
El grado de responsabilidad asumido por los padres en la crianza es inferior al de las madres
Investigadoras de la Universidad de Sevilla y la Escuela Andaluza de Salud Pública señalan que las expectativas sociales de unas relaciones más igualitarias en el hogar no se cumplen

Lun, 06/09/2021 - 13:08 | dircom7
La red NewFrac celebra en la ETSI su primera cita presencial
Se trata de la primera cita presencial de los integrantes de esta red, que hasta el momento han venido trabajando de forma virtual debido a las restricciones sanitarias

Vie, 03/09/2021 - 11:06 | dircom7
Nueva vía de estudio para entender el origen de la inestabilidad genética
Las células cancerígenas son muy inestables y presentan mutaciones en sus cromosomas

Mié, 01/09/2021 - 12:00 | dircom7
Avances en la lucha contra las ENACH
Los profesores Mercedes Villar (Departamento de Química Analítica) y Juan Vázquez (Departamento de Química Orgánica) impulsan un proyecto para sintetizar una sustancia con la que se tratan las Enfermedades Neurodegenerativas por Acumulación Cerebral de Hierro

Vie, 27/08/2021 - 11:49 | dircom2
La falta de una proteína causa inestabilidad genómica en pacientes del síndrome de Mulibrey
La ausencia de la proteína TRIM37 induce la formación en las células de centrosomas, que a su vez favorecen la aparición de tumores

Mar, 24/08/2021 - 11:35 | dircom2
Potenciar la agricultura verde gracias a aplicaciones microbiana
Una investigación de la Universidad de Sevilla trabaja en potenciar la agricultura verde gracias a aplicaciones microbianas. Concretamente estudia un arma molecular que usan las bacterias para eliminar a sus competidores.

Jue, 19/08/2021 - 09:37 | dircom2
Microplásticos en ríos de España, un problema creciente y extendido
La Asociación Hombre y Territorio (HyT) y la US alertan de la presencia de microplásticos en cerca del 75% de los arroyos y ríos de la España peninsular analizados. En un reciente estudio se han identificado polímeros de diversos tipos y de fuentes distintas.

Lun, 09/08/2021 - 12:38 | dircom7
Nueva técnica para detectar virus en superficies mediante imágenes hiperespectrales
La técnica, desarrollada por un equipo liderado desde la US, se ha aplicado con éxito en dos modelos sintéticos del SARS-CoV-2. Los investigadores continuarán ahora su trabajo con muestras humanas

Vie, 06/08/2021 - 10:36 | adminUS
Una joven investigadora postdoctoral recibe un premio por su trabajo sobre la ‘Teoría de las singularidades’
María de la Paz Tirado es Premio Vicent Caselles por su autonomía científica con publicaciones en solitario de alta calidad

Lun, 26/07/2021 - 11:43 | adminUS
El profesor Javier Sánchez-Rivas, premiado por un estudio sobre el consumo de luz y el crecimiento turístico
Ha recibido el Premio a la Publicación Científica (junio 2021) de la Facultad de Turismo y Finanzas

Mar, 20/07/2021 - 12:50 | dircom7
El IBiS acoge la primera reunión presencial de la red RNA life2 después del confinamiento
Esta propuesta nace de una red previa (mRNA life) financiada por el Ministerio de Ciencia, Innovación y Universidades entre los años 2016 y 2018

Mar, 20/07/2021 - 11:58 | dircom7
Clausura del proyecto ‘Una Tabla Periódica con mucha vida. Los elementos dan la cara’
La iniciativa ha sido seleccionada por la FECYT para formar parte de la novena edición de su catálogo de Prácticas Innovadoras en Cultura Científica

Mié, 14/07/2021 - 10:27 | dircom7
El cuerpo carotídeo como modulador de los niveles de lactato en sangre
El lactato, clásicamente descrito como un producto de desecho del metabolismo que se producía cuando no había oxígeno suficiente, es considerado en la actualidad un sustrato metabólico capaz de generar energía. Sin embargo, aún se conoce poco sobre cómo se regulan sus niveles en sangre

Vie, 02/07/2021 - 10:03 | dircom7
¿Cómo se forman las marismas costeras?
Un estudio analiza durante tres décadas el proceso de formación de estos ecosistemas
Jue, 01/07/2021 - 10:51 | dircom2
Identifican una fase "inédita" de ocupación islámica en el enclave de Cerro Macareno
La investigación arqueológica está promovida por el Departamento de Prehistoria y Arqueología de la Universidad de Sevilla

Jue, 01/07/2021 - 10:35 | dircom7
El proyecto de investigadores de Ciberesp en el IBiS será financiado por la Marató de TV3
El proyecto 'Diagnóstico y tratamiento del SARS-CoV-2 por formación de triplex' recibe 398.7500 euros para su puesta en marcha
Mié, 30/06/2021 - 17:08 | dircom6
Las intervenciones de base comunitaria resultan altamente efectivas para mejorar el bienestar psicológico de los niños trabajadores
El investigador Isidro Maya publica un nuevo libro coincidiendo con el Año Internacional para la Eliminación del Trabajo Infantil

Mié, 30/06/2021 - 11:55 | dircom6
Jose Candón y David Montero publican un análisis histórico del activismo digital en International Journal of Communication
El artículo se enmarca en el proyecto de I+D 'Ciberactivismo, Ciudadanía Digital y Nuevos Movimientos Urbanos'

Mar, 29/06/2021 - 13:28 | dircom7
La US convoca sus Ayudas para la Recualificación del Sistema Universitario Español
Se convierte en la primera universidad española en abrir esta convocatoria

Lun, 28/06/2021 - 13:06 | dircom7
Un investigador de la US participa en la 70ª Reunión de Premios Nobel de Lindau
Estos encuentros reúnen cada año a premios Nobel con jóvenes investigadores

Lun, 28/06/2021 - 12:29 | dircom7
La US se une al mayor experimento mundial en el estudio de las oscilaciones de neutrinos
Los neutrinos son unas partículas extremadamente ligeras y esquivas, lo que las hace muy difíciles de detectar

Jue, 24/06/2021 - 10:08 | dircom7
Andrés Aguilera recibe el Premio Nacional de Genética 2021
El investigador de la US y director de Cabimer ha sido galardonado por sus aportaciones al estudio de la inestabilidad genómica
Mié, 23/06/2021 - 16:31 | dircom7
Proyecto Europeo ‘Social Inclusion through sport-based interventions – DISCIPLINS’
La profesora Dolores Limón coordina este proyecto en la Universidad de Sevilla

Mié, 23/06/2021 - 16:17 | dircom7
Jose Candón liderará un proyecto estatal de I+D de la convocatoria Retos de la Sociedad 2020
El proyecto se centra en la 'Sostenibilidad del Tercer Sector de la Comunicación'

Mar, 22/06/2021 - 09:07 | dircom7
Primera descripción común para reacciones nucleares de núcleos estables y radiactivos
Investigadores de la US consiguen por primera vez una descripción común para estos dos fenómenos, que permitirá entender mejor la materia conocida en el universo

Lun, 21/06/2021 - 11:03 | adminUS
Los menores de los centros de protección que son acogidos por familias colaboradoras presentan mejora psicosocial
La Universidad de Sevilla y la asociación Crecer con Futuro realizan la investigación ‘Familias colaboradoras: un estudio sobre familias, infancia y adolescencia tutelada y procesos en la colaboración’

Jue, 17/06/2021 - 12:13 | dircom7
Europa necesita crecer mucho más de lo que ha caído su economía para recuperar su nivel de bienestar
Investigadores de la Universidad de Sevilla aseguran que el bienestar que se pierde en las recesiones requiere una expansión mucho más vigorosa para compensarse

Mié, 16/06/2021 - 11:27 | dircom7
9 de cada 10 anuncios dirigidos a niños incumplen la normativa sobre alimentación saludable
Tras analizar 177 piezas publicitarias de cinco canales de televisión españoles, se ha podido constatar que los anuncios de productos lácteos y bollería industrial son los que más infringen las normas

Mié, 16/06/2021 - 10:27 | Anónimo
Envío de comunicaciones al ‘I Congreso Internacional Feminismo Digital’
Este evento interdisciplinar feminista se centra en los derechos de las mujeres en la sociedad tecnológica

Lun, 14/06/2021 - 08:58 | Anónimo
Abierto el plazo para participar en el concurso Tesis en 3 Minutos
El concurso plantea a los estudiantes el reto de explicar su investigación de forma oral en un periodo de tiempo limitado, con un lenguaje sencillo y accesible al público

Mié, 09/06/2021 - 10:45 | Anónimo
Investigadores de la US participan en un estudio sobre el efecto de los plaguicidas en agricultoras andaluzas
El estudio, que ha sido realizado en colaboración con la Universidad de Salamanca, asegura que asegura que la exposición a agroquímicos puede ser uno de los factores que causen la enfermedad renal crónica de etiología

Mar, 08/06/2021 - 14:15 | dircom7
Lino Camprubí ingresa en la Academia Joven de España
El investigador de la Universidad de Sevilla ha sido designado académico de número de la entidad por una comisión internacional de expertos

Mar, 08/06/2021 - 13:05 | dircom6
La US participa en una campaña oceanográfica al Atlántico Norte financiada por la NASA
Tres buques oceanográficos, 150 investigadores internacionales y los centros de investigación oceanográfica más potentes del mundo han participado en la expedición

Mar, 08/06/2021 - 10:28 | dircom7
La ONU incluye la red JETZON en su década de la Oceanografía sostenible
La US está presente en la red JETZON a través de las investigaciones de la profesora María Villa

Mar, 08/06/2021 - 08:54 | dircom7
Los efectos del confinamiento en estudiantes de la US
Investigadores del equipo Solar Decathlon de la US desarrollan este estudio con alumnos de Arquitectura y Medicina

Lun, 07/06/2021 - 13:50 | dircom7
El proyecto ‘Beyond the Eye’ propone detectar anomalías oculares a través de una aplicación informática
La iniciativa, en la que participan investigadores de la US, consigue ganar el concurso de ideas Shark Tank 2021 de la plataforma de mentorización IMFAHE

Lun, 07/06/2021 - 12:34 | Anónimo
Investigadores de la US participan en un proyecto con pacientes con Covid-19 persistente
El grupo Minerva colabora en el proyecto internacional ‘SENSING-AI’, con el que facilitar a los médicos de atención primaria el seguimiento de este tipo de pacientes con Covid
Lun, 07/06/2021 - 10:51 | dircom7
La US impulsa la labor de sus investigadores de alto impacto
Miembros del equipo de gobierno se reúnen con los beneficiarios del Plan de Fomento de la Actividad Investigadora Excepcional

Vie, 04/06/2021 - 11:59 | adminUS
La US da la bienvenida a 15 investigadores de excelencia gracias al programa Emergia
El rector se reúne por videoconferencia con los beneficiarios de estas ayudas

Sáb, 29/05/2021 - 10:39 | dircom6
Entendiendo la fatiga en Esclerosis Múltiple a través de la tecnología
Cada 30 de mayo se celebra el Día Mundial de la Esclerosis Múltiple

Mié, 26/05/2021 - 12:50 | dircom7
Investigadores de la US reciben un galardón de la Comisión Europea en materia de patrimonio
Los Premios Europa Nostra, considerados los más importantes de Europa en este campo, reconocen a un proyecto que ha creado herramientas digitales para la evaluación y conservación del patrimonio histórico

Mar, 25/05/2021 - 08:25 | dircom7
Un mecanismo que reduce los vasos sanguíneos en pacientes de Alzheimer
El estudio demuestra por primera vez que un problema en la angiogénesis (mecanismo por el que se producen nuevos vasos sanguíneos) provoca la destrucción de los capilares y, por tanto, una disminución en el aporte de nutrientes y oxígeno al cerebro.

Jue, 20/05/2021 - 09:20 | dircom7
El aislamiento social afecta a la capacidad funcional de las personas
La US coordina un estudio internacional que ha seguido durante 10 años a más de 13.000 personas para analizar las consecuencias del aislamiento

Mar, 18/05/2021 - 14:01 | dircom7
Sesión informativa para colaborar con The Conversation
La US se sitúa como una de las principales instituciones divulgadoras en The Conversation ES

Mié, 05/05/2021 - 10:41 | dircom7
La lactancia materna durante la pandemia por Covid-19
El trabajo de un grupo de investigadoras de la US sobre los efectos de la pandemia en la lactancia ha sido reconocido durante una jornada celebrada con motivo del Día Internacional de la Matrona
Mar, 04/05/2021 - 09:18 | dircom7
Respuesta al daño en el ADN: el doble papel del citocromo c extramitocondrial
La proteína citocromo c extra-mitocondrial podría ejercer un papel protector en la célula sometida a bajos niveles de daño en el ADN, pero sentenciarla a muerte en el caso de que el nivel de daño alcanzase un punto de no retorno que hiciese imposible su reparación.

Mar, 04/05/2021 - 08:53 | dircom7
Un estudio sobre la Jerarquía Funcional de las Proteínas, financiado por Fundación Ramón Areces
El proyecto, dirigido por la catedrática de la US Irene Díaz Moreno, profundiza en la comunicación bidireccional entre núcleo celular y mitocondria

Lun, 03/05/2021 - 12:48 | Anónimo
Un proyecto de la US recibe el primer premio EFPIA Connecting Healthcare 2021
El proyecto 'Mapa Internacional de Axial Spondyloarthtiris' (IMAS) ha obtenido la máxima puntuación por parte de un panel independiente formado por expertos que lo han seleccionado entre más de 60 propuestas evaluadas

Lun, 03/05/2021 - 12:43 | dircom7
Restaurando los bosques de gorgonias de la Isla de Tarifa
Científicos de la Universidad de Sevilla, junto con la Fundación Biodiversidad, ponen en marcha un prometedor proyecto de restauración de los bosques de gorgonias amenazados en el Parque Natural del Estrecho

Lun, 03/05/2021 - 12:32 | adminUS
La US y Agrosap desarrollan una tecnología para reducir la contaminación por micotoxinas de alimentos
La solución desarrollada reducirá riesgos para la salud humana y animal, mejorará la rentabilidad de los agricultores y reducirá la huella ambiental en la producción agrícola

Vie, 30/04/2021 - 08:50 | Anónimo
Participa en el estudio sobre las necesidades del profesorado en relación con las del alumnado con discapacidad
El estudio se encuentra dentro del II Plan Integral de Atención a las Necesidades de Apoyo para Personas con Discapacidad o con Necesidad de Apoyo por Situación de Salud Sobrevenida

Jue, 29/04/2021 - 13:16 | dircom7
Asocian nuevos indicadores clínicos entre la Covid-19 y pacientes con trasplantes
Investigadores de hasta 12 hospitales españoles han participado con el objetivo de dar a conocer características clínicas y pronósticas de los receptores de órgano sólido que padecen COVID-19. Las conclusiones subrayan la necesidad de estrictas medidas preventivas en el período precoz tras el trasplante.

Jue, 22/04/2021 - 11:16 | dircom2
Los miércoles conectados con IA
Proyecto liderado por el Campus de Excelencia Internacional Andalucía TECH, donde sus dos Universidades, Sevilla y Málaga, actúan con empresas tecnológicas para el desarrollo de tecnologías de Inteligencia Artificial (IA).
Mar, 20/04/2021 - 13:24 | dircom7
Colabora con el estudio ‘Tecnología y movimiento’
Los responsables necesitan voluntarios para esta investigación que pretende conocer los hábitos de actividad física y uso de pantallas de los trabajadores

Jue, 15/04/2021 - 12:37 | dircom7
Descubren una asociación entre la reducción local de oxígeno en el cerebro y el Alzheimer
El estudio, desarrollado desde el Instituto de Biomedicina de Sevilla, demuestra que la reducción local de los niveles de oxígeno hace que el cerebro resista peor el avance de la enfermedad. Esto resalta la importancia de un estilo de vida saludable para prevenir los daños causados por la enfermedad de Alzheimer

Mié, 14/04/2021 - 12:49 | Anónimo
Andalucía Tech organiza 'Los miércoles conectados con Inteligencia Artificial'
Dentro del proyecto 'Ecosistema Innovador con Inteligencia Artificial para Andalucía 2025', los cinco encuentros virtuales reunirán a investigadores que trabajan en el desarrollo de tecnologías de IA

Mar, 13/04/2021 - 14:31 | dircom2
Investigadores de la US reciben el Premio Joven a la Cultura Científica
El Ayuntamiento de Sevilla ha hecho entrega de la VIII edición del Premio Joven a la Cultura Científica a trabajos relacionados con la salud pública, el cambio climático o la igualdad. Entre los galardonados, tres investigadores de la US.

Mar, 13/04/2021 - 11:51 | dircom7
Descubren que la propia estructura del ADN participa activamente en la regulación del genoma
Esta nueva forma de regulación pone en relieve su posible implicación en procesos fundamentales para la célula, y que requieren cambios profundos en los programas de expresión génica, como son la diferenciación o la reprogramación celular, así como la transformación y la progresión tumorales
Mar, 06/04/2021 - 13:46 | dircom7
¿Cómo colaborar con la revista iDescubre desde la US?
La Universidad de Sevilla y la Fundación Descubre mantienen una colaboración que permite al personal investigador de la US participar en la creación de contenidos para la revista online de divulgación científica iDescubre y poner así al alcance de la ciudadanía su conocimiento

Mar, 06/04/2021 - 11:26 | dircom7
El atún rojo del Estrecho ya era un manjar en la Grecia Clásica
Investigadores de la US documentan la presencia de fragmentos de ánforas gaditanas entre los restos de una taberna de Corinto (Grecia)

Mar, 06/04/2021 - 10:08 | dircom7
Una patente que ayudará a optimizar las verificaciones de los tratamientos de radioterapia
Investigadores del Centro Nacional de Aceleradores, centro mixto en el que participa la US, forman parte del equipo que desarrolla esta patente

Jue, 25/03/2021 - 11:48 | dircom7
La US participa en un proyecto europeo de 5M de euros para aumentar la seguridad digital
El proyecto 'Security Platform for ICT System Rooted at the Silicon Manufacturing Process' (SPIRS) tiene como objetivo buscar soluciones que aumenten la seguridad de sistemas ICT (Tecnología de Información y Comunicaciones)

Mar, 23/03/2021 - 13:23 | dircom2
La ETSI de la US celebra la 18º Edición de ESIEM
La Escuela Técnica Superior de Ingeniería de la Universidad de Sevilla celebra la 18º Edición de su Encuentro sobre Ingeniería y Empleo, ESIEM 2021
Mar, 23/03/2021 - 09:53 | dircom7
Investigadores españoles cuantifican el grado de contaminación de los puertos deportivos
Los autores del estudio proponen un nuevo índice para clasificar estas instalaciones según el grado de contaminación que generan

Mié, 17/03/2021 - 09:25 | dircom7
Nuevas dianas en el proceso de angiogénesis
El trabajo ha demostrado la participación de una nueva ruta de entrada del ion Ca2+ en procesos de angiogénesis y formación de nuevos vasos sanguíneos. Esta ruta de Ca2+ es conocida por sus siglas en inglés como SOCE (Store operated Ca2+ entry).

Mar, 16/03/2021 - 14:06 | dircom6
Un informe de la US potencia las capacidades emprendedoras en la Sociedad Andaluza de Telecomunicaciones
El informe de situación inicial con relación a las condiciones organizacionales de SANDETEL para el desarrollo de acciones de emprendimiento corporativo e intraemprendimiento se ha presentado de manera online este martes 16 de marzo

Mar, 16/03/2021 - 11:31 | dircom7
'Machine learning' para predecir el comportamiento de componentes electrónicos no testeados
El CNA lidera esta iniciativa que se enmarca dentro del Proyecto Ecosistema Innovador con Inteligencia Artificial para Andalucía 2025, impulsado por el Campus de Excelencia Internacional Andalucía TECH

Lun, 15/03/2021 - 11:34 | dircom7
Cuatro investigadores de la US recogen los VIII Premios Manuel Losada Villasante
Eleonora Viezzer, Gregorio Egea, Iván Maza y Alberto Romero han recogido sus galardones en un acto celebrado este 15 de marzo

Jue, 11/03/2021 - 11:52 | dircom2
La Cátedra Fundación Cepsa de la Universidad de Sevilla celebra su décimo aniversario
La Cátedra Fundación Cepsa de Transición Ecológica de la Universidad de Sevilla ha presentado su memoria anual correspondiente a 2020, año de su décimo aniversario.

Mié, 10/03/2021 - 10:28 | dircom7
El problema silenciado del consumo de alcohol en la gestación
Expertos de la Universidad de Sevilla alertan de que el consumo de alcohol durante el embarazo puede ser superior al percibido por los profesionales y las instituciones sanitarias

Lun, 08/03/2021 - 13:23 | dircom2
Flacema y la US premian la investigación de jóvenes ingenieros
El objetivo del galardón es incentivar la investigación sobre el cemento y sus aplicaciones por parte de futuros ingenieros

Vie, 05/03/2021 - 08:59 | dircom7
La información deportiva en redes sociales también deja de lado a mujeres, discapacitados y disciplinas minoritarias
Una investigación describe la desigualdad en el tratamiento informativo de estos colectivos en los perfiles en Twitter de cuatro medios públicos europeos

Mar, 02/03/2021 - 11:24 | dircom7
Los fármacos antipsicóticos podrían tener un efecto protector ante la Covid-19
Los resultados de dos investigaciones apuntan a que las personas que reciben de manera regular este tratamiento tienen un menor riesgo de infectarse, y en caso de hacerlo, la enfermedad es más leve

Vie, 26/02/2021 - 11:05 | dircom7
El uso de inteligencia artificial puede mejorar el estado de salud de las embarazadas
Un estudio publicado por la Universidad de Sevilla afirma que esta tecnología ayuda a diagnosticar antes defectos de nacimiento, diabetes gestacional y el parto pretérmino

Jue, 25/02/2021 - 14:03 | dircom7
Un estudio analiza las causas del ascenso de VOX en las elecciones andaluzas de 2018
La investigación, desarrollada en el marco del proyecto ‘Dinámicas socioterritoriales en las áreas metropolitanas españolas: Procesos estructurales y cambio cíclico (DINAMET)’, dirigido por el catedrático de Geografía Humana de la UPO José María Feria Toribio, y ha contado con la participación de la profesora de la US Virginia Paloma

Mar, 23/02/2021 - 08:34 | dircom7
El impacto socioemocional y educativo del confinamiento en la infancia andaluza
El estudio, en el que ha participado la US junto a las demás universidades andaluzas, concluye que el juego en familia y el apoyo con las tareas escolares salvaron a los niños de la tristeza, aunque marca importantes diferencias en las familias con menos recursos.

Jue, 18/02/2021 - 09:00 | dircom2
Editorial US amplía catálogo en descarga gratuita con dos guías sobre terremotos
Los libros pertenecen proyecto de investigación PERSISTAH y están disponibles en descarga gratuita en español, portugués e inglés

Jue, 18/02/2021 - 09:00 | dircom2
EUS amplía su catálogo de descarga gratuita con dos guías sobre terremotos
Los libros pertenecen proyecto de investigación PERSISTAH y están disponibles en español, portugués e inglés

Mié, 17/02/2021 - 17:22 | dircom7
La tecnología sevillana que aterriza en Marte con el Rover de la NASA
El mecanismo ASIC, relacionado con los sensores de viento del instrumento, ha sido diseñado por el Instituto de Microelectrónica de Sevilla, centro mixto del CSIC y la Universidad de Sevilla

Mié, 17/02/2021 - 12:41 | dircom6
Investigadores de la FCom analizan la comunicación postdigital en la sociedad de la Covid-19
Fake news, desinformación o el ecosistema digital son algunos de los aspectos tratados por los profesores Mar García Gordillo y Manuel Ángel Vázquez Medel
Mié, 17/02/2021 - 11:20 | dircom6
Las hablas andaluzas, en radio y prensa por la profesora Lola Pons
La realidad lingüística andaluza, presente en la actualidad mediática

Mar, 16/02/2021 - 10:58 | dircom2
Estudio científico exhaustivo al Efebo Dionisíaco
El Instituto Andaluz de Patrimonio Histórico y el Centro Nacional de Aceleradores de Sevilla realizan la tomografía computerizada de la cabeza del Efebo Dionisíaco

Mar, 16/02/2021 - 09:51 | dircom7
Evalúan la rehabilitación de una escombrera minera en Tharsis
Los resultados obtenidos muestran que las medidas aplicadas fueron exitosas: doce años después, la vegetación leñosa cubre la parte superior de la zona rehabilitada y proporciona un paisaje visual verde para los habitantes del pueblo

Lun, 15/02/2021 - 12:13 | dircom7
11 investigaciones de la US reciben ayudas Marie Curie
La US casi triplica el número de ayudas recibidas en la anterior convocatoria, cuando se financiaron cuatro proyectos. Estas 11 ayudas permitirán formalizar los contratos de otros tantos investigadores, que se integrarán en cada uno de los proyectos elegidos

Jue, 11/02/2021 - 12:33 | dircom2
El testamento de Juan Sebastián Elcano (1526). Palabras para un autorretrato
El 26 de julio de 1526 Juan Sebastián Elcano encontró la muerte en el Océano Pacífico, en su segundo viaje al Maluco. Pocos días antes había dictado su testamento. La EUS desgrana en este libro la personalidad de Elcano y los detalles de la confección del texto testamentario

Mié, 10/02/2021 - 09:21 | dircom7
Nueva metodología de resonancia magnética para diseñar fármacos contra el cólera
Expertos de la Universidad de Sevilla facilitan el diseño de inhibidores de la toxina que provoca esta enfermedad

Lun, 08/02/2021 - 08:37 | dircom7
Descubren nuevas conductas funerarias y rituales del neolítico en la península ibérica
Investigadores de la Universidad de Sevilla analizan dos cráneos humanos y restos de un caprino hallados en la Cueva de la Dehesilla (Cádiz)

Vie, 05/02/2021 - 11:26 | dircom7
Los VIII Premios Manuel Losada Villasante reconocen la labor de cuatro investigadores de la US
Eleonora Viezzer, Gregorio Egea, Iván Maza y Alberto Romero han sido los elegidos por el jurado de estos galardones, reunido este viernes 5 de febrero en el Rectorado de la US. Los Losada Villasante añaden este año una cuarta categoría que premia la investigación en Economía Circular

Mié, 03/02/2021 - 16:47 | dircom7
La Universidad de Sevilla suma sus esfuerzos a la lucha contra el cáncer
Investigadores de la US trabajan en distintos proyectos con el fin de facilitar el diagnóstico de la enfermedad o mejorar la calidad de vida de los pacientes

Mié, 03/02/2021 - 11:38 | dircom7
Investigadores del IBIS encuentran en tumores humanos mutaciones oncogénicas en el gen Espinofilina
Las alteraciones genéticas y su relación con células madre del cáncer y resistencia al tratamiento son claves para avanzar en terapias efectivas contra el cáncer

Mié, 03/02/2021 - 10:56 | dircom7
Seguimiento de delfines heridos en la bahía de Algeciras
Un equipo de la US sigue la evolución de ejemplares de delfín común, una especie considerada en peligro crítico de extinción en Andalucía

Lun, 01/02/2021 - 12:53 | dircom7
Evaluación del impacto del confinamiento en los distintos sectores económico gracias a los contadores inteligentes y la analítica de datos
Investigadores de la Universidad de Sevilla han utilizado la inteligencia artificial para medir la influencia que ha tenido el confinamiento decretado durante la primera ola de Covid-19 en España a partir de los datos de consumo eléctrico

Vie, 29/01/2021 - 10:56 | dircom7
La motivación inicial, factor clave para el aprendizaje en los cursos masivos en línea
Investigadores de la Universidad de Sevilla analizan los factores psicológicos que influyen en el aprendizaje de los participantes en los denominados cursos MOOCs

Mié, 27/01/2021 - 10:21 | dircom7
HISPANOS, la instalación donde se desarrollan técnicas no destructivas de detección multielemental con neutrones
Investigadores del CNA colaboran con la Universidad del País Vasco y con IDOM Consulting, Engineering and Architecture, S.A.U.

Mar, 26/01/2021 - 13:49 | dircom6
Elsevier inicia la indexación de la revista REDES en Scopus
Scopus es la mayor base de datos de citas y resúmenes de bibliografía revisada por pares
Lun, 25/01/2021 - 11:23 | dircom6
La revista Ámbitos publica su número 51
Ámbitos. Revista Internacional de Comunicación presenta su número 51 después de más de 20 años publicándose ininterrumpidamente.

Lun, 25/01/2021 - 11:22 | dircom7
Las funciones cognitivas en niños adoptados mejoran en familia
Expertos de la Universidad de Sevilla han estudiado la evolución de su atención, memoria y la capacidad de planificación y resolución de problemas

Vie, 22/01/2021 - 10:55 | dircom7
El impacto de la inmunoterapia en pacientes con cáncer de pulmón
Investigadores del IBIS analizan los mecanismos de resistencia a la inmunoterapia basada en el bloqueo de los puntos de control inmunitarios en pacientes con cáncer de pulmón no microcítico

Jue, 21/01/2021 - 09:21 | dircom7
La Covid-19 dificulta la atención a los enfermos en las UCI
Las enfermeras de cuidados intensivos resaltan el aislamiento de los pacientes, el miedo a lo desconocido y la incorporación de enfermeras no habituales de UCI como factores clave en el cuidado del paciente crítico con COVID-19, según destaca un estudio elaborado en la US

Mié, 20/01/2021 - 10:04 | adminUS
La US trabaja en un nuevo modelo productivo de agricultura ecosostenible
El proyecto iAgri se está realizando junto a las empresas Econatur y Solutia Digital Health

Mar, 19/01/2021 - 11:02 | dircom7
El patrimonio sonoro de las plazas de toros
Una tesis doctoral analiza la singularidad acústica de algunos de estos edificios monumentales atendiendo a la importancia del sonido en las corridas de toros

Jue, 14/01/2021 - 13:20 | dircom7
Investigadores del IBiS desarrollan biosensores para detectar el hongo P. jirovecii, responsable de la neumonía por Pneumocystis
El trabajo conjunto con el CIBER-BBN detecta este hongo atípico, responsable de neumonías muy graves en enfermos inmunodeprimidos

Mar, 12/01/2021 - 08:40 | dircom7
La COVID-19 amplifica las desigualdades que sufren las personas migrantes y refugiadas a nivel mundial
Dos profesoras de la US coordinan en España un estudio internacional impulsado por la OMS

Lun, 11/01/2021 - 11:39 | dircom7
La revista Física Médica entrevista a la investigadora Anna Baratto
La investigadora de la US y el CNA aborda en la entrevista su proyecto de diseñar un sistema para la irradiación de cultivos celulares mono capa

Jue, 07/01/2021 - 13:31 | dircom2
Desarrollan en la ETSI una herramienta para el estudio de lienzos en el Prado
El Proyecto Aracne, herramienta desarrollada por el equipo de investigación de Tratamiento de Señales y Comunicaciones de la ETSI en colaboración con el Museo Nacional del Prado, permite la catalogación y data de obras de arte a través de la urdimbre de los hilos que componen los lienzos.

Lun, 04/01/2021 - 12:04 | dircom2
Identifican una nueva proteína que repara el ADN
Investigadores de diversas universidades identifican una nueva proteína que permite reparar el ADN. Los criptocromos evolucionan hasta adquirir ésta y otras funciones dentro de la célula.

Lun, 28/12/2020 - 11:36 | dircom7
Tener plantas en casa mejoró el bienestar psicológico durante el confinamiento
Un 40% de los encuestados en esta investigación ha mostrado su voluntad de aumentar el número de plantas en casa tras el confinamiento

Mar, 22/12/2020 - 10:04 | dircom7
La permisividad familiar y una baja autoestima aumentan el consumo de alcohol en adolescentes
Expertos de la Universidad de Sevilla trabajan en el programa ‘Alerta Alcohol’ con el objetivo de minimizar este consumo en los jóvenes españoles

Vie, 18/12/2020 - 10:33 | dircom2
Investigadores de la US exponen el severo impacto ambiental del alga asiática
Fundaciones Cepsa y de Investigación de la US avanza en su conocimiento del alga Rugulopteryx okamurae y su comportamiento en el medio marino

Jue, 17/12/2020 - 10:15 | dircom7
Nuevas estructuras moleculares asociadas a la enfermedad de ELA
Investigadores de la US y CABIMER han identificado la asociación de esta enfermedad con la acumulación en el genoma de híbridos ADN-ARN

Mar, 15/12/2020 - 12:03 | dircom7
Una explicación a la falta de oxigenación de la sangre que ocurre en muchos enfermos de COVID-19
Un grupo de investigación del IBIS ha mostrado la presencia en el cuerpo carotídeo humano, órgano sensor del oxígeno de la sangre, de la proteína (ECA2) mediante la que el SARS-CoV-2 infecta las células.

Lun, 14/12/2020 - 12:31 | dircom7
Un “supermicroscopio” único en el mundo permite a científicos sevillanos resolver uno de los enigmas de la biología básica
Los investigadores han observado cómo los lípidos distribuyen las proteínas dentro de las células, un descubrimiento que podría abrir la puerta a entender las causas de enfermedades relacionadas con el transporte de proteínas, como el cáncer o enfermedades neurodegenerativas

Lun, 14/12/2020 - 11:38 | dircom7
Un nuevo mecanismo de regulación para eliminar estructuras celulares dañadas por el estrés
Los autores del estudio señalan como componente esencial de esta respuesta celular la familia de factores de transcripción denominada MiT/TFE. Un funcionamiento incorrecto de los mecanismos frente al estrés por ayuno o infección por patógenos puede provocar cáncer y enfermedades autoinmunes

Vie, 11/12/2020 - 09:29 | dircom7
La Fundación “la Caixa” financiará una investigación de la US sobre acoso laboral
El proyecto PREVENT-US para medir y prevenir el acoso y el ciberacoso laboral es uno de los proyectos seleccionados por la Fundación “la Caixa” en su segunda Convocatoria de Investigación Social.

Jue, 10/12/2020 - 10:21 | dircom7
Nuevos restos clarifican la génesis de los monumentos megalíticos de Antequera
Investigadores de la US documentan un nuevo recinto funerario que adelanta en varios siglos el desarrollo del megalitismo en la región

Mié, 09/12/2020 - 09:46 | dircom7
Un investigador de la US recibe 1,8 millones del ERC para estudiar la historia del Mediterráneo profundo
El profesor Lino Camprubí recibe una Consolidator Grant del Consejo Europeo de Investigación (ERC) para desarrollar su proyecto DEEPMED

Mié, 09/12/2020 - 08:37 | dircom7
Las personas diagnosticadas de esteatosis hepática con fibrosis avanzada presentan mayor riesgo de diabetes e hipertensión
Investigadores del CIBEREHD en el Instituto de Biomedicina de Sevilla (IBiS) demuestran que la esteatosis hepática metabólica, o enfermedad del hígado graso no alcohólico, puede jugar un papel catalítico en el desarrollo de comorbilidades asociadas al síndrome metabólico, como la diabetes tipo 2, hipertensión arterial y dislipemia

Mié, 02/12/2020 - 11:32 | adminUS
Taller para la preparación de propuestas Starting Grant 2021
La compañía Yellow Research imparte un taller online sobre cómo presentar propuestas de éxito en ERC StG 2021

Mié, 02/12/2020 - 11:03 | dircom2
La investigadora Sandra R. Piedrabuena recibe dos premios nacionales por su tesis de griego clásico
Estos premios evidencian la relevancia que siguen teniendo los estudios clásicos en la Universidad de Sevilla

Mar, 01/12/2020 - 09:07 | dircom7
El IBIS identifica marcadores de infección por la COVID-19 a través de análisis de sangre
El ciclo de seminarios del Área de Enfermedades Hepáticas, Digestivas e Inflamatorias presenta un estudio que identifica valores de 6 biomarcadores bioquímicos vinculados a la sospecha de infección por el virus SARS-COV-2

Lun, 30/11/2020 - 09:10 | dircom7
Obtienen anticuerpos capaces de reconocer específicamente células tumorales humanas
Un grupo de investigación de la Universidad de Sevilla consigue un nuevo avance en la búsqueda de una vacuna contra el cáncer

Vie, 27/11/2020 - 08:42 | dircom7
Sevilla participa con 80 actividades en una edición online de la Noche Europea de l@s Investigador@s
Más de 200 representantes del CSIC, la UPO, la US y el JRC hablarán del reciclaje en las células, las energías renovables o la fabricación de cañones en Sevilla, entre otras muchas propuestas. Las actividades se podrán seguir desde las 17.00 horas a través de la web del evento

Jue, 26/11/2020 - 12:03 | dircom7
Investigadores del IBIS avanzan en la búsqueda de nuevos tratamientos frente a infecciones por bacterias productoras de carbapenemasas
El Grupo 'Resistencias bacterianas y Antimicrobianos' del Instituto de Biomedicina de Sevilla – IBiS/Hospitales Universitarios Virgen del Rocío y Macarena/US/CSIC publica resultados de un estudio preclínico colaborativo con la Universidad de Friburgo (Suiza)

Mar, 24/11/2020 - 08:30 | dircom7
Primera revisión exhaustiva de fósiles recuperados en yacimientos arqueológicos ibéricos
Un equipo interdisciplinar de varias universidades y centros de investigación españoles analiza más de 600 fósiles recuperados en la Península Ibérica

Mar, 17/11/2020 - 09:12 | dircom7
La inclusión de aceite de acebuchina en la dieta ayuda a reducir la hipertensión arterial
La dieta enriquecida en aceite de acebuchina reduce el estrés oxidativo producido por la hipertensión en mayor grado que el aceite de oliva virgen extra a nivel retiniano

Jue, 12/11/2020 - 10:25 | dircom7
Las metástasis cerebrales provocan un daño cerebrovascular grave que puede ser inhibido mediante tratamiento
El control de estos daños podría limitar el deterioro neurológico de estos pacientes

Mié, 11/11/2020 - 16:08 | dircom6
Democracia digital. De las tecnologías de representación a la expresión ciudadana
Los investigadores Francisco Sierra-Caballero y José Candón-Mena firman este nuevo estudio publicado por Comunicación Social Ediciones y Publicaciones

Mié, 11/11/2020 - 15:06 | dircom7
Sevilla celebra de forma virtual la Noche Europea de l@s Investigador@s el próximo 27 de noviembre
Más de 200 investigadores e iinvestigadoras del Consejo Superior de Investigaciones Científicas (CSIC), la Universidad de Sevilla (US) y la Universidad Pablo de Olavide (UPO) ofrecerán casi 80 actividades divulgativas online para acercar la ciencia a la sociedad, con el apoyo del Centro Común de Investigación (JRC, Joint Research Centre) en Sevilla, el Ayuntamiento Hispalense y la Fundación Cajasol

Mié, 11/11/2020 - 11:25 | dircom7
La importancia de la ventilación de los hogares durante la segunda ola de COVID
Una investigación compara la calidad de aire antes y después del confinamiento en cuatro viviendas tipo y detecta una mayor cantidad de dióxido de carbono, compuestos orgánicos y las partículas finas durante el confinamiento

Vie, 06/11/2020 - 12:04 | adminUS
Las consecuencias de explotar las profundidades oceánicas
El trabajo se ha centrado en el estudio de la poco conocida zona Mesopelágica o Twlight Zone, situada aproximadamente entre los 200 y los 1.000 metros de profundidad

Vie, 06/11/2020 - 08:55 | dircom6
Beatriz Prado Campos publica el libro 'Conservación y Restauración de Material Pétreo'
La obra aborda aspectos como la materialidad, la técnica de ejecución o las alteraciones del material pétreo

Mar, 03/11/2020 - 12:48 | dircom2
Premiado un artículo del Laboratorio de Robótica de la ETSI
Miembros del Grupo de Robótica, Visión y Control de la ETS de Ingeniería de la US ganan el IEEE IROS Best Application Paper Award, en el congreso de robótica de mayor prestigio internacional

Mié, 28/10/2020 - 11:06 | dircom7
El desierto de Atacama era mucho más húmedo hace cien mil años
La acumulación de sedimentos en este entorno ofrece un archivo cronológico de millones de años que permite estudiar mejor la evolución de la tierra

Vie, 23/10/2020 - 11:54 | adminUS
Andalucía celebra el 27 de noviembre La Noche Europea de l@s investigador@s más virtual
- Más de 2.500 investigadores e investigadoras acercarán su trabajo a la ciudadanía con más de 500 actividades online y presenciales
- La cita garantiza las medidas de seguridad para hacer frente a la COVID-19 y oferta parte de su programación de forma virtual

Mar, 20/10/2020 - 13:41 | dircom7
El CNA colabora con el Ministerio de Transición Ecológica en la lucha contra el tráfico de marfil
La acción se enmarca dentro del Plan de Acción Español Contra el Tráfico Ilegal y el Furtivismo Internacional de Especies Silvestres

Lun, 19/10/2020 - 09:32 | dircom7
Un modelo pionero sobre atención social para las personas mayores
La US coordina el proyecto TEC-MED, en el que han participado 350 expertos de la atención y el cuidado asistencial procedentes de seis países de la cuenca mediterránea

Vie, 16/10/2020 - 10:02 | dircom7
La revista Ámbitos presenta su número 50
La revista decana de la investigación en Comunicación en la universidad andaluza celebra la publicación de su número 50 después de más de 20 años de publicación ininterrumpida.

Mar, 13/10/2020 - 11:54 | dircom2
Avanza el trabajo de los arqueólogos en el Templo de Tutmosis III en Luxor
El equipo, dirigido por la egiptóloga sevillana Myriam Seco, cuenta este año con 17 arqueólogos y técnicos para la 13ª Campaña de excavación, que tiene al teletrabajo y las mascarillas como novedad

Mié, 30/09/2020 - 17:01 | dircom6
La mitad de los universitarios españoles, sin conocimientos sobre la Teoría de la Evolución
Los estudiantes de Biología son los que más la conocen y los del grado de Estudios Ingleses los que menos

Mar, 29/09/2020 - 11:35 | dircom7
Descubren nuevas especies de gramíneas endémicas de la Península Ibérica y Menorca
Investigadores de la Universidad de Sevilla han desarrollado este estudio en colaboración con expertos de Universidad Autónoma de Barcelona y de las Islas Baleares

Jue, 24/09/2020 - 15:51 | dircom6
Algoritmos Genéticos con Python: un Enfoque Práctico para Resolver Problemas de Ingeniería
Investigadores de la Universidad de Sevilla publican con la Editorial Marcombo este volumen sobre una de las herramientas más prometedoras del momento

Jue, 24/09/2020 - 11:37 | dircom7
Los estudiantes usaron más de 8 horas al día el móvil durante el confinamiento
El estudio destaca que los que más usaban el móvil dedicaban menos horas a la actividad física y presentaban peor calidad del sueño

Mar, 22/09/2020 - 11:19 | dircom2
Fallados los XIII Premios Fama a la trayectoria investigadora
Los investigadores premiados son Pablo Emilio Pérez-Mallaína, Emilio Carrizosa, Alvaro Pascual, Josefina Cruz y María Mercedes Valera.

Vie, 18/09/2020 - 10:57 | Anónimo
Fabricación de parches con microagujas para estudios de liberación controlada mediante radio marcaje y modelos de difusión in vitro
Las microagujas generan microporos en el estrato córneo, salvando esta barrera de absorción y permiten la liberación de moléculas a través de la piel

Jue, 17/09/2020 - 11:58 | dircom7
Un nuevo conservante que podría sustituir al dióxido de azufre del vino
La reducción del dióxido de azufre en el vino es una demanda del consumidor porque produce efectos alérgicos en personas sensibles

Mar, 15/09/2020 - 12:04 | dircom7
Descubren un nuevo monumento megalítico en Antequera
El equipo de la US que lleva más de 10 años trabajando en la zona sigue avanzando en la descripción de los usos que pudo tener la zona durante la prehistoria
Vie, 11/09/2020 - 09:22 | Anónimo
El Puerto de Sevilla realiza las primeras pruebas del proyecto europeo Blueports para el tratamiento de las aguas de lastre
La Universidad de Sevilla, el Acuario y la empresa AGQ Labs participan en la toma de muestras y en el estudio de la biota adherida al casco de un buque portacontenedores

Jue, 10/09/2020 - 12:42 | dircom7
Bioplaguicidas para ayudar a salvar el patrimonio olivarero
El proyecto BIOVEXO busca un bioplaguicida sostenible y eficaz contra una bacteria que ataca principalmente al olivar y se está extendiendo a otras como el almendro

Mié, 09/09/2020 - 09:21 | dircom6
El Hospital Virgen del Rocío imprime cerebros en 3D para operar tumores complejos con total seguridad
Su mayor utilidad se está viendo en operaciones de tumores cerebrales que suelen realizarse con el paciente despierto porque el tumor está muy cerca del zona del habla o de la regulación motora

Mar, 08/09/2020 - 10:15 | dircom7
Identifican detalles desconocidos en los templetes del patio de los Leones en la Alhambra
Expertos de la Universidad de Sevilla, la École Polytechnique Fédérale de Lausanne (Suiza) y la Universidad de Granada colaboran en esta investigación que ha documentado detalles del monumento que hasta ahora eran prácticamente desconocidos

Lun, 07/09/2020 - 13:04 | dircom7
Un manual para la interpretación de electrocardiogramas
La obra, elaborada durante el confinamiento por la COVID-19, es la primera publicación realizada por un alumno y un profesor sobre la actividad docente más demandada en el Grado de Medicina

Lun, 31/08/2020 - 12:31 | dircom7
En la actualidad existe solo una decena de especies de abetos mediterráneos
Los abetos son especies clave para mantener la biodiversidad y una importante fuente de recursos forestales con un gran impacto económico

Mié, 26/08/2020 - 10:50 | adminUS
Un joven doctorado de la US lidera un grupo de investigación en Cambridge
Miguel Anaya trabaja en el estudio de dispositivos optoelectrónicos de nueva generación

Mar, 25/08/2020 - 12:32 | dircom2
Tecnología para mejorar la salud ósea en mujeres premenopáusicas
Expertos de la Universidad de Sevilla emplean pulseras inteligentes para evaluar los beneficios de la actividad física en este grupo de población

Mar, 25/08/2020 - 12:12 | dircom2
Cómo mejorar la calidad del aire en las aulas
Investigadores de la Universidad de Sevilla analizan la presencia de contaminantes del aire interior y exterior en el entorno de edificios escolares andaluces

Vie, 21/08/2020 - 11:30 | dircom2
Desarrollan una alternativa sostenible a la vinificación tradicional
Investigadores de la Universidad de Sevilla apuestan por la adición de viruta cruda de madera de roble para estabilizar el color del vino

Mar, 18/08/2020 - 12:16 | dircom2
La sobrecarga de enfermería también determina la mortalidad de los pacientes durante la hospitalización
Este trabajo se ha desarrollado en 11 hospitales del Sistema Sanitario Público Andaluz y concluye que cada paciente adicional que sobrecarga a una enfermera, aumenta probabilidad de morir un 19%

Mar, 11/08/2020 - 11:47 | dircom2
Relación entre el estado de salud de las familias y la calidad constructiva de sus casas
Investigadores de la US han desarrollado un modelo que permite valorar el coste que supone para el Servicio Andaluz de Salud el estado de pobreza energética en hogares vulnerables

Vie, 07/08/2020 - 11:36 | dircom2
Descubren nuevos marcadores para mejorar el diagnóstico de la diarrea crónica en niños
Los mencionados resultados descubiertos por expertos de la US permiten abrir una nueva línea en el desarrollo de mejores métodos de diagnóstico de esta patología que, según la Organización Mundial de la Salud (OMS), afecta a entre un 3- 5% de la población infantil en el mundo

Mar, 04/08/2020 - 11:54 | dircom2
Expertos de la US identifican un proceso natural en los suelos nunca antes descrito
En este trabajo de investigación se describe un proceso mediante el cual algunos minerales del suelo pueden convertir los gases de nitrógeno en nitratos a partir de la radiación visible y ultravioleta

Vie, 31/07/2020 - 11:45 | Anónimo
Mejora los hábitos alimenticios a través de la app móvil de nutrición SAlBi educa
En este momento, los creadores de la aplicación buscan usuarios con los que probar la eficacia de la misma

Mié, 29/07/2020 - 12:11 | dircom2
Manila y su Real Audiencia. Convivencia y conflicto (1584-1630)
Esta publicacion de la EDUS analiza la relación entre los miembros de la Real Audiencia de Manila y la sociedad del momento

Mié, 22/07/2020 - 09:31 | dircom7
El estudio de los nichos de los sapos parteros incluyendo linajes intraspecíficos revela su evolución
Estudiar los nichos ecológicos de las diferentes especies permite a los investigadores conocer la evolución de estas y predecir acontecimientos

Lun, 20/07/2020 - 10:22 | adminUS
US participa en TARSIS, nuevo espectrógrafo para el observatorio Calar Alto
Es un espectrógrafo único capaz de explorar áreas del cielo de un tamaño sin precedentes en espectroscopia, optimizado para el rango UV-A y alcanzando longitudes de onda tan azules e inexploradas como 320 nanómetros

Mar, 14/07/2020 - 12:38 | Anónimo
Doctorando de la US, primer premio en la 'ACM Student Research Competition'
Este premio, patrocinado por Microsoft, nunca antes había sido conseguido por un estudiante español o una universidad española

Mar, 14/07/2020 - 11:09 | dircom7
Relacionan el comienzo de la primavera biológica en África con la cantidad de horas de sol
Un estudio de la Universidad de Sevilla discute la idea de que este fenómeno se deba a la llegada de las lluvias, como se creía hasta el momento, y destaca la influencia de diversos factores entre los que el más importante son las horas de sol

Mar, 14/07/2020 - 10:45 | dircom6
Imágenes de rayos X de los pulmones para diagnosticar la COVID-19
Profesionales del ámbito médico de todo el mundo llevan volcando radiografías pulmonares desde el inicio de la pandemia

Vie, 10/07/2020 - 13:24 | dircom7
Conservación y restauración de encarnaciones polícromas
La profesora de la US María José González López acaba de publicar esta monografía que analiza uno de los aspectos más desconocidos de la escultura en madera

Jue, 09/07/2020 - 11:49 | dircom7
Identifican una copia inédita de 'Historia de los reyes moros de Granada'
El hallazgo, realizado en la Real Biblioteca de Madrid por una investigadora de la US, ha permitido atribuir la obra a su autor original y definir correctamente su procedencia

Mar, 07/07/2020 - 09:18 | Anónimo
Tesis realizada en la US, galardonada en Italia con el Premio Nazionale Di Biase-Laveglia
Esta tesis fue realizada en régimen de cotutela junto a la Universidad de Nápoles Federico II

Lun, 06/07/2020 - 12:25 | dircom7
La US acogerá el congreso de la Sociedad Matemática Europea
La cita, que se celebra cada cuatro años, es el segundo encuentro más importante del mundo en el ámbito de las matemáticas

Mié, 01/07/2020 - 12:57 | adminUS
Cinco unidades de excelencia para impulsar la calidad de la investigación de la US
Estas unidades científicas destacan por su relevancia e impacto a nivel internacional y cuentan con investigadores que tienen un altísimo nivel de publicaciones científicas de calidad, proyectos de investigación y acciones de transferencia de conocimiento

Mar, 30/06/2020 - 11:53 | dircom7
Una investigadora del IMUS gana el premio Vicent Casselles
Los galardones, concedidos por la Fundación BBVA y la Real Sociedad Matemática española, han reconocido a representantes del IMUS en las tres últimas ediciones

Lun, 29/06/2020 - 10:47 | adminUS
Reducir el coste eléctrico de las fábricas de cemento con técnicas de inteligencia artificial
La US y el sector cementero andaluz ponen en marcha un proyecto de investigación industrial en el marco de un Programa de Doctorado

Mar, 23/06/2020 - 12:21 | dircom7
Las acciones Marie Skłodowska-Curie reconocen a tres investigadoras de la US
Las tres estudiantes de doctorado en el IMUS han sido designadas como 'Special Fellows of the Week'

Mar, 23/06/2020 - 10:48 | dircom7
Prueban la eficacia de un sistema de alerta ambiental para vigilar el litoral
El método SBPQ se basa en el estudio de la evolución de ciertas especies marinas con potencial bioindicador para detectar cambios que puedan indicar alteraciones en el entorno

Vie, 19/06/2020 - 11:37 | dircom7
La US participa en un proyecto europeo sobre inscripciones latinas en verso
El estudio analizará unas 4.000 inscripciones latinas en verso grabados sobre monumentos públicos que constituyen la fuente más importante para entender el arte y cultura popular en el mundo romano

Lun, 15/06/2020 - 12:10 | dircom7
Perspectiva de género en los museos pedagógicos universitarios
Los investigadores han evaluado hasta qué punto y cómo los ocho Museos Pedagógicos Universitarios españoles están desarrollando un trabajo activo por la igualdad y la no discriminación

Lun, 15/06/2020 - 11:08 | dircom7
Desciende el riesgo ambiental veinte años después del accidente de la mina de Aznalcóllar
Investigadores de la Universidad de Sevilla compararon las concentraciones de metales en sedimentos del río Guadiamar de 2002 y 2018

Mié, 10/06/2020 - 12:00 | Anónimo
Investigadores de la US publican el catálogo 'Ciudades medias de la Bética interior'
Este libro se ha publicado con motivo de la exposición 'IMPACT. Ciudades medias de la Bética Interior'

Mar, 09/06/2020 - 10:56 | dircom7
Identifican un nuevo mecanismo molecular del proceso de reparación del ADN humano
Las mutaciones del material genético celular pueden derivar en enfermedades neurodegenerativas o cáncer

Lun, 08/06/2020 - 09:11 | Anónimo
El egresado Vito Lamberti presenta su proyecto de innovación arquitectónica ante Google, Ford y Daikin
Este proyecto de investigación ha sido presentado en el Industry Advisory Board Meeting de la Universidad de Berkeley con el objetivo de conseguir financiación

Jue, 04/06/2020 - 10:50 | dircom7
Descifran el papel de una proteína humana en la transcripción y la estabilidad del ADN
Investigadores de la Universidad de Sevilla y Cabimer señalan que la proteína UAP56 / DDX39B es esencial para eliminar híbridos ADN-ARN del genoma

Mar, 02/06/2020 - 08:54 | adminUS
Primera edición del GPU Days Universidad de Sevilla 2020
El evento tendrá lugar los días 8, 9 y 10 de junio, se desarrollará a través de la herramienta Collaborate y será gratuito

Mié, 27/05/2020 - 13:54 | Anónimo
Cuestionario para visibilizar la Sensibilidad de Procesamiento Sensorial
Éste es un estudio pionero desarrollado por alumnos de la US que da visibilidad a lo coloquialmente conocido como Alta Sensibilidad

Mar, 26/05/2020 - 11:26 | dircom7
Un paso más en la lucha contra el neuroblastoma
Un estudio publicado por expertos de la Universidad de Sevilla y el IBiS indica que la proteína CD44 puede contribuir al comportamiento agresivo de las células madre cancerosas y a la aparición de metástasis

Vie, 22/05/2020 - 19:43 | adminUS
La Escuela de São Paulo presenta un curso sobre Diplomacia Científica y de la Innovación
La segunda edición tendrá como tema principal el área de la salud y se basará en un curso intensivo con modalidad a distancia

Vie, 22/05/2020 - 14:37 | dircom7
Los Servicios Generales de Investigación de la US reabren sus puertas
El personal investigador podrá acceder a los laboratorios con cita previa a partir del 25 de mayo

Vie, 22/05/2020 - 11:36 | dircom7
Cirugía fetal para combatir la espina bífida
Investigadores de la US han colaborado con el Hospital Virgen del Rocío en 11 operaciones para corregir esta patología en fetos mediante intervenciones intrauterinas

Vie, 22/05/2020 - 10:42 | dircom7
El Instituto de Astrofísica de Andalucía se une al proyecto para la detección de COVID-19 en superficies
El IAA aportará estudios de polarimetría al proyecto, que ya combina la adquisición de imágenes en todo el rango óptico y submilimétrico y su análisis con inteligencia artificial

Vie, 22/05/2020 - 09:46 | Anónimo
Una tesis desarrollada en la US, premiada por la Asociación Ibérica de Limnología
Esta tesis se desarrolló en el Programa de Doctorado de Biología Integrada del Departamento de Biología Vegetal y Ecología

Mié, 20/05/2020 - 07:50 | dircom7
El bienestar de los adolescentes desciende conforme se hacen mayores
El informe HBSC, que analiza la salud física, las relaciones sociales y el bienestar mental de escolares de 11 a 15 años procedentes de 45 países, destaca también el descontento de los alumnos con el sistema escolar

Mar, 19/05/2020 - 09:49 | dircom7
El aceite de orujo de oliva disminuye la obesidad
Este estudio pone de relieve, además, el valor biológico y nutricional del orujo de oliva como alimento funcional

Mié, 13/05/2020 - 12:45 | Anónimo
Nace el Proyecto Colonia Aelia Augusta Italica
Este proyecto, dirigido por profesores de la US, pretende investigar el desarrollo urbano de Itálica desde sus inicios hasta su abandono en la Edad Media

Mar, 12/05/2020 - 11:04 | dircom7
"Filman" por primera vez una medición cuántica
Los resultados muestran que no es un proceso instantáneo

Mar, 05/05/2020 - 11:20 | dircom7
Analizan la calidad del aire en las escuelas andaluzas
Un estudio de la Universidad de Sevilla señala que del nivel de CO2 presente en las aulas analizadas superaba habitualmente el valor máximo recomendado por la Organización Mundial de la Salud

Lun, 04/05/2020 - 10:41 | dircom7
CABIMER se une a la realización de pruebas PCR para la detección de COVID-19
El Instituto de Salud Carlos III ha validado al centro sevillano para la realización de estas pruebas

Mar, 28/04/2020 - 13:37 | dircom7
La Noche Europea de los Investigadores de Andalucía consigue financiación europea
La cita se cambia este año su fecha habitual y se celebrará el 27 de noviembre

Mar, 28/04/2020 - 11:50 | dircom7
Validan al IBIS para la realización de PCR para el diagnóstico de COVID-19
El centro sevillano se une a más de una veintena de instituciones de toda España que ya dan apoyo a las autoridades sanitarias

Mar, 28/04/2020 - 11:05 | dircom7
La calidad del aire en Andalucía durante el periodo de confinamiento
Investigadores de la US analizan los datos ambientales registrados en los días de confinamiento y los compararán con datos anteriores a marzo de 2020 y con registros futuros una vez vuelva a retomarse la actividad
Mar, 21/04/2020 - 12:15 | dircom7
La importancia del tiempo de reacción ante una pandemia
Un grupo de investigadores presenta un estudio que plantea los posibles efectos de haber adelantado el confinamiento en España

Lun, 20/04/2020 - 11:44 | dircom6
Investigadores de la US analizan la evolución de los perfiles masculinos en el cine español
El equipo coordinado por el profesor Juan Rey aborda desde los inicios de la dictadura franquista hasta la actualidad
Mié, 15/04/2020 - 12:33 | dircom7
Investigadores de la US se unen a la comunidad de investigadores en neuromórfica de Intel
Miembros del Robotics and Technology of Computers Lab de la US colaborarán con la empresa para desarrollar nuevas herramientas basadas en sensores auditivos

Mar, 14/04/2020 - 10:47 | dircom7
Investigadores andaluces reciben financiación del Ministerio de Ciencia e Innovación para diseñar un dispositivo que permita «ver» el coronavirus depositado en las superficies
El Instituto de Salud Carlos III aporta medio millón de euros para la investigación de un prototipo que permita el análisis rápido y sin contacto de superficies contaminadas por el SARS-CoV-2 combinando sistemas de adquisición de imágenes en todo el rango óptico y de terahercios y su análisis con Inteligencia Artificial

Lun, 13/04/2020 - 13:43 | dircom2
Investigadores del IBIS trabajan en fármacos y terapias frente al COVID-19
El Instituto de Biomedicina de Sevilla presta su personal, sus instalaciones y equipos, para desarrollar ensayos clínicos en la lucha contra el COVID-19

Lun, 13/04/2020 - 13:29 | dircom7
Investigan el poder de cítricos y frutos rojos contra el COVID-19
Un profesor de la US pretende demostrar los beneficios de ingerir cítricos y frutos rojos para combatir el COVID-19 y reducir sus efectos

Mié, 08/04/2020 - 10:29 | dircom7
¿Cuáles son las consecuencias del confinamiento?
Investigadores de la US lanzan una encuesta online para evaluar las consecuencias del confinamiento decretado por el Gobierno de España a causa de la crisis sanitaria generada por el COVID-19

Jue, 02/04/2020 - 13:14 | dircom7
Rafael Fernández-Chacón asume la dirección del IBIS
Los doctores Rafael Fernández-Chacón, como director científico, y José Antonio Pérez Simón, como vicedirector, sustituyen a José López-Barneo, director científico del centro desde la fundación del IBIS en 2006

Mié, 01/04/2020 - 15:37 | dircom6
Modelado y análisis de la evolución de una epidemia vírica mediante filtros de Kalman: el caso del COVID-19 en España
El grupo de investigación TEP196 Sistemas de Energía Eléctrica de la Universidad de Sevilla publica diariamente una estimación de la predicción de la evolución del COVID-19 en España

Mié, 01/04/2020 - 12:33 | dircom2
FABLAB de la US fabrica protectores faciales
La fabricación de este material se hará posible con la colaboración de más de 300 voluntarios

Vie, 27/03/2020 - 11:46 | Anónimo
El SAV desarrolla nuevos recursos de realidad ampliada sobre Ingeniería y Biotecnología
Estas producciones han sido elaboradas, trabajando desde casa, por el equipo técnico del SAV en constante comunicación con los profesores e investigadores participantes en el proyecto #USenCasa

Lun, 23/03/2020 - 12:16 | dircom6
La cooperación al desarrollo desde la prevención comunitaria: Edúcame Primero Honduras
Estancia postdoctoral de la Fundación Carolina y la Secretaría General de Iberoamérica en Honduras

Lun, 09/03/2020 - 11:54 | dircom7
Un proceso natural para convertir gases en nitratos
Una investigación describe cómo algunos minerales del suelo pueden convertir los gases de nitrógeno en nitratos a partir de la radiación visible y ultravioleta

Vie, 06/03/2020 - 11:45 | Anónimo
V Semana del Cerebro en la Universidad de Sevilla
Esta celebración mundial representa una oportunidad para mostrar los avances del estudio científico del cerebro
Mié, 04/03/2020 - 10:54 | adminUS
Convocatoria 2020 de becas de investigación FUNDAME
La Fundación Alfonso Martín Escudero convoca 40 becas para realizar trabajos de investigación en universidades o centros de investigación en el extranjero

Lun, 02/03/2020 - 13:30 | adminUS
Desarrollan una herramienta para la detección de especies invasoras en el Estrecho
Expertos de la Universidad de Sevilla han puesto a punto esta técnica que puede aplicarse también para el control del calentamiento global

Jue, 27/02/2020 - 11:28 | dircom2
Manifiesto sobre las hablas andaluzas
Con motivo del 40 aniversario de la autonomía, el Grupo de Investigación HUM-134 "El español hablado en Andalucía" ha elaborado un manifiesto sobre las hablas andaluzas.

Mié, 26/02/2020 - 13:02 | dircom2
Iberian Robotics gana el Challenge 3 de la competición de robótica más importante del mundo
El catedrático de la ETS de Ingeniería de la Universidad de Sevilla Aníbal Ollero coordina el proyecto ganador

Mié, 26/02/2020 - 09:52 | dircom6
La US colabora en la planificación del espacio marítimo de los archipiélagos macronésicos de la UE
La Universidad de Sevilla es la encargada de elaborar el atlas. El canal internacional de noticias Euronews se ha hecho eco de este proyecto.

Lun, 24/02/2020 - 11:53 | dircom2
Ocho investigadores de la US reciben el 'Premio Joven a la Cultura Científica'
El Ayuntamiento de Sevilla galardona a ocho investigadores de la Universidad de Sevilla por promocionar la cultura científica a través de su trabajo

Vie, 21/02/2020 - 09:13 | dircom7
La US capta más de 800.000 euros del programa Marie Curie para financiar cuatro proyectos de investigación
Una fase de la investigación se desarrollará en la US y otra en universidades de Sudáfrica o Estados Unidos

Mié, 19/02/2020 - 11:17 | dircom7
Expertos internacionales debaten en CABIMER sobre la integridad de los genomas
CABIMER dedica su primer congreso internacional a las nuevas tendencias en la inestabilidad y dinámica de los genomas

Lun, 17/02/2020 - 13:21 | dircom7
La actividad de hornos de fundición en la Real Fábrica de Artllería de Sevilla fue continuada en el tiempo
El trabajo, desarrollado en los laboratorios del CITIUS, ha permitido también analizar la composición de las aleaciones empleadas en los procesos tecnológicos de fabricación de elementos militares

Vie, 14/02/2020 - 13:37 | Anónimo
Investigadores demuestran que problemas topológicos en el ADN pueden provocar linfomas
En esta investigación colaboran científicos y científicas del CNIO y CABIMER, instituto mixto formado por el CSIC, la Junta de Andalucía, la Universidad Pablo de Olavide y la Universidad de Sevilla

Mié, 12/02/2020 - 15:10 | dircom6
Lanzamiento del proyecto 'Paisaje y sociedad: análisis de la percepción social en paisajes culturales (PAYSOC)'
El uso de la etnografía virtual se sitúa en el epicentro de este proyecto centrado en paisajes culturales

Mar, 11/02/2020 - 13:32 | dircom7
La US celebra el Día Internacional de la Mujer y la Niña en la Ciencia
Diversas actividades tratan de fomentar las vocaciones científicas entre las jóvenes y visibilizar el papel de la mujer investigadora con motivo del 11 de febrero

Mar, 11/02/2020 - 12:11 | Anónimo
Fabio Passos es premiado por la European Design and Automation Association
El premiado fue alumno de la Universidad de Sevilla, lugar donde desarrolló la tesis con la que ha sido galardonado

Lun, 10/02/2020 - 12:05 | dircom2
La US, en la competición internacional de drones en Abu Dabi
La US participa con el equipo Iberian Robotics, liderado por el catedrático Aníbal Ollero.

Vie, 07/02/2020 - 09:25 | Anónimo
La US ofrece cerca de un centenar de actividades de divulgación en 2019
La Universidad de Sevilla mantiene así un firme compromiso en el apoyo a la divulgación y difusión de su actividad de investigación y transferencia del conocimiento

Jue, 06/02/2020 - 13:28 | dircom2
Efectos de la Inteligencia Artificial en la Medicina y la Salud de las Personas
Investigadores de la US y del Joint Research Centre proponen la primera clasificación de los sistemas de Inteligencia Artificial en Medicina y Salud

Mié, 05/02/2020 - 11:42 | dircom7
Dos profesores de la US distinguidos como 'fellows' del IEEE
La Universidad de Sevilla se coloca como la institución española que más 'fellows' tiene en esta sociedad de Ingeniería Electrónica

Jue, 30/01/2020 - 15:18 | dircom7
Los VII Premios Manuel Losada Villasante reconocen la labor de tres investigadores de la US
Francisco Gancedo, Enrique Mateos y Lara Ferrándiz han sido los elegidos por el jurado de los premios Losada Villasante

Mar, 28/01/2020 - 09:13 | Anónimo
Un grupo multidisciplinar de investigadores de la US desarrolla un proyecto de investigación aplicada en Honduras
Este grupo formado por profesores, investigadores y estudiantes llevará a cabo acciones participativas los próximos días 10, 11 y 12 de febrero en la Antigua Casa Presidencial de la capital

Mar, 21/01/2020 - 09:58 | Anónimo
Publicado el número 47 de Ámbitos. Revista Internacional de Comunicación
La revista acaba de publicar su número 47 correspondiente al Invierno de 2020. La edición está compuesta principalmente por un monográfico centrado en el universo transmedia en el ámbito universitario así como por artículos sobre tratamiento informativo, videojuegos, publicidad y violencia de género
Lun, 20/01/2020 - 12:50 | dircom7
Una herramienta consigue disminuir el riego de los olivos en más de un 20%
El ‘índice de hidrosostenibilidad’ promueve el uso de buenas prácticas agrícolas relacionadas con el agua, al tiempo que ofrece un valor añadido al consumidor

Mié, 15/01/2020 - 09:03 | dircom7
¿Cómo colaborar con The Conversation desde la US?
La Universidad de Sevilla y The Conversation mantienen una colaboración que permite al personal investigador de la US participar en la creación de contenidos de este portal de divulgación y poner así al alcance de la sociedad su conocimiento.

Jue, 09/01/2020 - 13:13 | dircom7
Iluminación biodinámica para fomentar la salud
Investigadores de la US proponen adecuar la iluminación artificial dentro de los edificios para favorecer los ritmos circadianos

Mié, 08/01/2020 - 12:27 | Anónimo
Calendario 2020 de las Químicas, Físicas, Biólogas y Matemáticas de la US
Este calendario ilustrado y con pequeñas reseñas, tiene como objetivo visibilizar la labor de todas las científicas de la Universidad de Sevilla

Mié, 08/01/2020 - 09:27 | dircom7
Impresión 3D con aplicaciones en la industria farmacéutica
Investigadores de la US consiguen por primera vez imprimir una imagen 3D con nanopartículas de oro estabilizadas con sistemas poliméricos biodegradables y biocompatibles

Vie, 03/01/2020 - 11:21 | adminUS
Los mayores de 55 años usarían más la banca online si fuera más intuitiva
Expertos de la Universidad de Sevilla aseguran que la ansiedad tecnológica que sufren algunas personas de este colectivo viene generada por la falta de confianza en sí mismos para desenvolverse en internet

Vie, 20/12/2019 - 11:04 | adminUS
Nuevas baterías de iones de litio más eficientes y seguras
Las baterías de iones de litio han revolucionado la tecnología de dispositivos portátiles, y su uso está hoy en día generalizado en teléfonos móviles y ordenadores portátiles
Mié, 18/12/2019 - 09:29 | dircom2
Reconocimienro al libro 'Ecija Artística'
El libro Écija artística , publicado por la EUS, ha sido galardonado con el XI Premio ASCIL a la Mejor Obra de Investigación local en la provincia de Sevilla, concedido por la Asociación Provincial Sevillana de Cronistas e Investigadores Locales (ASCIL).

Lun, 16/12/2019 - 13:23 | dircom7
Decoración de megalitos: mucho más que pintura y grabados
Un equipo de investigadores andaluces define un nuevo concepto relacionado con el megalitismo, el ‘Arte Natural’

Jue, 12/12/2019 - 14:29 | dircom7
El cambio estacional de hora no desalinea los biorritmos humanos
Un estudio de la Universidad de Sevilla subraya las dificultades de una decisión común europea sobre el cambio de hora

Mar, 03/12/2019 - 11:43 | dircom7
Nuevo procedimiento para obtener un material barato, ultraduro y resistente a la radioactividad
El carburo de boro es un material barato y ultrarresistente para el diseño de aviones, trenes, coches y otros medios de transporte

Mié, 27/11/2019 - 12:17 | dircom7
Científicos de la US identifican un nuevo mecanismo de reparación de roturas del ADN
Las roturas cromosómicas pueden provocar la muerte celular si no son reparadas de manera correcta

Mar, 26/11/2019 - 09:47 | adminUS
El profesor Anibal Ollero recoge el Premio Rei Jaume I
Un jurado compuesto por 19 premios Nobel ha destacado la “inestimable capacidad para combinar la excelencia en la investigación y la innovación tecnológica con la transferencia de tecnología” del profesor Ollero

Vie, 15/11/2019 - 12:45 | dircom7
La US invertirá más de 17 millones de euros en equipamiento científico
La US es la primera universidad andaluza en captación de fondos y número de solicitudes concedidas en la última convocatoria del Ministerio de Ciencia, Innovación y Universidades

Mar, 12/11/2019 - 10:50 | adminUS
Gérard Mourou
"La energía nuclear es la mejor energía siempre que sea la energía más limpia, siempre que se puedan transmutar sus residuos"

Jue, 07/11/2019 - 12:44 | dircom7
La resolución de conflictos en el sector de la hostelería
La revista International Journal of Conflict Management, donde han sido publicaods los resultados del estudio, lo ha premiado con la distinción de artículo altamente recomendado

Lun, 04/11/2019 - 12:36 | dircom7
La US lidera un proyecto europeo pionero en la atención social a la tercera edad
Una decena de instituciones de la cuenca del Mediterráneo desarrollarán un modelo único de atención social, transcultural y ético para la población mayor dependiente de esta área

Lun, 21/10/2019 - 11:52 | dircom7
Analizan el mercado laboral español mediante técnicas de Big Data
Sus conclusiones apuntan a que la crisis económica que ha sufrido España ha motivado que se produzcan cambios en la movilidad geográfica y sectorial de los trabajadores

Vie, 18/10/2019 - 15:04 | adminUS
Describen nuevos mecanismos que regulan la inflamación cerebral
El hallazgo puede tener aplicaciones para el tratamiento de enfermedades como el Parkinson y el Alzheimer

Mié, 09/10/2019 - 13:00 | dircom7
Los roles de género en la divulgación de la prehistoria
Un estudio analiza la presencia de hombres y mujeres en documentales sobre prehistoria y las tareas con las que se los asocia

Mar, 08/10/2019 - 11:59 | adminUS
Lola Pons gana el Premio de Periodismo Manuel Azaña 2019
El premio se entregará el próximo 9 de octubre en el teatro de Alcalá de Henares

Mar, 01/10/2019 - 11:42 | dircom7
Arquitectos de la US recrean la desaparecida Puerta de Triana
Conectaba la ciudad con el Aljarafe, se construyó en 1588 y fue demolida en 1868

Jue, 26/09/2019 - 14:08 | adminUS
Los Premios Ebro Foods reconocen la excelencia científica de seis jóvenes investigadores
Tanto el premio como los dos accésits han sido concedidos ex aequo por el alto nivel de los trabajos presentados

Jue, 26/09/2019 - 13:21 | adminUS
Más de 3.000 profesionales participan en Andalucía en La Noche Europea de l@s Investigador@s
Este macroevento científico, convocado por la Comisión Europea, suma casi 700 actividades destinadas a acercar la ciencia y la labor de quienes la ejercen a la ciudadanía de las ocho provincias andaluzas

Mié, 25/09/2019 - 14:05 | adminUS
Casi un centenar de actividades en Sevilla para la Noche Europea de l@s Investigador@s
Alrededor de 200 investigadores e investigadoras de la ciudad se echan a la calle el próximo viernes 27 de septiembre para acercar a la ciudadanía su labor y los conocimientos que generan. Se unen así a sus compañeros de más de 370 ciudades europeas

Mié, 25/09/2019 - 09:41 | dircom7
Más de 400.000 internautas han leído a los investigadores de la US en The Conversation
La Universida de Sevilla cierra su primer año de colaboración con The Conversation con un importante volumen de visitas

Jue, 19/09/2019 - 16:20 | dircom6
El profesor Vázquez Medel visita el Instituto Cervantes de Nueva Delhi
El profesor Vázquez Medel, que participa en un acción de cooperación internacional en la India impulsada por la profesora Clara Astarloa, ha finalizado la primera etapa de su viaje, en la que ha mantenido reuniones con el rector de la Universidad de Goa, Varun Sahni, y la directora del Centre for Latin American Studies, Aparajita Gandopadhyay, orientadas a intensificar la colaboración con la Universidad de Sevilla

Jue, 19/09/2019 - 16:16 | dircom6
César Fornis publica su octava obra: ‘El mito de Esparta’
La publicación del catedrático de la US ha conseguido dos puestos en el ranking general del SPI de Editoriales Españolas

Lun, 16/09/2019 - 17:30 | dircom6
Antonio M. Rabasco, Académico Extranjero Correspondiente en la Academia de Ciencias Farmacéuticas de Brasil
Esta Academia está considerada como una de las más importantes dentro del ámbito farmacéutico

Lun, 16/09/2019 - 17:16 | dircom6
La US estudia la vida microscópica en los suelos salinos del Paraje Natural Marismas del Odiel
Los resultados permiten conocer cómo afectan los factores climáticos y ambientales en el entorno

Mié, 04/09/2019 - 18:50 | adminUS
Gotas de aceite de tamaño nanométrico para facilitar la liberación de principios activos
Investigadores de la Universidad de Sevilla desarrollan una metodología para la producción de nanoemulgeles de aplicación en la industria alimentaria y farmacéutica

Mié, 04/09/2019 - 18:35 | adminUS
Hallan por primera vez en el mundo un ejemplar de delfín híbrido en alta mar
Investigadores de la Universidad de Sevilla han identificado un híbrido entre delfín mular y delfín común en la Bahía de Algeciras
Mié, 04/09/2019 - 18:32 | adminUS
El papel de la Santa Sede en la Guerra Civil
El libro 'La Santa Sede y la Guerra Civil, los representantes del Papa en la España en conflicto (1936-1938) destapa el papel de la Iglesia durante la Guerra Civil

Vie, 23/08/2019 - 11:58 | adminUS
Conservar especies raras para el mantenimiento de los bosques mediterráneos
Expertos del Departamento de Biología Vegetal han centrado su investigación en los pinares del suroeste de la Península Ibérica. Este trabajo mejorará los planes de conservación futuros para los pinares mediterráneos

Mar, 20/08/2019 - 10:23 | adminUS
Aplican criterios de reducción de impacto medioambiental en el Teatro Romano de Itálica
Un estudio de la Universidad de Sevilla plantea que el análisis de ciclo de vida forme parte desde el inicio en la toma de decisiones de proyecto de edificaciones patrimoniales

Jue, 25/07/2019 - 11:44 | adminUS
La investigadora de la US Eleonora Viezzer participa en el Lindau Nobel Laureate Meeting 2019
El Lindau Nobel Laureate Meeting 2019 es un encuentro de premios Nobel en el que participan 600 jóvenes científicos de todo el mundo

Jue, 25/07/2019 - 11:41 | adminUS
Investigadores de la US y el CNA identifican tallas de marfil ilegales
Los investigadores han demostrado la falsedad de los certificados de 10 tallas de marfil

Jue, 25/07/2019 - 11:41 | adminUS
Los escutoides, en el podio de los artículos más leídos en Nature Communications
El artículo ‘Los escutoides son una solución geométrica para el empaquetamiento tridimensional de epitelios’ alcanza la segunda posición de los más leídos en el campo de la Biología

Jue, 25/07/2019 - 11:41 | adminUS
Abierto el plazo para participar en el concurso Tesis en 3 Minutos
La competición, convocada por primera vez en la Universidad de Sevilla, reta a los estudiantes de doctorado a explicar su investigación en solo tres minutos

Jue, 25/07/2019 - 11:41 | adminUS
La iniciativa Farmaescape, reconocida en un congreso sobre innovación educativa
Los profesores Marina Sánchez Hidalgo y Daniel Gutiérrez Praena fueron galardonados por su comunicación ‘El uso de una escape room como recurso docente en la Facultad de Farmacia’

Jue, 25/07/2019 - 11:41 | adminUS
Construcción y lanzamiento al espacio de una mega constelación
Investigadores de la ETS de Ingeniería de la US participan en el proyecto de creación de una constelación de más de 900 satélites en órbita
Jue, 25/07/2019 - 11:41 | adminUS
La revista de investigación en comunicación Ámbitos publica su número 45
Esta edición recoge las investigaciones presentadas en el I Congreso Internacional Comunicación y Filosofía celebrado en el Priego de Córdoba el pasado noviembre

Jue, 25/07/2019 - 11:41 | adminUS
Las actuaciones de mantenimiento en 20 iglesias de la provincia de Sevilla de los últimos ocho siglos
Arquitectos técnicos de la Universidad de Sevilla destacan que las actuaciones que se han realizado históricamente son más de carácter correctivo que preventivo y que en la actualidad su estado de conservación es favorable
Jue, 25/07/2019 - 11:41 | adminUS
Investigadores de la US publican una traducción al español del libro 'A primer on partial least squares structural equation modeling (PLS-SEM) (2nd ed.)'
La obra es una guía práctica y accesible para el uso de PLS-SEM para los investigadores en ciencias sociales

Mar, 02/07/2019 - 12:43 | Anónimo
Analizan las actuaciones de mantenimiento en 20 iglesias de la provincia de Sevilla
Arquitectos técnicos de la Universidad de Sevilla destacan que las actuaciones que se han realizado históricamente son más de carácter correctivo que preventivo y que en la actualidad su estado de conservación es favorable

Vie, 28/06/2019 - 23:03 | adminUS
La Facultad de Comunicación de la US acoge el Congreso ‘Science IES: Jóvenes con Investigadores’
La Facultad de Comunicación de la Universidad de Sevilla ha acogido el Congreso ‘Science IES: Jóvenes con Investigadores’. Un evento que ha reunido a cerca de 400 personas del Proyecto de Iniciación a la Investigación e Innovación en Educación Secundaria en Andalucía (PIIISA): investigadores de la Universidad y del CSIC, profesores de IES, y alumnado de 4º de ESO y 1º de Bachillerato de Sevilla, Huelva, Málaga, Córdoba y Cádiz.

Vie, 28/06/2019 - 22:54 | adminUS
Investigadores de la US estudian los mecanismos celulares de regulación ante la falta de oxígeno
Los resultados de este trabajo permitirán a los investigadores en un futuro evitar muertes por hipoxemia o disminución de la difusión de oxígeno en los tejidos y en la célula. Se trata de uno de los dos únicos proyectos que el Consejo Europeo de Investigación (ERC) ha concedido en Andalucía.

Vie, 28/06/2019 - 22:25 | adminUS
El profesor Pablo García Murillo participa en las labores de restauración del área quemada por el Incendio de Moguer
Se ha unido al Grupo de Trabajo Científico-Técnico para la restauración del área quemada por el Incendio de La Peñuela, en Moguer
Vie, 28/06/2019 - 22:25 | adminUS
El Proyecto Puedes consigue el primer premio en el reto de 'Vida Saludable y Prevención de la Obesidad'
Investigadores de la Universidad de Sevilla han conseguido el primero premio en el reto de 'Vida Saludable y Prevención de la Obesidad' de la convocatoria “Innovation Meets Obesity” del II Congreso de Obesidad y Complicaciones Metabólicas de la Sociedad Española de Cirugía de la Obesidad.
Vie, 28/06/2019 - 22:25 | adminUS
La investigadora Lola Pons hablará este verano sobre el español de ayer y de hoy en el suplemento digital Verne
La primera muestra puede leerse aquí
Vie, 28/06/2019 - 22:25 | adminUS
El profesor Juan Montero participa en el XI Congreso de la Asociación Internacional Siglo de Oro
El catedrático de Literatura Española de la Universidad de Sevilla Juan Montero participará, del 10 al 15 de julio en Madrid, en el XI Congreso de la Asociación Internacional Siglo de Oro.
Vie, 28/06/2019 - 22:25 | adminUS
Un estudio de la US analiza la usurpación de la identidad de personajes famosos en Twitter
El desarrollo de actividades de pretendida autoimagen por parte del parodiado, los ataques a la imagen de los internautas y las amenazas a la imagen de terceros son las estrategias más generalizadas entre los usuarios de estos perfiles.

Vie, 28/06/2019 - 22:25 | adminUS
Nuevos elementos responsables de la inestabilidad de los cromosomas
Investigadores de la Universidad de Sevilla y del Cabimer dan un paso más en la comprensión de la inestabilidad del genoma humano, lo que permitirá identificar elementos que, en un futuro, podrían explorarse como dianas de nuevos fármacos antitumorales.

Vie, 28/06/2019 - 22:25 | adminUS
Premio Sabater 2017 de la Sociedad Española de Fisiología Vegetal
El egresado y doctor en Biología por la Universidad de Sevilla José Manuel Torres Ruiz ha obtenido el Premio Sabater 2017 para jóvenes investigadores que otorga la Sociedad Española de Fisiología Vegetal.
Vie, 28/06/2019 - 22:25 | adminUS
XXVIII Premios de Investigación 'Real Maestranza de Caballería de Sevilla' y 'Real Academia Sevillana de Ciencias'
Los premiados por la Real Maestranza de Caballería de Sevilla han sido Jesús Campos Manzano y María Puerto Rodríguez

Vie, 28/06/2019 - 22:25 | adminUS
El profesor García Arroyo presenta 'Guías Docentes (4): Evaluación en Lenguaje'
La Fundación Centro de Estudios Andaluces financiará un estudio sobre justicia ambiental en el agua y otro sobre la regulación de los contenidos informativos de los medios de comunicación durante los procesos electorales en Andalucía, de los investigadores Belén Pedregal Mateos y Joaquín Pablo Urías Martínez respectivamente.

Vie, 28/06/2019 - 22:25 | adminUS
Cocinar al vapor elimina más cianotoxinas del pescado que el hervido
Las expertas aseguran que hoy día se desconoce la exposición real por consumo de alimentos a estas toxinas, las cuales pueden afectar a diferentes órganos y se pueden transferir al agua utilizada para cocinar.
Vie, 28/06/2019 - 22:25 | adminUS
Emilio Galán, premiado con la Medalla de la Asociación Internacional para el Estudio de las Arcillas
El investigador de la Universidad de Sevilla Emilio Galán Huertos ha sido premiado con la Medalla de la Asociación Internacional para el Estudio de las Arcillas (AIPEA por sus siglas en francés), una distinción establecida "para honrar a científicos activos de la arcilla en el reconocimiento de contribuciones excepcionales a esta ciencia".
Vie, 28/06/2019 - 22:25 | adminUS
Taller sobre Trabajos Fin de Grado Cooperativos e Interdisciplinares
El CRAI Antonio de Ulloa, en el Campus de Reina Mercedes, acoge el próximo 11 de julio el Taller sobre Trabajos Fin de Grado Cooperativos e Interdisciplinares.

Vie, 28/06/2019 - 22:22 | adminUS
La US clausura la octava edición del Programa Campus Científicos de Verano
120 alumnos de Bachillerato y ESO de toda España han participado en las instalaciones de la Universidad de Sevilla de esta iniciativa, organizada por el Campus de Excelencia Internacional Andalucía-TECH.

Vie, 28/06/2019 - 22:22 | adminUS
Steaming fish eliminates more cyanotoxins than boiling it
The experts state that people today do not know the real exposure, via the food we consume, to these toxins, which can affect different organs and which can be transferred to the water used for cooking
Vie, 28/06/2019 - 22:22 | adminUS
Andalusian experts indicate new elements responsible for instability in chromosomes
Researchers from the University of Seville and Cabimer take a step forward in the understanding of the instability of the human genome, which will allow the identification of elements that, in the future, could be explored as targets of new anti-tumour medicines
Vie, 28/06/2019 - 22:22 | adminUS
Acreditaciones en lengua inglesa de los niveles B1 y B2 para el profesorado
Toda la información relativa al procedimiento establecido para poder acceder a estos cursos puede encontrarla AQUÍ

Vie, 28/06/2019 - 22:22 | adminUS
A bioplastic, derived from soya protein, has been obtained, which can absorb up to forty times its own weight
Researchers from the Universities of Seville and Huelva are testing the strength of this new organic material as a dispenser of micronutrients in crops. Also, another advantage of this natural, biodegradable product is that it has almost no environmental impact.

Vie, 28/06/2019 - 22:22 | adminUS
A study by the University of Seville analyses the misappropriation of the identities of famous people on Twitter
The development of supposed self-image on the part of those who are parodied, attacks on the image of internet users and the threats to image by third parties are the most common strategies from users of these profiles.

Vie, 28/06/2019 - 22:22 | adminUS
Expertos de la US mejoran la calidad de las apps de Android en múltiples dispositivos móviles
El investigador José Ángel Galindo ha sido galardonado con el Premio a la Mejor Tesis Doctoral de la Sociedad de Ingeniería de Software y Tecnologías de Desarrollo de Software (SISTEDES), que también ha otorgado al estudiante Álvaro Rojas con el premio al mejor TFG.
Vie, 28/06/2019 - 22:22 | adminUS
Provisión de espacios de las asignaturas de Grado en la plataforma de Enseñanza Virtual (2017-18)
A partir del día 20 de julio de 2017, tendrá disponible el formulario para la provisión de los espacios de las asignaturas de Grado en la plataforma de Enseñanza Virtual para el próximo curso académico 2017-18, pudiendo acceder al mismo a través de la dirección: https://sga2.us.es, estando disponible durante todo el curso académico. Asimismo, dispone de una guía breve sobre el formulario para la solicitud de espacios en Enseñanza Virtual a través del enlace: Guía Breve del Formulario de Provisión de Cursos Enseñanza Virtual.

Vie, 28/06/2019 - 22:22 | adminUS
¿Cuántas vidas salva la Guardia Civil de Tráfico?
Un equipo de investigadores de la Universidad de Sevilla estudia para la Fundación Mapfre el impacto sobre la seguridad vial de las actividades de supervisión y control del cumplimiento de la normativa de tráfico desarrolladas por la Agrupación de Tráfico de la Guardia Civil
Vie, 28/06/2019 - 22:22 | adminUS
José A. Domínguez Machuca, elegido Honorary Fellow 2017 de EurOMA
El profesor de la Universidad de Sevilla José A. Domínguez Machuca ha sido ha sido elegido Honorary Fellow 2017 de la European Operations Management Association (EurOMA). Esta asociación es una red internacional de académicos y profesionales de todo el mundo dedicados al desarrollo de la Gestión de Operaciones.

Vie, 28/06/2019 - 22:22 | adminUS
Descubren cómo funciona el silenciamiento génico en plantas
Este avance científico podría tener aplicaciones biotecnológicas en el futuro ya que las conclusiones se aplican al 80% de las plantas. Este estudio apoya un cambio en el paradigma de una década que estaba llevando a un callejón sin salida a los investigadores de la materia
Vie, 28/06/2019 - 22:22 | adminUS
Un sistema para medir con más precisión la duración de un recorrido a pie en el medio rural
El nuevo método, desarrollado por miembros del Geografía Física y Análisis Geográfico Regional de la Universidad de Sevilla, ofrece un resultado más cercano a las mediciones hechas por caminantes aficionados que las estimaciones que proporcionan los sistemas de cálculo más utilizados hasta la fecha

Vie, 28/06/2019 - 22:22 | adminUS
Tres investigadores de la Facultad de Comunicación, entre los 10 profesores más productivos en investigación en Publicidad
Gracias a tres profesores de la Facultad, la US ocupa la tercera posición entre 20 universidades. Los profesores son: Juan Rey (puesto 1), Manuel Garrido (puesto 5) y Marina Ramos Serrano (puesto 18).
Vie, 28/06/2019 - 22:21 | adminUS
Francisco Sierra, reelegido por unanimidad presidente de ULEPICC
La exposición 'Cien años de medicina: una colección de museo', en la conmemoración de los cien años de los estudios de Medicina en la US, revela el instrumental de laboratorio empleado en la investigación fisiológica del pasado y sorprendentes modelos anatómicos que formaban parte de la investigación y la docencia.

Vie, 28/06/2019 - 22:21 | adminUS
La Noche Europea de los Investigadores toma las calles de Andalucía con más 400 actividades
El evento convocado por la Comisión Europea reunirá a más de 1.500 investigadores en las ocho capitales andaluzas el próximo 29 de septiembre bajo el lema ‘Mujeres y hombres que hacen ciencia para ti’

Vie, 28/06/2019 - 22:18 | adminUS
Alicia Botello en el Centro Gustave Roussy de París
La profesora del Departamento de Enfermería de la Universidad de Sevilla Alicia Botello Hermosa ha pronunciado una conferencia en el Centro Gustave Roussy de Paris, primer centro Europeo de Lucha contra el Cáncer, sobre el plan de estudios en Enfermería de nuestra institución, así como sobre el acceso a los estudios de máster y doctorado.

Vie, 28/06/2019 - 22:18 | adminUS
La Universidad de Sevilla recibe cerca de 60.000 euros para dos proyectos de investigación en Ciencias Sociales
La Fundación Centro de Estudios Andaluces financiará un estudio sobre justicia ambiental en el agua y otro sobre la regulación de los contenidos informativos de los medios de comunicación durante los procesos electorales en Andalucía, de los investigadores Belén Pedregal Mateos y Joaquín Pablo Urías Martínez respectivamente.

Vie, 28/06/2019 - 22:18 | adminUS
Investigadores de la US estudian la relación entre factores que pueden predecir los delitos violentos
“Es necesario mejorar la atención psiquiátrica en nuestros centros penitenciarios y probablemente haya que potenciar la coordinación y la colaboración entre la sanidad pública normalizada y la penitenciaria. Aunque es de justicia decir que se están haciendo esfuerzos”

Vie, 28/06/2019 - 22:18 | adminUS
Obtienen un bioplástico derivado de la proteína de soja capaz de absorber hasta cuarenta veces su peso
Un grupo de investigadores del departamento de Psicología Experimental de la Universidad de Sevilla, en colaboración con la Fundación Pública para la Integración de las Personas con Enfermedad Mental (FAISEM) ha desarrollado un estudio con 472 reclusos en el que han tratado de detectar los principales factores asociados al hecho de estar condenado por cometer un delito violento.

Vie, 28/06/2019 - 22:18 | adminUS
Expertos de la US desarrollan disolventes alternativos más respetuosos con el medio ambiente
En la actualidad, uno de los desafíos de la comunidad científica es la búsqueda de procesos que conduzcan a la implantación de una economía sostenible independiente de las reservas fósiles. En esta línea un grupo de investigadores del Departamento de Química Inorgánica de la Universidad de Sevilla ha desarrollado una serie de nuevas reacciones químicas más respetuosas con el medio ambiente
Vie, 28/06/2019 - 22:18 | adminUS
Expertos andaluces patentan una posible solución a las balsas de fosfoyesos de Huelva
Investigadores de las universidades de Sevilla y Huelva están probando la utilidad de este nuevo material ecológico como dispensador de micronutrientes en cultivos. Además, otra ventaja de este producto biodegradable y de origen natural es su escaso impacto medioambiental.

Vie, 28/06/2019 - 22:18 | adminUS
Expertos de la US estudian uno de los primeros ejemplos de cartografía náutica local en Hispanoamérica
Se trata del mapa de Tlacotalpa del navegante sevillano Francisco Gali, que se hizo en 1580 a petición de la Corona española. Gali fue un destacado navegante, explorador, cosmógrafo y cartógrafo de la época que realizó diversos mapas del nuevo continente siguiendo los cánones de la cartografía europea.
Vie, 28/06/2019 - 22:18 | adminUS
Un estudio identifica iglesias españolas dedicadas a la Virgen de la Asunción y alineadas con la salida del sol
Esta orientación produce bellos efectos de iluminación en los templos estudiados, localizados en Extremadura, Andalucía central y Ciudad Real, territorios que coinciden con el dominio musulmán en España a mediados del siglo XII

Vie, 28/06/2019 - 22:17 | adminUS
Investigadores de la US analizan la influencia del entorno físico en las personas con alzhéimer
El grupo Healthy Architecture & City de la E.T.S. de Arquitectura de la Universidad de Sevilla trata de determinar cuál es el entorno físico más adecuado y personalizado para incrementar la seguridad, accesibilidad y autonomía del paciente con alzhéimer. El jueves 21 de septiembre se celebra el Día Mundial del Alzheimer.
Vie, 28/06/2019 - 22:17 | adminUS
Investigadores de la Universidad de Sevilla editan 'El laberinto mundial de la información. Estructura mediática y poder'
La obra ha sido editada en Barcelona por Anthropos/Siglo XXI México y Argentina y es novedad de otoño 2017

Vie, 28/06/2019 - 22:17 | adminUS
Expertos de la US participan en el primer experimento en Europa de la mayor fuente de rayos X del mundo
La tecnología desarrollada por el profesor de la Universidad de Sevilla Alfonso Gañán será la utilizada para introducir las muestras biológicas ante el haz de rayos X del proyecto XFEL, que se presenta este jueves 14 de septiembre en Hamburgo y cuenta con la participación de expertos de 11 países.

Vie, 28/06/2019 - 22:17 | adminUS
La US y Bayer Cropscience colaboran para acercar la innovación tecnológica al sector agroalimentario
Ambas entidades trabajan juntas para aplicar los últimos avances técnicos en labores como el seguimiento de cultivos mediante sensores remotos embarcados en drones, imágenes satélite y software de análisis para la generación de mapas de variabilidad.

Vie, 28/06/2019 - 22:17 | adminUS
¿Son rentables socialmente las políticas de promoción de la bicicleta en Sevilla?
La Junta de Andalucía ha fijado servicios mínimos con motivo de la convocatoria de huelga del personal docente e investigador laboral con carácter indefinido a partir del lunes 11 de septiembre, quedando garantizado el desarrollo, evaluación y calificación de los exámenes.
Vie, 28/06/2019 - 22:17 | adminUS
El profesor Francisco Liñán se incorpora a Anglia Ruskin University como Professor in Entrepreneurship and Innovation
El profesor de la Universidad de Sevilla Francisco Liñán se ha incorporado a Anglia Ruskin University como Professor in Entrepreneurship and Innovation a tiempo parcial.

Vie, 28/06/2019 - 22:17 | adminUS
I Congreso de Medicina y Ciencias Biomédicas de Sevilla
Tendrá lugar del 23 al 25 de noviembre de 2017

Vie, 28/06/2019 - 22:17 | adminUS
Saint Joseph's University Press publica una extensa selección del 'Arte de la pintura' de Francisco Pacheco
La traducción y estudio preliminar ha sido realizada por el hispanista británico Jeremy Roe, con la colaboración de Carles Gutiérrez Sanfeliu, especialista en historia y literatura del Siglo de Oro español, y José Solís de los Santos, profesor de Filología Clásica de la Universidad de Sevilla

Vie, 28/06/2019 - 22:17 | adminUS
Mapa didáctico-interactivo del Real Alcázar de Sevilla
En este proceso de admisión se buscan personas que quieran formar parte de esta organización de jóvenes comprometidos que trabajan juntos para ofrecerles a otros jóvenes de nuestra área la oportunidad de vivir una experiencia internacional. Este proceso no está enfocado a realizar un programa internacional de voluntariado o prácticas, sino a ser miembros de AIESEC en Sevilla.

Vie, 28/06/2019 - 22:16 | adminUS
Más de medio centenar de actividades llenan Sevilla de ciencia este viernes con la Noche Europea de los Investigadores
Representantes de las diferentes instituciones implicadas en el evento han presentado las actividades que se desarrollarán en la ciudad en la noche del viernes 29 de septiembre.

Vie, 28/06/2019 - 21:43 | adminUS
Tomates de la misma calidad con la mitad de agua de riego
Expertos de la Facultad de Farmacia y de la Escuela Técnica Superior de Ingeniería Agronómica (ETSIA) han publicado un estudio en el que demuestran que reduciendo más del 50% del agua de riego en cultivos de tomates cherry,

Vie, 28/06/2019 - 21:43 | adminUS
Citius Manuel Losada Villasante, centro puntero en investigación biomédica de calidad
La Universidad de Sevilla ha inaugurado su tercer edificio del Centro de Investigación, Tecnología e Innovación (CITIUS), bautizado como Manuel Losada Villasante. Este centro de investigación cuenta con equipos de última generación, como un microscopio multifotón, único en España.

Vie, 28/06/2019 - 20:49 | adminUS
‘Constelaciones 3D’, una serie de vídeos que permiten conocer mejor las estrellas
‘Constelaciones 3D’ permite acercarse a Géminis, Cáncer, Leo, Virgo, Sagitario, la Osa Menor y la Osa Mayor

Vie, 28/06/2019 - 20:31 | adminUS
El profesor Francisco Adame, nombrado vocal del Consejo para la Defensa del Contribuyente
El catedrático de Derecho Financiero y Tributario Francisco Adame ejercerá como vocal en representación del ámbito académico

Vie, 28/06/2019 - 19:27 | adminUS
Los antecedentes neolíticos de la desigualdad de género
Investigadores de la US publican un ambicioso estudio sobre la desigualdad de género en la prehistoria ibérica

Vie, 28/06/2019 - 19:27 | adminUS
Premio al talento investigador de la US
La Real Maestranza y la Academia de Ciencias han reconocido este año a Macarena Ros, María Ramos y Tomás Ramírez con sus premios a investigadores

Vie, 28/06/2019 - 19:27 | adminUS
Herramientas matemáticas para entender el cáncer
El análisis matemático de imágenes tumorales ayuda a entender qué hace que un cáncer pueda ser más o menos agresivo

Vie, 28/06/2019 - 19:27 | adminUS
Curso de formación para participar en el concurso de divulgación 'Tesis en 3 Minutos'
La Universidad de Sevilla convoca por primera vez 'Tesis en 3 Minutos' y ofrece a sus doctorados un curso de formación para participar en el concurso
Vie, 28/06/2019 - 19:27 | adminUS
El profesor Francisco Sierra publica ‘Teoría del valor, comunicación y territorio’
La nueva obra del catedrático de Teoría de la Comunicación Francisco Sierra analiza la teoría del valor y la revolución digital

Vie, 28/06/2019 - 19:27 | adminUS
La profesora María Fernanda Morón de Castro pronuncia una conferencia en la Escuela del Prado
La investigadora habló sobre la autenticidad y originalidad de las obras artísticas en el marco del Seminario Rodrigo Uría Meruéndano de Derecho del Arte

Vie, 28/06/2019 - 19:27 | adminUS
Un proyecto para mejorar la calidad de vida de personas con deficiencias visuales
La reunión de lanzamiento de este proyecto, liderado por la US y enmarcado dentro de las acciones Horizonte 2020, ha reunido a 12 socios de España, Dinamarca, Italia, Grecia y Bulgaria.

Vie, 28/06/2019 - 19:27 | adminUS
El cambio estacional de hora ayuda a la sincronización del ciclo de sueño/vigilia
Un estudio de la Universidad de Sevilla insta a la Comisión Europea a permitir que cada país pueda decidir si mantener o no el cambio de hora

Vie, 28/06/2019 - 19:27 | adminUS
La obra ‘Científicas: pasado, presente y futuro’ recibe el galardón especial de los Premios Luz
El jurado ha destacado la labor divulgativa de la obra y su contribución al fomento de la incorporación de las mujeres a las carreras científicas y técnicas
